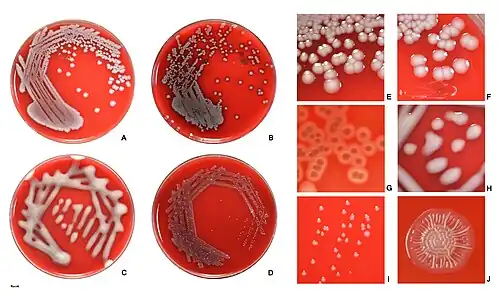
E.coli colonies on agar.

Контаминант


Контамина́нт (от лат. contaminant — примесь) в частном и часто употребляющемся значении s.s. — примесь, инородное вещество (как живое, так и неживое) или смеси инородных веществ в составе используемого в человеческой практике объекта, являющаяся вредной (в случае неживых веществ ядовитой) для человека (часто и для других живых организмов), что делает совмещённый с ней в практике человека объект непригодным для использования,[3] а её попадание (контаминация) в такой объект непреднамеренным и нежелательным событием.[4][5][6][7][8][9][10]
К потенциально контаминируемым объектам относятся: пища, пищевое сырьё, лекарства, лекарственное сырьё, окружающая среда (в том числе здания), микробиологические среды и растворы, культуры и образцы.[4][5][6][10][11][12]
К контаминантам относятся: нежелательные микроорганизмы[5] (бактерии, простейшие[13]), вирусы[13], токсиканты (в том числе токсины — бактериотоксины, фитотоксины (в том числе алкалоиды), микотоксины, зоотоксины; некоторые другие органические вещества — ртутьорганика, карбаматы, полициклические ароматические углеводороды, фосфорорганика, хлорированные углеводороды, нитрозосоединения, фенолы, ароматические амины, анилин и его производные, альдегиды, многие углеводороды ряда метана, некоторые простые эфиры, алкоголь и его суррогаты, азокрасители; некоторые неорганические вещества — оксиды азота; соединения тяжёлых металлов; радионуклиды; боевые отравляющие вещества; лекарства — сердечные гликозиды, трициклические антидепрессанты, антибиотики; наркотики — анальгетики, транквилизаторы, снотворные вещества; бытовые химикалии — некоторые пищевые добавки, средства санитарии, личной гигиены и косметики; средства ухода за одеждой, мебелью, автомобилем и т. д.; большинство синтетических красителей; промышленные яды; сельскохозяйственные яды — пестициды, хлорорганические пестициды, фосфорорганические инсектициды, гербициды (дефолианты, десиканты); крепкие (концентрированные) кислоты и щёлочи и др. вещества; и т. д.)[10].
Вариативность определений термина «контаминант»
Термин «контаминант» в разных отраслях практики человека
Термин контаминант употребляется в основном в микробиологии, в производстве фармацевтической продукции и в производстве пищевых продуктов[14][15][16] в разных значениях.
| Отрасль практики | Контаминация | Контаминант |
|---|---|---|
| Микробиология | Попадание загрязнителей в образец или культуру, обсеменение как засорение (загрязнение) чистой культуры посторонними микроорганизмами.[12] | Любой нежелательный микроорганизм, вещество или смесь веществ, привнесённые в окружающую среду или контролируемые экспериментальные среды и растворы.[5] |
| Фармацевтика | Нежелательное внесение примесей химической или микробиологической природы или инородных веществ в лекарственное сырьё, в ветеринарные препараты во время технологического процесса, отбора проб, упаковки или переупаковки, хранения или транспортировки.[6] | Любые привнесённые посторонние материалы (например, химические, биохимические или микробные), не предусмотренные процессом производства активной фармацевтической субстанции или лекарственного препарата.[11] |
| Производство пищи | Процесс, в результате которого происходит загрязнение пищевых продуктов и сырья контаминантами. | Нежелательный биологический агент (микроорганизмы, включая и вирусы) либо химическое соединение, смесь соединений, обладающие высокой биологической активностью (аллерген, иммуносупрессор, канцероген, мутаген, тератоген, токсин или в общем случае ксенобиотик) либо радиоактивное вещество (радионуклид), присутствие которых в сырьё и пищевых продуктах[13] несвойственно и, несомненно, может оказывать негативное воздействие на организм и, как следствие, нести угрозу для здоровья и жизни человека. |
Сравнение наиболее широких концептов «контаминант» с похожими терминами загрязнитель, токсикант, ксенобиотик
| Характеристика | Загрязнитель=Поллютант
=Контаминант s.l. энергия + вещество |
Контаминант s.s. | Контаминант s.l. вредный +
не вредный |
Токсикант | Ксенобиотик |
|---|---|---|---|---|---|
| Может быть примешанным веществом /смесью веществ | Да | Да | Да | Да | Да |
| Может быть вредной энергией | Да | - | - | - | - |
| Может быть живым веществом | Да | Да | Да | - | - |
| Может быть неживым веществом | Да | Да | Да | Да | Да |
| Может быть токсичным | Да | Да | Да | Да | Да |
| Может быть безвредным | - | - | Да | - | Да |
| Может быть чужеродным для организма веществом | Да | Да | Да | Да | Да |
| Может быть родным для организма веществом | Да | Да | Да | Да | - |
Различие концептов и терминов загрязнитель, токсикант, ксенобиотик
Отличие загрязнителя и контаминанта
Контаминант s.s. — гипоним (в широком смысле s.l. с включением в определение энергии и синоним[3]) таких вредных для организмов факторов как поллютанты (загрязняющие агенты, включающие помимо вредных веществ и вредную энергию).
Отличие токсиканта и контаминанта
Контаминант s.s. — гипероним неживых токсичных для организмов веществ — токсикантов (веществ-загрязнителей).[10]
Отличие ксенобиотика и контаминанта
Контаминант в узком смысле s.s. и упомянутом широком смысле s.l. с включением в определение энергии — частичный синоним ксенобиотика, поскольку означает любой загрязняющий агент продуктов питания (не обязательно чужеродный) и (в случае ещё более узкого, чем контаминант s.s. определения) попадает в организм исключительно алиментарным путём (то есть с пищей), а ксенобиотик означает любое чужеродное вещество, способное попасть в организм человека как алиментарным путём, так и, например, воздушным (респираторным), сублингвальным (подъязычным) или через кожу (трансдермально).
Контаминант в редко употребляемом втором широком смысле s.l. как контаминант s.s. с дополнительным охватом не вредных веществ является гиперонимом ксенобиотика, поскольку включает, как и ксенобиотик, безвредные, вредные вещества, чужеродные вещества, но, в отличие от ксенобиотика, и родные для организма вещества.
Отличие концептов контаминанта
2 значения контаминанта s.l. являются частичными синонимами друг относительно друга (одно определение включает невредные вещества, другое — нет), гиперонимами по отношению к контаминанту s.s. .
Сходство концептов контаминанта и терминов загрязнитель, токсикант, ксенобиотик
Общий смысл для контаминанта (оба s.l. и s.s.), а также токсиканта, загрязнителя, ксенобиотика — примешанное токсичное чужеродное неживое вещество, то есть такое вещество можно назвать любым из этих терминов.[4][5][6][7][8][9][10]
Биологические контаминанты


Биологические, также природные или естественные контаминанты — нежелательные микроорганизмы (вирусы, патогенные и условно-патогенные бактерии, микроскопические грибы, простейшие, споры микромицетов итд.), а также их продукты метаболизма (например, ботулотоксин, продуцируемый Clostridium botulinum или охратоксины — группа микотоксинов, вырабатываемые некоторыми видами микроскопических плесневых грибов рода Аспергилл и Пеницилл), присутствующие в пищевых продуктах. Большое количество биологических контаминантов приходится на бактерии и их метаболитов (токсинов, антибиотиков). К этой группе можно отнести токсины морских животных, употребляемых в пищу (например, тетродотоксин из собаки-рыбы или фугу), а также токсины растений или фитотоксины (например, рицин, из ядер клещевины или амигдалин из косточек горького миндаля, абрикоса — ядовитый гликозид) и грибов (аматоксины, фаллотоксины и др.).
- Некоторые биологические контаминанты
 Дезоксиниваленол или вомитоксин (от англ. Vomiting — рвота), наиболее распространённый трихотецен, продуцируется микроскопическими плесневыми грибами рода Fusarium (Fusarium culmorum, Fusarium graminearum). Высокотоксичен, обладает иммуносупрессивным эффектом, вызывает сильнейшее отравление сопровождаемое упорной рвотой, поражением ЖКТ и агранулоцитозом[17][18]
Дезоксиниваленол или вомитоксин (от англ. Vomiting — рвота), наиболее распространённый трихотецен, продуцируется микроскопическими плесневыми грибами рода Fusarium (Fusarium culmorum, Fusarium graminearum). Высокотоксичен, обладает иммуносупрессивным эффектом, вызывает сильнейшее отравление сопровождаемое упорной рвотой, поражением ЖКТ и агранулоцитозом[17][18]-Aflatoxin_B1_Structural_Formulae_V.1.svg.png) Афлатоксин B1 — один из представителей афлатоксинов, смертельно опасный токсин, а также сильнейший гепатоканцероген[19]. Продуцируется микроскопическими плесневыми грибами рода Аспергилл (Aspergillus flavus, Aspergillus parasiticus)
Афлатоксин B1 — один из представителей афлатоксинов, смертельно опасный токсин, а также сильнейший гепатоканцероген[19]. Продуцируется микроскопическими плесневыми грибами рода Аспергилл (Aspergillus flavus, Aspergillus parasiticus) Соланин — стероидный гликозид, фитотоксин вырабатываемый некоторыми видами растений семейства паслёновых или Solanaceae (ягоды чёрного паслёна, клубни картофеля итд.)[20]
Соланин — стероидный гликозид, фитотоксин вырабатываемый некоторыми видами растений семейства паслёновых или Solanaceae (ягоды чёрного паслёна, клубни картофеля итд.)[20].png) Модель вируса SARS-CoV-2, одного из представителей семейства коронавирусов. Данный вирус высококонтагиозный и может контаминировать воду и пищевые продукты, тем самым увеличивается риск распространения коронавирусной инфекции (COVID-19)[21]
Модель вируса SARS-CoV-2, одного из представителей семейства коронавирусов. Данный вирус высококонтагиозный и может контаминировать воду и пищевые продукты, тем самым увеличивается риск распространения коронавирусной инфекции (COVID-19)[21] Сигуатоксин 1В — полициклический полиэфир, очень ядовит, продуцируется некоторыми видами динофлагеллятов (Gambierdiscus toxicus). Вместе с планктоном поедается токсин, который накапливается в жировой ткани, внутренностях и коже многих видов морских рыб, тем самым он представляет огромную опасность. Интоксикация сигуатоксином проявляется в виде сигуатеры[22]
Сигуатоксин 1В — полициклический полиэфир, очень ядовит, продуцируется некоторыми видами динофлагеллятов (Gambierdiscus toxicus). Вместе с планктоном поедается токсин, который накапливается в жировой ткани, внутренностях и коже многих видов морских рыб, тем самым он представляет огромную опасность. Интоксикация сигуатоксином проявляется в виде сигуатеры[22] Сакситоксин (STX), накапливается в съедобных морских моллюсках (мидии, морское ушко, устрицы, итд.), которые в свою очередь питаются продуцентами — динофлагеллятами (Gonyaulax catenella, Alexandrium sp., Gymnodinium sp., Pyrodinium sp.) и цианобактериями (Anabaena sp., Aphanizomenon spp., Cylindrospermopsis sp., Lyngbya sp., Planktothrix sp.). Сильнейший яд небелковой природы с ярко выраженным нервно-паралитическим воздейстием, ЛД50 ~5,7 мкг/кг перорально для человека (так, одна мелкая мидия может содержать сакситоксин в дозе, достаточной чтобы убить 50 человек[23]). Селективный блокатор потенциал-зависимых натриевых каналов[24] (сходный по действию с тетродотоксином), тем самым поражает ЦНС
Сакситоксин (STX), накапливается в съедобных морских моллюсках (мидии, морское ушко, устрицы, итд.), которые в свою очередь питаются продуцентами — динофлагеллятами (Gonyaulax catenella, Alexandrium sp., Gymnodinium sp., Pyrodinium sp.) и цианобактериями (Anabaena sp., Aphanizomenon spp., Cylindrospermopsis sp., Lyngbya sp., Planktothrix sp.). Сильнейший яд небелковой природы с ярко выраженным нервно-паралитическим воздейстием, ЛД50 ~5,7 мкг/кг перорально для человека (так, одна мелкая мидия может содержать сакситоксин в дозе, достаточной чтобы убить 50 человек[23]). Селективный блокатор потенциал-зависимых натриевых каналов[24] (сходный по действию с тетродотоксином), тем самым поражает ЦНС Структура конваллятоксина, гликозида, который встречается во всех частях майского ландыша (Convallaria majаlis), но особенно его много в ягодах. Обладает сильнейшим кардиотоксическим воздействием (ингибирует Na+/K+-АТФазу), даже в небольших количествах (2-3 мг) может вызывать фибрилляцию желудочков[25][26][27], повышение давления и остановку сердца, однако, в очень низких концентрациях — терапевтических дозах (0,3 мг/мл) применяется для лечения пароксизмальной тахикардии
Структура конваллятоксина, гликозида, который встречается во всех частях майского ландыша (Convallaria majаlis), но особенно его много в ягодах. Обладает сильнейшим кардиотоксическим воздействием (ингибирует Na+/K+-АТФазу), даже в небольших количествах (2-3 мг) может вызывать фибрилляцию желудочков[25][26][27], повышение давления и остановку сердца, однако, в очень низких концентрациях — терапевтических дозах (0,3 мг/мл) применяется для лечения пароксизмальной тахикардии Аманин — один из представителей аматоксинов, встречается в плодовых телах грибов рода Аманита (Мухомор), Лепиота и Галерина, чрезвычайно токсичен и смертельно опасен, сильнейший гепатотоксин, вызывает лизис и некрозы клеток паренхимы печени, помимо этого он разрушает клетки кишечника и почек (вызывает острую почечную недостаточность)[28]
Аманин — один из представителей аматоксинов, встречается в плодовых телах грибов рода Аманита (Мухомор), Лепиота и Галерина, чрезвычайно токсичен и смертельно опасен, сильнейший гепатотоксин, вызывает лизис и некрозы клеток паренхимы печени, помимо этого он разрушает клетки кишечника и почек (вызывает острую почечную недостаточность)[28]_PDB_1r4q.png) Веротоксин или Шига-подобный токсин (SLT-II) — токсин Коли, вызывает сильнейшее пищевое отравление, сопровождаемое геморрагической лихорадкой, повреждением сосудов внутренних органов, гемолитической анемией. Продуцируется некоторыми штаммами E. coli и Shigella
Веротоксин или Шига-подобный токсин (SLT-II) — токсин Коли, вызывает сильнейшее пищевое отравление, сопровождаемое геморрагической лихорадкой, повреждением сосудов внутренних органов, гемолитической анемией. Продуцируется некоторыми штаммами E. coli и Shigella
Бактериальные токсины
Бактериальные токсины загрязняют пищевые продукты и являются причиной острых пищевых интоксикаций. Рассмотрим наиболее часто регистрируемые интоксикации, связанные с поражением пищевых продуктов некоторыми бактериальными токсинами.
Энтеротоксины S.aureus

Staphylococcus aureus — грамположительные бактерии, сферической формы, которые являются причиной стафилококкового пищевого отравления. Продуцируют следующие энтеротоксины: А, В, С1, С2, D, E, которые представляют собой полипептиды с молекулярной массой 26 360-28 500 дальтон. Энтеротоксины S. aureus термостабильны и инактивируются лишь после 2-3-часового кипячения. Бактерицидным действием по отношению к стафилококкам обладают уксусная, лимонная, фосфорная, молочная кислоты при рН до 4,5. Кроме того, жизнедеятельность бактерий прекращается при концентрации соли (NaCl) — 12 %, сахара — 60-70 %, вакуумная упаковка также ингибирует рост бактерий. Всё это необходимо учитывать в различных технологиях консервирования, как в промышленном масштабе, так и в домашних условиях.
Наиболее благоприятной средой для роста и развития стафилококков являются молоко, мясо и продукты их переработки, а также кондитерские кремовые изделия, в которых концентрация сахара составляет менее 50 %. Стафилококковые энтеротоксины являются причиной 27-45 % всех пищевых токсикоинфекций.
Стафилококковые гастроэнтериты вызываются при приёме внутрь пищи, содержащей один или несколько энтеротоксинов, выделяемых некоторыми видами и штаммами стафилококков[29]. Хотя и считается, что выделение энтеротоксинов обычно связано со штаммами S. aureus, продуцирующих коагулазу и термонуклеазу, многие штаммы, не продуцирующие ни коагулазу, ни термонуклеазу, тем не менее выделяют энтеротоксины.
Симптомы стафилококкового пищевого отравления обычно развиваются в течение четырёх часов после приёма внутрь заражённых пищевых продуктов, хотя этот интервал, по разным сообщениям, может различаться в пределах от одного до шести часов[30]. Среди симптомов обычно отмечаются такие, как тошнота, рвота, спазмы живота (которые, как правило, бывают очень сильными), диарея, выпотевание, головная боль, упадок сил, истощение, иногда снижение температуры тела — которые обычно продолжаются от 24 до 48 ч. Смертельные исходы достаточно редки или полностью отсутствуют. Как правило, для здоровых людей лечение ограничивается постельным режимом и поддержанием баланса жидкости в организме. После прекращения симптомов у переболевших не сохраняется выраженного иммунитета к повторным заражениям, хотя при неоднократном пероральном введении доз у животных появляется устойчивость к энтеротоксину[31]. Поскольку симптомы были вызваны приёмом внутрь уже сформированного энтеротоксина, понятно, что культуры из фекальных масс не содержат стафилококков, хотя это и случается редко.
Токсины C.perfringens
Clostridium perfringens (ранее известная как C. welchii или Bacillus welchii) представляет собой грамположительную, палочковидную, облигатно (строго) анаэробную, спорообразующую патогенную бактерию рода Клостридиум[32][33]. Является одним из возбудителей газовой гангрены и клостридиальной кишечной токсоинфекции.
Штаммы Clostridium perfringens, вызывающие пищевые отравления, обнаруживаются в почве, воде, пыли, продуктах питания, пряностях и в пищеварительных трактах человека и животных. Многие исследователи сообщали, что распространённость термоустойчивых, негемолитических штаммов в общей популяции оценивается в пределах от 2 до 6 %. В экскрементах от 20 до 30 % здорового персонала больниц и членов их семей были обнаружены эти организмы, а среди заболевших процент носителей этих токсигенных клостридий через две недели равнялся 50 %, а иногда достигал и 88 %. Термочувствительные штаммы являются обычными представителями микрофлоры желудочно-кишечного тракта у всех людей. Бактерии C. perfringens попадают в мясо либо непосредственно после забоя животных, либо в результате последующего заражения мяса животных руками людей или пылью. Поскольку клостридии являются спорообразующими бактериями, они могут противостоять неблагоприятным условиям среды, высушиванию, нагреванию и воздействию различных токсических веществ.

Энтеротоксин является фактором, определяющим пищевые отравления при попадании бактерий C.perfringens в организмы человека и животных. Он имеет молекулярную массу 35,3 кДа и отвечает за распад плотных контактов, образованных между эпителиальными клетками в кишечнике[34]. Необычным является то, что этот белок является споро-специфическим; его выделение происходит параллельно с процессом споруляции. Причиной всех известных случаев пищевых отравлений, вызванных этим видом бактерий, были штаммы, относящиеся к типу A. Другое заболевание, некротический энтерит, вызывается бета-токсином, производимым штаммами типа С. Это заболевание характерно для Новой Гвинеи, и весьма редки сообщения о таком отравлении за её пределами. Несмотря на то что некротический энтерит, вызываемый клостридиями типа С, связан с уровнем смертности в 35-40 %, пищевые отравления, вызываемые клостридиями типа A, являются фатальными только для пожилых и ослабленных людей. Показано, что некоторые штаммы клостридий типа С продуцируют энтеротоксин, но его значение и роль в заболеваниях пока не ясны.
Ботулинистические токсины

В отличие от отравления пищей, содержащей бактерии C. perfringens, при котором большое количество жизнеспособных клеток должны попасть в желудочно-кишечный тракт, симптомы ботулизма вызываются попаданием в организм чрезвычайно токсичного, растворимого энтеротоксина — ботулинистического, продуцируемого бактериями, растущими в продуктах питания.
Ботулизм вызывается некоторыми штаммами бактерий C. botulinum, которые являются грамположительными анаэробными спорообразующими палочками, имеющими форму от овальной до цилиндрической, со спорами, расположенными на конце или почти на конце палочковидной клетки. На основании серологической спецификации их токсинов определены семь типов: A, B, C, D, E, F и G[35][36]. Токсины A, B, E, F и G вызывают заболевания у человека; тип С вызывает ботулизм у домашней птицы и дичи, рогатого скота, норки и других животных; тип D связан с отравлением скота фуражом, в особенности в Южной Африке. Дифференциация типов штаммов осуществляется также на основании их протеолитической активности. Типы A и G являются протеолитическими, также как и некоторые из штаммов, принадлежащих к типам B и F. Тип E непротеолитический, так же как и некоторые из штаммов, принадлежащих к типам B и F. Протеолитическая активность штаммов типа G слабее, чем у штаммов типа A, и для действия их токсина необходимо участие трипсина. Все штаммы, продуцирующие токсин типа G, объединены внутри вида C. argentinense. Штаммы этого вида были выделены из почв Аргентины, Швейцарии и США.
Ботулотоксины, образующиеся в бактериях С.botulinum, высвобождаются в результате аутолиза. Они продуцируются клетками, растущими в оптимальных условиях, хотя были сообщения о том, что покоящиеся клетки также образуют токсины. Ботулотоксины являются наиболее токсичными из всех известных природных ядов нервно-паралитического действия. Летальные дозы некоторых типов достигают нескольких десятков пикограмм на килограмм живого веса.
Токсины Сальмонелл и Шигелл
_PDB_1r4q.png)
Сальмонеллы являются грамотрицательными, неспорообразующими палочковидными бактериями[37], которые практически ничем не отличаются внешне от кишечной палочки под микроскопом или при выращивании на обычных питательных средах. Эти бактерии широко распространены в природе. При этом человек и животные являются их главными резервуарами. Основным механизмом пищевых отравлений сальмонеллами является заглатывание пищевых продуктов, содержащих патогенные штаммы этого рода бактерий в значительных количествах.
Сальмонеллы в воде открытых водоёмов, в почве и в комнатной пыли сохраняются до 3 месяцев. Они хорошо переносят низкие температуры, способны размножаться при температуре 40 °С. В колбасных изделиях сохраняются до 6 месяцев, в замороженном мясе и яйцах — до 1 года, на овощах и фруктах — 5-10 дней, в молоке — до 20 дней, в сливочном масле — до 120 дней, на яичной скорлупе — до 24 дней. В молоке и мясе даже при низкой положительной температуре сальмонеллы способны размножаться. Соление и копчение продуктов оказывает на сальмонеллы слабое действие. При нагревании до 56 °С сальмонеллы погибают через 45-60 минут, при температуре 70 °С они погибают через 5-10 минут, при кипячении — мгновенно. Уф-излучение губительно для этих бактерий. Растворы дезинфицирующих веществ (5 % фенол, 3 % хлорамин, 3 % лизол, этиловый спирт) убивают сальмонеллы в течение 2-3 минут. К большинству антибиотиков сальмонеллы чувствительные. Однако в настоящее время отмечается неуклонный рост штаммов, обладающих резистентностью к антибиотикам.
Сальмонеллы разных видов и подвидов обладают разным набором токсинов. Эндотоксин выделяется при разрушении бактериальной клетки. Он вызывает развитие лихорадки в случае бактериемии, вызванной сальмонеллами. Некоторые сальмонеллы, особенно сальмонеллы животного происхождения, образуют белковые термостабильный и термолабильный энтеротоксины, которые схожи с холерным энтеротоксином и LТ-токсином энтеротоксигенных кишечных палочек. Цитотоксины (шига-подобные токсины) угнетают синтез белка на рибосомах энтероцитов.

Разные серовары сальмонелл обладают свойственным только им набором факторов патогенности, что обусловливает различия в клинической картине вызываемых заболеваний. В зависимости от источника инфекции, путей передачи возбудителя, особенностей патогенеза и форм проявления инфекционного процесса выделяют следующие нозологические формы сальмонеллёзной этиологии:
- брюшной тиф;
- паратифы А, В и С;
- сальмонеллёзы, возбудителями которых являются сальмонеллы животного происхождения;
- госпитальный (нозокомиальный) сальмонеллёз.
Шигеллы
Род Shigella принадлежит к семейству энтеробактерий Enterobacteriaceae так же, как Salmonella и Escherichia. В этом роду определены только четыре вида: S.dysenteriae, S.flexneri, S.boydii и S.sonnei. Среди них S.dysenteriae является основным патогеном, вызывающим бациллярную форму дизентерии. Шигеллы представляют собой прямые палочки с закруглёнными концами размером 0,5-0,7 × 2-3 мкм. Шигеллы грамотрицательные — окрашиваются в красный цвет при использовании метода Грама. Неподвижные (отсутствуют жгутики). Имеют пили. Спор и капсул не образуют. Могут формировать микрокапсулу. Они являются факультативными анаэробами.
Благоприятной средой для шигелл являются пищевые продукты. На фруктах и овощах шигеллы выживают до 2 недель. Наиболее устойчивыми к воздействию неблагоприятных факторов являются клетки S. sonnei. Они выживают в воде до 2 месяцев, а в почве — до 3 месяцев. В молоке и молочных продуктах S. sonnei способна не только длительно выживать, но и размножаться. Дезинфицирующие средства (гипохлориты, хлорамин, лизол и др.) в обычных концентрациях обладают бактерицидным действием. К большинству антибиотиков шигеллы чувствительны. Однако шигеллы способны приобретать R-плазмиды от других энтеробактерий и становиться устойчивыми к антимикробным препаратам. У отдельных штаммов шигелл формируется при этом множественная лекарственная устойчивость. Такие возбудители дизентерии вызывают крупные вспышки с тяжёлым течением болезни. Установлено, что для возникновения инфекции у чувствительных индивидуумов достаточно попадания в организм всего лишь 10 КОЕ.
Токсины шигелл
Шигеллы продуцируют разнообразные токсины, которые являются факторами вирулентности и способствуют процессам защиты и инвазии бактерий.
Эндотоксин шигелл представляет собой липополисахарид клеточной стенки (LPC). Он выделяется при разрушении микробных клеток, обусловливает развитие интоксикационного синдрома. В свою очередь, ЛПС защищает бактерии от действия кислой среды желудка и жёлчи. Экзотоксины шигелл представлены цитотоксином (Шига-токсина и шига-подобным токсином) и энтеротоксинами.
Цитотоксин повреждает мембраны эпителиальных клеток кишечника. S. dysenteriae серовара 1 продуцирует белковый Шига-токсин (SLT-I), остальные шигеллы продуцируют шига-подобные токсины (SLT-II). Шига-токсин кодируется хромосомным геном stx. Эти токсины состоят из субъединиц А и В. Субъединица В вначале связывается с гликолипидом Gb3 мембраны клетки, а затем субъединица А проникает внутрь клетки и блокирует синтез белка на рибосомах (цитотоксическое действие). Шига-токсин попадает в кровь и оказывает энтеротоксическое, нейротоксическое и нефротоксическое действие, что проявляется нарушением водно-солевого обмена, деятельности ЦНС, гибелью эпителиальных клеток толстого кишечника и поражением почечных канальцев.
Энтеротоксины ShET-1 и ShET-2 усиливают секрецию жидкости и солей в просвет кишечника, обусловливая диарею. Синтез токсина ShET-1 кодируется хромосомными генами. Его продуцирует только S. flexneri серотипа 2а. Синтез токсина ShET-2 и инвазинов кодируют плазмидные гены.
Токсины Иерсиний

Иерсинии относятся семейству Yersiniaceae, роду Yersinia. Название рода происходит от фамилии А. Йерсена, который совместно с Ш. Китазато открыл возбудителя чумы. Род Yersinia включает 18 видов. Медицинское значение имеют 3 вида: Y. pestis (возбудитель чумы), Y. pseudotuberculosis (возбудитель псевдотуберкулёза) и Y. enterocolitica (возбудитель кишечного иерсиниоза). Y. pseudotuberculosis и Y. enterocolitica относятся к энтеропатогенным иерсиниям. Одной из особенностей иерсиний является психрофильность — способность бактерий размножаться при температуре 4-8 °С.
Бактерии Yersinia enterocolitica вырабатывают термостабильный энтеротоксин (ST), который может выдерживать температуру 100 °С в течение 20 мин, оставаясь активным. Он не подвергается воздействию протеаз и липаз и обладает молекулярной массой, равной 9000-9700 дальтон. Токсин теряет биологическую активность при обработке 2-меркаптоэтанолом. ST Yersinia enterocolitica растворим в метаноле и стимулирует гуанилатциклазу и циклический аденозинмонофосфат (цАМФ) в кишечнике, но в то же время не стимулирует аденилатциклазу. Токсин ST продуцируется при температуре, равной или ниже 30 °С, и его продукции способствуют рН в пределах от 7 до 8. Из 46 изолятов, выделенных из молока, только 3 продуцировали термостабильный токсин (ST) в молоке при 25 °С, в то время как при 4 °С выделения ST не отмечалось.
Что же касается продукции термостабильного энтеротоксина (ST) другими видами иерсиний, отличающихся от Yersinia enterocolitica, то ни один из 21, 8 и 1 штаммов соответственно Yersinia intermedia, Yersinia frederiksenii и Yersinia aldovae не показывали соответствующей положительной реакции в одном из исследований образцов сырого молока, в то время как 62,5 % изолятов Yersinia enterocolitica были положительными по термостабильному энтеротоксину. С другой стороны, в двух других исследованиях было показано, что около одной трети видов иерсиний, не относящихся к Yersinia enterocolitica, включая Yersinia intermedia и Yersinia kristensenii, были положительными по термоста-бильному энтеротоксину (ST). Бактерии Yersinia bercovieri продуцируют собственный термостабильный энтеротоксин (YbST). Хорошо определяемый уровень продуцирования этого энтеротоксина регистрируется в условиях культивирования при 4 °С в течение периода 144—168 часов.
Эшерихиальные токсины
Эшерихии относятся к семейству энтеробактерий Enterobacteriaceae роду Escherichia. Основным видом рода Escherichia, имеющим санитарно-гигиеническое значение, является Escherichia coli (кишечная палочка). По антигенным свойствам эшерихии подразделяются на серогруппы. Эшерихии были выделены в 1885 г. немецким педиатром, профессором клиники детских болезней Т. Эшерихом из кала ребёнка, больного «детской холерой». Первоначально название кишечной палочки — Bacterium coli communis.
Эшерихии представляют собой неспорообразующие полиморфные прямые или слегка изогнутые грамотрицательные палочки[38] с закруглёнными концами средних размеров (длина 2-6 мкм и ширина 0,4-0,6 мкм). Палочки располагаются одиночно, реже — попарно. Клетки E. coli имеют пили (фимбрии) и обладают подвижностью благодаря перитрихиально расположенным жгутикам[39]. По отношению к кислороду это факультативные анаэробы. Эшерхии имеют как непатогенные (резидентные, часть естественного микробиома кишечника человека), так и условно-патогенные и патогенные штаммы, попадаемые в организм человека извне с пищевыми продуктами, которые могут вызывать разнообразные заболевания эшерихиозы, которые затрагивают органы ЖКТ (массовые кишечные отравления, гастроэнтериты, болезнь Крона итд.), крови (гемолитическую анемию, сепсис), урогенитальной системы. Источником инфекции при эшерихиозе является больной человек или бактерионоситель, хотя здоровое носительство выявляется редко — в 2-3 % случаев. В некоторых случаях источником инфекции является крупный рогатый скот и овцы (при инфицировании энтерогеморрагическими эшерихиями). Механизм передачи инфекции — фекально-оральный. Пути передачи — водный, алиментарный (пищевой), бытовой. По данным ВОЗ, заражение энтеротоксигенными и энтероинвазивными эшерихиями чаще происходит пищевым путём, а энтеропатогенными эшерихиями — контактно-бытовым путём. Нередко заболевания связаны с инфицированным молоком и молочными продуктами. Заболевания, вызванные патогенными эшерихиями, чаще всего встречается у путешественников (так называемая диарея путешественников), посещающих страны с жарким климатом. Предполагается, что распространению инфекций способствует загрязнение объектов внешней среды сточными водами, нарушение санитарно-гигиенических условий, контаминация эшерихиями продуктов питания (мясных, молочных и овощных продуктов). По данным ВОЗ, эшерихиозы занимают первое место среди диарейных заболеваний у новорождённых и детей раннего возраста.
Патогенные штаммы E. coli.

На основании симптомов заболеваний, их характеристик, а также воздействия определённых клеточных культур и их принадлежности к серологическим группам, распознаются следующие вирулентные группы Escherichia coli:
- энтероагрегативная (EAggEC),
- энтерогеморрагическая (EHEC),
- энтероинвазивная (EIEC),
- энтеропатогенная (EPEC),
- энтеротоксигенная (ETEC),
- диффузно-адгерентная, диффузно-агрегативная или диффузно-агрегирующая (DAEC).
Передача патогенных штаммов E. coli происходит в основном фекально-оральным путём[40], например, при контаминации ими пищевых продуктов или воды и, последующим их употреблением, а также не соблюдении правил гигиены и санитарно-гигиенических правил и норм мест общественного питания.
Энтероагрегативная E. coli (EAggEC)
Эта группа (обозначаемая также как энтероадгерентная) тесно связана с энтеропатогенной (EPEC) группой E. coli, но агрегативная адгерентность, проявляемая этими штаммами, характерна только для них. Некоторые штаммы, относящиеся к EAggEC, продуцируют термостабильный энтеротоксин (ST), получивший обозначение EAST1. Ген плазмидного происхождения, названный astA, кодирует состоящую из 38 аминокислотных остатков белковую молекулу, в отличие от гена estA, кодирующего энтеротоксин STa, состоящего из 72 аминокислотных остатков. Бактерии EAggEC-штаммов продуцируют также энтеротоксин/цитотоксин, имеющий молекулярную массу 108 кДа, гены которого локализованы в большой плазмиде вирулентности. Отличительными клиническими признаками бактерий EAggEC-штаммов являются неослабевающая диарея, длящаяся более 14 дней, в особенности у детей. Эти штаммы не являются первичной причиной диареи путешественников.
До сих пор неясно, являются ли члены этой группы пищевыми патогенами.
Энтерогеморрагическая E. coli (EHEC)
Эти штаммы с одной стороны напоминают, а с другой стороны отличаются от EPEC-штаммов. Схожесть с EPEC-штаммами определяется тем, что они обладают хромосомным геном eaeA (или аналогичным ему геном), а также в том, что они вызывают повреждения типа прикрепление-сглаживание. В отличие от EPEC-штаммов EHEC-бактерии воздействуют только на толстый кишечник (у модели поросят) и выделяют в больших количествах токсин, аналогичный шига-токсину (SLT, Stx, подробнее описан ниже). Бактерии EHEC обладают плазмидой весом 60 МДа, которая кодирует фимбрии, опосредующие прикрепление к культуре клеток. Эти бактерии не способны внедряться в клетки, относящиеся к линиям Hep-2 или INT407, однако некоторые штаммы обладают способностью проникать в клетки некоторых линий эпителия человека. Некоторые из штаммов EHEC образуют сильно скрученные фимбрии, которые осуществляют прикрепление клеток бактерий к поверхностям.
Токсины
_from_Escherichia_coli_O157-H7_PDB_1r4p.png)
Токсины, продуцируемые бактериями E. coli, относящихся к EHEC-штаммам, называют шига-подобными токсинами (веротоксин, вероцитотоксин). Сюда же относят два таких токсина-прототипа, как SLT-I и SLT-II. В последнее время, однако, используется новая терминология, и то, что раньше называли SLT-I, теперь называют Stx1, а SLT-II теперь носит название Stx2.
Все токсины Stx состоят из одной ферментативно активной субъединицы А (32 кДа) и нескольких субъединиц В (7,7 кДа)[41][42]. Чувствительные к этим токсинам клетки обладают рецептором глоботриаозилцерамида (Gb3), и кроме того, бутират натрия, по-видимому, также играет роль при сенситизации клеток к Stx токсинам. Как только токсины оказываются связанными с рецептором Gb3, далее следует интернализация (посредством экзоцитоза) и транспорт по каналам сети аппарата Гольджи. После того, как токсин оказывается внутри клетки-хозяина, субъединица А связывается с 28S-рРНК, входящей в состав 60S-субъединицы рибосом, освобождая при этом аминокислотный остаток аденина и, таким образом, ингибируя синтез белка[43]. В-субъединицы образуют пентамеры в ассоциации с одной субъединицей А (AB5), и, таким образом, они являются ответственными за связывание токсина с нейтральными гликолипидными рецепторами.
Энтероинвазивные E. coli (EIEC)
Эти штаммы обычно не продуцируют энтеротоксины, как это характерно для штаммов ETEC, но, тем не менее, эти бактерии проникают в клетки эпителия толстого кишечника и затем распределяются по непосредственно примыкающим клеткам тем же способом, что и шигеллы.
Энтеропатогенные E. coli (EPEC)
Эти штаммы, как правило, не продуцируют энтеротоксинов, хотя они могут вызывать диарею. Бактерии данных штаммов способны прикрепляться к клеткам культуры ткани и способны к агглютинации в средах для выращивания культуры тканей. Они обладают плазмидами, кодирующими факторы адгезивности, что позволяет им прикрепляться к мукозному слою кишечника. После колонизации мукозного слоя кишечника происходят его деградативные изменения, обозначаемые термином «прикрепления-разрушения» («attachment-effacement», сокр. A/E).
Энтеротоксигенные E. coli (ETEC)
Бактерии этих штаммов прикрепляются к стенкам тонкого кишечника и колонизируют его при помощи находящихся на фимбриях антигенных факторов колонизации (CFA). Существует 4 типа факторов колонизации — I, II, III и IV. Все они были клонированы и секвенированы. CFA кодируются плазмидами и, главным образом, той же плазмидой, которая кодирует термостабильный энтеротоксин. Эти факторы не выделяются при температуре ниже 20 °С. Будучи уже прикреплёнными, эти бактерии продуцируют один или сразу два энтеротоксина.
Энтеротоксины
Один из энтеротоксинов Escherichia coli является термолабильным (LT), другой — термостабильным (STа или ST-1 и STb или ST-2). Термолабильный энтеротоксин разрушается при 60 °С в течение приблизительно 30 мин, в то время как термостабильный энтеротоксин может выдерживать температуру 100 °С в течение 15 мин.
Термолабильный энтеротоксин представляет собой белок с молекулярным весом около 91 кДа и обладает ферментативной активностью, аналогичной активности холерного токсина (СТ).
Термолабильный энтеротоксин (LT) состоит из двух протомеров (субъединиц): А, с молекулярным весом около 25,5 кДа, который при обработке трипсином становится активным и состоит из полипептидной цепи А1, связанной дисульфидной связью с А2-подобной цепью, и протомера В, обладающего молекулярным весом около 59 кДа и состоящего из 5 нековалентно связанных отдельных полипептидных цепей. Протомер В термолабильного энтеротоксина (LTB) обладает иммунологическими свойствами, похожими на те, которые характерны для субъединиц А и В токсина Vibrio cholerae.
Термостабильный энтеротоксин STa обладает хорошей растворимостью в метаноле и вызывает секреторный ответ у детёнышей мышей. В его состав входит состоящий из 18-19 аминокислотных остатков кислый пептид, который содержит три дисульфидных связи и имеет молекулярную массу в 1972 Да. Этот энтеротоксин стимулирует специфическую гуанилатциклазу в кишечнике. STa был химически синтезирован.
STb нерастворим в метиловом спирте и первоначально был выделен из организма свиньи. Этот токсин является наиболее распространённым при выделении различных токсинов из диарейных фекалий свиней. Он воздействует на тонкий кишечник и связанный с ним илеум у молочных поросят, а также на кишечную петлю мышей при добавлении ингибитора протеаз. Ген этого энтеротоксина (estB) был секвенирован и клонирован. Трипсин-чувствительный STb энтеротоксин синтезируется в виде полипептида, состоящего из 71 аминокислотного остатка, которые затем расщепляются, и в результате остаётся молекула из 48 аминокислот, содержащая 4 цистеиновых остатка, которая и проходит в периплазматическое пространство клеток бактерий. Механизм действия этого энтеротоксина остаётся пока невыясненным, но показано, что он стимулирует синтез простагландина Е2. Клеточным рецептором этого энтеротоксина в клетках кишечника мыши является белок, обладающий молекулярной массой 25 кДа.
Механизм действия энтеротоксинов
Гастроэнтериты, которые определяются действием ETEC-штаммов, вызываются при поглощении 106-1010 жизнеспособных клеток бактерий на грамм, которые должны колонизировать тонкий кишечник и начать продуцировать энтеротоксины. Факторами колонизации являются обычно фимбрии или пили. Синдром определяется, прежде всего, некровавым поносом без воспалительных экссудатов в стуле. Испражнения имеют водянистую консистенцию и напоминают по структуре испражнения, характерные при заражении холерным вибрионом. Диарея происходит вследствие активации энтеротоксином аденилатциклазы кишечника, в результате действия которой происходит накопление циклического 3',5'-аденозинмонофосфата (цАМФ). Из кишечника человека выделяют кишечные палочки, синтезирующие преимущественно ST-1. Энтеротоксин ST-1 связывается с рецептором энтероцитов и увеличивает внутриклеточную концентрацию циклического гуанозинмонофосфата (цГМФ). В результате этого стимулируется секреция хлорид ионов Cl- и ингибируется всасывание ионов натрия Na+, что приводит к потере жидкости кишечником. Рецепторы к этому токсину в большей степени имеются на энтероцитах тонкой кишки, поэтому тонкая кишка преимущественно и вовлекается в патологический процесс при инфицировании такими штаммами.
Диффузно-адгерентные E. coli (DAEC)
Диффузно-адгерентные E. coli (англ. Diffusely Adherent E. coli, сокр. DAEC), также диффузно-агрегативные, диффузноагрегирующие (сокр. ДАКП) — характеризуются образованием диффузных агрегатов на эпителиальных клетках HeLa или Hep-2[44]. ДАКП имеют как фимбриальные, так и афимбриальные адгезины (семейства Afa/Dr). После того, как адгезины связываются с энтероцитами, происходит «демонтаж» (разборка) молекул актина, приводящий к удлинению микроворсинок и перераспределению белков цитоскелета. Перераспределение белков цитоскелета клеток кишечника происходит непосредственно, под участием системы секреции III типа (T3SS). Некоторые исследователи считают, что из-за трудностей классификации и идентификации DAEC роль этого возбудителя при острых кишечных инфекциях требует дополнительных эпидемиологических исследований[45].
Токсины Вибрионов

Вибрионы составляют род Vibrio, относящийся к семейству Vibrionaceae. В состав этого рода входит большое количество видов. Среди них особое значение имеет V. cholerae — возбудитель холеры, опасного инфекционного заболевания, способного не только к эпидемическому, но и пандемическому распространению. Холера является типичной антропонозной инфекцией. Природный резервуар — загрязнённая вода; источник инфекции — больной человек с первых дней заболевания и бактерионоситель. Основные механизмы передачи — фекально-оральный и контактный. Факторы передачи — вода, пищевые продукты, объекты окружающей среды. В воде открытых водоёмов холерный вибрион часто находится в ассоциациях с зоопланктоном (в частности, с веслоногими рачками) и водными растениями[46]. Пути заражения холерой — водный (через воду, используемую для питья, купания и хозяйственно-бытовых нужд), алиментарный (пищевой) и контактно-бытовой. Определённую роль могут играть мухи, способные переносить возбудителя с испражнений больного человека на пищевые продукты.
Все крупные эпидемии и пандемии холеры связаны с водой. Больной холерой человек выделяет во внешнюю среду в 1 мл испражнений от 10 млн до 1 млрд вибрионов, а бактерионоситель — до 100 тыс. микробных клеток. Переболевшие лица выделяют холерный вибрион в течение 7-10 дней после клинического выздоровления. Примерно у 4-5 % переболевших формируется хроническое носительство, при котором холерный вибрион сохраняется в жёлчном пузыре. Инфицирующая доза составляет около 1 млн микробных клеток. Заражение человека от человека не происходит.
Вид V. cholerae включает 206 серогрупп, которые различаются по структуре соматического О-антигена. Их разделяют на агглютинирующиеся типовой холерной О1-сывороткой (V. cholerae O1) и на неагглютинирующиеся типовой холерной О1-сывороткой (V. cholerae non O1). Вибрионы, неагглютинирующиеся О1-сывороткой, называются неагглютинирующимися (НАГ) вибрионами.
«Классическая» холера вызывается холерным вибрионом серогруппы О1 (V. cholerae O1). К этой серогруппе относятся 2 биовара: классический (V. cholerae 267 биовар cholerae или V. cholerae биовар asiaticae) и Эль-Тор (V. cholerae биовар eltor). Биовары V. cholerae cholerae и V. cholerae eltor включают по 3 биотипа: Инаба (Inaba), Огава (Ogawa) и Хикосима (Hikojima). Кроме представителей серогруппы О1 холеру вызывает вибрион серогруппы О139 (V. cholerae bengal). Вибрионы, относящиеся к другим серологическим группам (О2-О138, О140-О206), могут вызывать у людей спорадические или групповые случаи диарейных заболеваний, не склонных к эпидемическому распространению.
Холерный вибрион представляет собой изогнутые короткие подвижные грамотрицательные палочки[47]. Размеры клеток холерного вибриона составляют 1,5-4,0 × 0,2-0,6 мкм. Для холерных вибрионов характерен полиморфизм — в клиническом материале обнаруживаются типичные изогнутые формы (в виде запятой), а в препаратах с питательных сред преобладают прямые палочковидные формы.

Жгутик снабжён чехликом и продольным выростом, напоминающим ундулирующую мембрану. Жгутики хорошо выявляются при окраске препаратов по методу Лейфсона. Подвижность холерных вибрионов является одним из диагностических признаков возбудителя. Пили (фимбрии) представляют собой тонкие гибкие нитевидные образования на поверхности бактериальной клетки. Не образует капсул и спор. По отношению к кислороду является факультативным анаэробом.
Холерный вибрион во внешней среде чувствителен к высушиванию и действию прямых солнечных лучей, но хорошо сохраняется и размножается при температуре выше 10-12 °С в открытых водоёмах и сточных водах, богатых органическими веществами. В частности, в водоёмах возбудитель сохраняется в течение 2-3 недель. Холерные вибрионы хорошо сохраняются при низкой температуре: во льду — до 1 месяца; в морской воде — до 47 суток, в речной воде — от 3-5 дней до нескольких недель, в почве — от 8 дней до 3 месяцев. В свежих испражнениях больного возбудитель холеры сохраняется до 3 суток, на бельё, загрязнённом испражнениями больных, сохраняется до 2 суток, а на влажном материале — неделю. На варёных продуктах (рис, лапша, мясо, каши и др.) холерные вибрионы выживают в течение 2-5 дней, на сырых овощах — 2-4 дней, на фруктах — 1-2 дней, в молоке и молочных продуктах — 5 дней. При хранении продуктов в холодильнике срок выживания возбудителя увеличивается на 1-3 дня. Холерные вибрионы при 50 °С погибают через 30 минут, при 80 °С — через 5 минут, при 100 °С — через несколько секунд. Холерные вибрионы очень чувствительны к действию дезинфектантов, особенно с кислым значением рН. В растворе сулемы (1:100000) они погибают через 5 минут. Под влиянием хлорамина и других дезинфектантов погибают через 5-15 минут. Возбудитель высокочувствителен к хлору: доза активного хлора 0,3-0,4 мг/л за 30 минут вызывает надёжное обеззараживание предметов.
Токсины

V. cholerae продуцирует т. н. холерогенный экзотоксин (СТ). Он секретируется в окружающую среду системой секреции II типа. СТ состоит из компонентов А и В — два белковых домена. Домен, отвечающий за связывание с энтероцитами человека, является пентамером субъединицы В с молекулярной массой 12 кДа. Каталитический домен, осуществляющий АДФ-рибозилирование Gs α-субъединицы (Gαs) состоит из субъединицы А, с молекулярной массой 28 кДа. Структурно холерный токсин представляет собой гетерогексамер (AB5).
Компонент В через 1-3 минуты после выделения токсина из микробной клетки распознаёт на поверхности энтероцита специфический рецептор (ганглиозид Gm1), связывается с ним и формирует внутримембранный канал для прохождения компонента А внутрь клетки. Если в клетке отсутствует Gm1, токсин, скорее всего, связывается с другими типами гликанов, такими как Lewis Y и Lewis X, которые прикреплены к белкам, а не к липидам[48][49][50]. Внутри клетки белок А1 взаимодействует с Gs α-субъединицей, располагающейся на внутренней стороне мембраны энтероцита. Образующаяся АДФ-рибоза связывается с регуляторной субъединицей аденилатциклазы, в результате чего внутри клетки происходит повышение концентрации циклического аденозинмонофосфата (цАМФ). Эти изменения происходят в течение 30 минут после контакта токсина с клеточным рецептором.

Гиперпродукция молекул цАМФ приводит к выходу из энтероцитов в просвет кишечника внутриклеточной жидкости с низким содержанием белка и высокой концентрацией катионов и анионов (Na+, НСО3-, K+, Сl-)[51]. Всё это приводит к развитию сильнейшей диареи, обезвоживанию и обессоливанию организма. Кроме того, в результате нарушения водно-солевого баланса в просвете кишечника создаётся идеальная щелочная среда для размножения возбудителя[52].
Помимо холерогенного токсина, V. cholerae продуцируют и эндотоксины. Эндотоксин V. cholerae представляет собой термостабильный липополисахарид (LPC). Он отвечает за общую интоксикацию организма и рвоту. Эндотоксин холерного вибриона воздействует на арахидоновую кислоту, входящую в состав фосфолипидов клеточных мембран. В результате этого происходит синтез простагландинов, которые вызывают сокращение гладкой мускулатуры тонкого кишечника и обусловливают тенезмы. Антитела, образующиеся против эндотоксина, обладают выраженным вибриоцидным действием (растворяют вибрионы в присутствии системы комплемента) и являются важным компонентом постинфекционного и поствакцинального иммунитета.
Токсины Листерий

Листерии являются грамположительными, неспорообразующими и не кислотоустойчивыми палочковидными бактериями, являются факультативными анаэробами[53], которые были изначально названы «Listerella». В 1940 г. родовое наименование было изменено на Listeria. Во многих отношениях они похожи на представителей рода Brochothrix. Бактерии обоих родов являются положительными по каталазе и имеют тенденцию к взаимосвязям в природных условиях наряду с бактериями рода Lactobacillus, однако, в отличие от Listeria и Brochothrix, лактобациллы являются отрицательными по каталазе.
Листерии широко распространены в природе и могут быть обнаружены на гниющей растительности в почве, испражнениях животных, канализационных водах, силосной массе и в воде. Как правило, можно ожидать обнаружение листерий в тех средах обитания, где существуют также молочнокислые бактерии, Brochothrix, а также некоторые из коринеформных бактерий. Связь бактерий этой группы с молочными продуктами и силосом хорошо известна, так же как и связь с этими продуктами некоторых других продуцентов молочной кислоты.
Достаточно хорошо установлено, что любые свежие продукты питания животного и растительного происхождения могут содержать бактерии L. monocytogenes в тех или иных количествах. Эти организмы, как правило, выявляются в сыром молоке, мягких сырах, в свежем и замороженном мясе, в мясе птиц, морепродуктах и фруктовых и овощных продуктах. Преимущественное нахождение этих бактерий в молоке и молочных продуктах вызывает повышенное внимание к ним из-за частых вспышек массовых заражений. L. innocua обычно обнаруживают в мясе, молоке, замороженных морепродуктах, полумягком сыре, образцах яиц и овощах. Как правило, этот вид листерий превалирует в молочных продуктах.
Из всех видов листерий Listeria monocytogenes является патогеном, который в наибольшей степени затрагивает человека. Несмотря на то что бактерии L. ivanovii, например, могут активно размножаться на модельных мышах, их пролиферация осуществляется в гораздо меньшей степени, чем у L. monocytogenes, и их присутствие в концентрации до 106 клеток не вызывает инфекции у мышей. Такие виды, как L. innocua, L. welshimeri и L. seeligeri, не являются патогенными, хотя последний из них продуцирует гемолизин. Наиболее значительным фактором вирулентности, связанным с бактериями L. monocytogenes, является листериолизин О (LLO).
Вирусы как биологические контаминанты
По ряду причин о случаях обнаружения в продуктах вирусов известно намного меньше, чем о бактериях и грибах. Во-первых, вирусы — облигатные паразиты, которые не растут на культуральных питательных средах как бактерии и грибы. Обычно для культивирования вирусов применяют культуру ткани или методики, использующие куриный эмбрион. Во-вторых, вирусы не размножаются в продуктах, их число, как предполагают, ниже по сравнению с бактериальным числом, и для их выделения необходимы методы экстракции и концентрирования. Хотя этой методологии было посвящено много исследований, трудно получить больше 50%-го выделения вирусных частиц из таких продуктов, как говядина. В-третьих, лабораторные вирусологические методики неосуществимы во многих микробиологических лабораториях, исследующих пищевые продукты.
Для обеспечения безопасности применения инъекционных лекарственных препаратов на основе специфических иммуноглобулинов животного происхождения (гетерологичных иммуноглобулинов) необходимо исключить их вирусную контаминацию на всех этапах их производства[54]. Требования к вирусной безопасности препаратов гетерологичных иммуноглобулинов представлены в действующем издании фармакопеи.
Ротавирусы

Впервые ротавирусы были обнаружены в 1973 году в Австралии, в первый раз их удалось культивировать в лаборатории в 1981 г. Были идентифицированы девять видов (обозначаются буквами A-J)[55][56], три из них (А, В и С) являются контагиозными для людей. Группа A встречается обычно среди младенцев и маленьких детей во всём мире. Группа B вызывает диарею у взрослых и отмечена только в Китае. Ротавирусы принадлежат семейству Reoviridae; в диаметре они приблизительно 70 нм, безоболочечные (без суперкапсида) и содержат двухцепочечную РНК (дцРНК), частицы вирусов морфологически напоминают колесо (от лат. rota — «колесо»), откуда и получили своё название. Фекально-оральный путь — первичный способ передачи, при контакте через загрязнённые руки, поверхности и предметы быта (вещи, столовые приборы итд.)[57]. Вирусная диарея, вызванная инфицированием очень контагиозна.
Ротавирусы стабильны в окружающей среде и были обнаружены в пробах воды из устьев рек в количестве до 1-5 инфекционных частиц на галлон США (~ 1 частица на литр). Средняя выживаемость вирусов вне клеток составляет от 9 до 19 дней[58].
Вирус гепатита A
До 1990-х гг. вспышек гепатита А обнаруживаемого в продуктах, было зарегистрировано больше, чем любой другой вирусной инфекции. Вирус гепатита A принадлежит семейству Picornaviridae так же, как и полиомиелит, ЕСНО-вирус и вирусы Коксаки, все они имеют геномы из односпиральной РНК (ssРНК). Инкубационный период при гепатите длится от 15 до 45 дней с пожизненным иммунитетом к повторному заражению. Способ передачи — фекально-оральный, самое обычное средство передачи — сырой или частично приготовленный моллюск из загрязнённых вод.
Прионы как контаминанты

Прионы (англ. prion от protein «белок» + infection «инфекция»; слово было предложено в 1982 году Стенли Прузинером[59]) представляют собой особый класс инфекционных агентов, который не содержит нуклеиновых кислот. Прионы это белки, имеющие аномальную третичную структуру, способные к катализу конформационных превращений гомологичных молекул белка в себе подобные. При этом процесс инфицирования протекает без участия передачи информации, осуществляемых посредством нуклеиновых кислот. Благодаря патологическому фолдингу в здоровых клетках растёт число молекул прионов, происходит замещение нормальных белков на последние, которые способны к образованию плотно упакованных фибриллярных белков — бета-амилоидов. Вызванные патологические процессы являются необратимыми. Прионные заболевания носят нейродегенеративный характер (прионы поражают клетки головного мозга). Несмотря на длительный инкубационный (латентный) период (от 5 до 20 лет), при появлении симптомов, прионные заболевания быстро прогрессируют, приводя к повреждению головного мозга и смерти[60]. Все прионные заболевания неизлечимы и имеют 100%-ую летальность.
Прионы очень устойчивые к агрессивным воздействиям, они не чувствительны к термической обработке (выдерживают кипячение более 1 часа), ионизирующему излучению, УФ-излучению, химическим веществам: к растворителям (ацетон, этанол, бензол, аммиак (1М), мочевина (7-8М)), формалину, протеолизу (ферментами и в кислой среде), к воздействию некоторых окислителей (перекись водорода, перманганат калия, спиртовой раствор йода, фенолы). Деградация и полная инактивация прионов возможна только агрессивными агентами, такими, как концентрированные растворы щелочей, которые невозможно использовать в производстве пищевых продуктов.
Передача прионов к человеку возможна алиментарным путём через инфицированное мясо и мясные продукты, больных животных — овец, коров.
Микотоксины и токсины грибов
Микотоксины (от греч. μύκης, mykes, mukos — «гриб» и τοξικόν, toxikon — «яд») — это вторичные метаболиты микроскопических плесневых грибов, обладающие выраженными токсическими свойствами[7]. Они не являются эссенциальными для роста и развития продуцирующих их микроорганизмов.
С гигиенических позиций — это особо опасные токсические вещества, загрязняющие корма и пищевые продукты. Высокая опасность микотоксинов выражается в том, что они обладают токсическим эффектом в чрезвычайно малых количествах и способны весьма интенсивно диффундировать вглубь продукта.
Афлатоксины

Афлатоксины (AF, сокр. от Aspergillus flavus toxins) — органические соединения, из группы поликетид, представляют собой одну из наиболее опасных групп микотоксинов, обладающих чрезвычайной высокой токсичностью и гепатоканцерогенностью[61].
Афлатоксины, несомненно, наиболее изученные из всех микотоксинов. Первые данные об их существовании относятся к 1960 году, когда внезапно и почти одновременно 100 000 индюшат погибли в Англии (так называемая «болезнь-Х») после употребления арахисовой муки, импортируемой из Африки и Южной Америки[62].
В настоящее время семейство афлатоксинов включает четыре основных представителя (афлатоксины B1, B2, G1, G2)[63] и ещё более 10 соединений, являющихся производными или метаболитами основной группы (M1, M2, B2a, G2a, GM1, афлатоксикол, P1, Q1 и др.)[64].
Продуцентами афлатоксинов являются некоторые штаммы двух видов микроскопических грибов: Aspergillus flavus (Link.) и Aspergillus parasiticus (Speare)[65].
 |  |  |
 |  |  |

В природных условиях чаще и в наибольших количествах афлатоксины обнаруживаются в арахисе, кукурузе, семенах хлопчатника. Кроме того, в значительных количествах они могут накапливаться в различных орехах (грецкий орех, миндаль, фундук, кешью и др.), семенах масличных культур, пшенице, ячмене, зёрнах какао и кофе[66].
В кормах, предназначенных для сельскохозяйственных животных, афлатоксины также обнаруживаются достаточно часто и в значительных количествах. Во многих странах с этим связано и обнаружение афлатоксинов в продуктах животного происхождения. Например, в молоке и тканях сельскохозяйственных животных, получавших корма, загрязнённые микотоксинами, обнаружен афлатоксин М1. Причём афлатоксин М1 обнаружен как в цельном, так и в сухом молоке и даже в молочных продуктах, подвергшихся технологической обработке (пастеризация, стерилизация, приготовление творога, йогурта, сыров и т. п.).
Термическая обработка, используемая в кулинарии не способствует уменьшению концентрации афлатоксинов, ввиду того, что они устойчивы к нагреванию, даже в автоклавах при довольно высоких температурах и продолжительности процесса (t > 120 °C, более 40 минут). Для разрушения афлатоксинов необходимы дополнительные мероприятия, например, использование окислителей, экстракция с полярными органическими растворителями (хлороформ, ацетон) или азеотропными смесями (оптимальный вариант — смесь воды и метоксиметана), использование раствора или газообразного аммиака, который наиболее эффективно уничтожает организмы продуценты аспергиллы и разрушает до 98 % афлатоксинов.
Токсическое воздействие афлатоксинов
Действие афлатоксинов на организм животных и человека может быть охарактеризовано с двух позиций. Во-первых, с точки зрения острого токсического действия и, во-вторых, с точки зрения оценки опасности отдалённых последствий.
Острое токсическое действие афлатоксинов связано с тем, что они являются одними из наиболее сильных гепатропных ядов, органом-мишенью которых является печень. Отдалённые последствия действия афлатоксинов проявляются в виде канцерогенного, мутагенного и тератогенного и иммунодепрессивного эффектов. Наиболее изучен афлатоксин B1.
| Животные | Способ введения | Токсичность (LD50) в мг/кг |
|---|---|---|
| Утка | п/о | 0,5-2,0 |
| Крысы | п/о, вб | 1,2-17,9 (в зависимости от пола и возраста) |
| Хомяки | п/о | 9,0-10,2 |
| Мыши | п/о | 6,0-9,0 |
| Кролики | п/о | ~0,5 |
| Морские свинки | вб | ~1,0 |
| Собака | п/о | 0,45-0,5 |
| Речная форель | п/о | <0,5 |
Механизм воздействия на гепатоциты имеет сходства с механизмом воздействия ПАУ. Однако продукты гидроксилирования имеют более высокие окислительные свойства и повреждают клетки посредством нарушения структуры целостности биомембран и алкирования нуклеиновых кислот.

В молекулах афлатоксинов содержится большое количество атомов кислорода, вследствие этого, попадая в клетку печени и подвергаясь эпоксидированию (окислению), посредством цитохрома P450 микросомальной системы молекулы приобретают чрезвычайно реакционноспособные свойства. Молекулы образовавшегося эпоксида легко проникает в ядро, с помощью белка AHR. В ядре они немедленно начинают алкилировать цепи ДНК, образуя с ними прочные аддукты. Происходит торможение и полное подавление синтеза молекул тРНК. В ядре появляются морфологические изменения. Алкилирование ДНК приводит к повреждениям гена-онкосупрессора p53, вплоть до утраты к экспрессии белка[67]. Тем самым лишая гепатоцит апоптоза. Дальнейшее продолжение процесса приводит к трансформации клеток, посредством активации некоторых онкогенов, например, K-ras, вызывая гепатоцеллюлярную карциному[68].
Скорость алкилирования лимитируется концентрацией продуктов гидроксилирования, однако, даже минимальное количество причиняет серьёзные повреждения гепатоцитам. Помимо этого они обладают сильнейшей гепатотоксичностью (в особенности афлатоксин B1 — наиболее токсичный, СДЯВ, минимальная летальная доза для человека составляет менее 2 мг/кг).
Афлатоксины способны вызывать у человека острые и хронические микотоксикозы, названные афлатоксикозами. Возникновению афлатоксикозов способствует отсутствие надлежащего санитарно-эпидемиологического контроля за продуктами питания, особенно в странах с жарким и влажным климатом (страны тропической Африки, Юго-восточной Азии и Индия), где среди местного населения наблюдаются высокие показатели цирроза печени и гепатоцеллюлярной карциномы.
Помимо гепатотропного и канцерогенного эффектов, афлатоксины способны снижать иммунитет, посредством влияния на митохондрии и клеточные мембраны лимфоцитов. Нарушают синтез цитокинов макрофагов и Т-лимфоцитов.
Отравление афлатоксинами требует безотлагательных мер медицинской помощи.
Согласно данным ВОЗ, человек при благоприятной гигиенической ситуации потребляет с суточным рационом до 0,19 мкг афлатоксинов. В России приняты следующие санитарно-гигиенические нормативы по афлатоксинам: № 015/2011 о безопасности зерна и № 021/2011 о безопасности пищевой продукции ПДК афлатоксина В1 для всех пищевых продуктов, кроме молока, составляет 5 мкг/кг, для молока и молочных продуктов — 1 мкг/кг (для афлатоксина М1 — 0,5 мкг/кг). Допустимая суточная доза (ДСД) — 0,005-0,01 мкг/кг массы тела. В ферментных молокосвёртывающих препаратах грибного происхождения, продуктах для детей, беременных и кормящих женщин наличие афлатоксина B1 не допускается.
Трихотецены

Трихотеценовые микотоксины или просто трихотецены (сокр. ТТМТ) — органические соединения из так называемого семейства сесквитерпеноидов, их отличительной чертой служит трихотеценовое кольцо (трихотекан), которое содержит двойную связь при С-9 и эпоксидную группу в области С-12,13[69]. В настоящее время идентифицировано более 150 трихотеценов[70], большинство из них являются слаботоксичными, лишь немногие — смертельно опасны. Трихотеценовые микотоксины — вторичные метаболиты, которые продуцируются в основном микроскопическими плесневыми грибами (микромицетами) рода Fusarium, а также в меньшей степени Stahybotrys, Trichoderma, Cephalosporium, Trichothecium и Mizothecium. Биологические контаминанты, являются сильными иммунодепрессантами, поражают органы кроветворения, желудочно-кишечного тракта, повышают риск возникновения геморрагий (кровоизлияний) внутренних органов человека[71].
В зависимости от структуры трихотеценового ядра эти микотоксины подразделяются на 4 группы: А, В, С и D. Структура различных типов трихотеценовых микотоксинов очень сложна и имеет свои характерные особенности.
В качестве природных загрязнителей (контаминантов) пищевых продуктов и кормов к настоящему времени выявлены только четыре: Т-2 токсин и диацетоксискирпенол, относящиеся к типу А, а также ниваленол и дезоксиниваленол (вомитоксин), относящиеся к типу B. В Европе (включая и территорию РФ) наиболее распространённым трихотеценом является дезоксиниваленол (вомитоксин)[72].

 Диацетоксискирпенол
Диацетоксискирпенол Дезоксиниваленол или вомитоксин
Дезоксиниваленол или вомитоксин Ниваленол
Ниваленол
Токсическое воздействие трихотеценов
Алиментарные токсикозы, вызванные потреблением в пищу продуктов и кормов, поражённых микроскопическими грибами, продуцирующими ТТМТ, можно отнести к наиболее распространённым микотоксикозам человека и сельскохозяйственных животных. Первые сведения о такого рода заболеваниях появились более ста лет тому назад.
Хорошо известен, так называемый токсикоз «пьяного хлеба» — заболевание человека и животных, причиной которого послужило употребление зерновых продуктов (главным образом хлеба), приготовленных из зерна, поражённого грибами Fusarium graminearum (F. roseum). Кроме того, описан целый ряд тяжёлых токсикозов, таких как акабаби-токсикоз (впервые описан в Японии, вызывается красной плесенью и связан с поражением зерна грибами F. nivale и F. graminearum)[73], алиментарная токсическая алейкия — АТА (микотоксикоз, связанный с употреблением в пищу продуктов из зерновых культур, перезимовавших в поле под снегом и поражённых микроскопическими грибами F. sporotrichiella и F. poae) и многие другие, приводящие к серьёзному нарушению здоровья людей и протекающие по типу эпидемий, то есть характеризующиеся определённой очаговостью, сезонностью, неравномерностью вспышек в разные годы и употреблением продуктов из зерна, поражённого микроскопическими грибами.
Многочисленными исследованиями in vitro и in vivo было показано, что трихотецены являются ингибиторами синтеза белков (на всех этапах синтеза), и нуклеиновых кислот (в частности тРНК). Трихотецены также обладают способностью влиять на общую функцию клеточных ферментов из-за тенденции тиоловых групп активного центра атаковать 12,13-углеродное эпоксидное кольцо[74]. Данные ингибирующие эффекты наиболее ярко проявляются в активно делящихся клетках тканей, таких как желудочно-кишечного тракта или красного костного мозга (миелоидной). Кроме этого, вызывают нарушения стабильности лизосомных мембран и активацию ферментов лизосом, что в конечном счёте приводит к гибели клетки.
Охратоксины
Охратоксины — органические соединения, группа микотоксинов, производные кумарина, продуцируемые некоторыми видами микроскопических плесневых грибов рода Аспергилл (страны с преимущественно субтропическим и тропическим климатом) и Пеницилл (страны с умеренным климатом). Основной продуцент охратоксинов среди грибов рода Пеницилл — Penicillium verrucosum, среди аспергиллов — Aspergillus ochraceus и некоторые другие виды аспергиллов, включая A.carbonarius и A.niger. Являются биологическими контаминантами. Источниками охратоксинов служат растительные продукты, в особенности зерновые культуры (пшеница, ячмень, кукуруза итд.). По обобщённым статистическим данным, в европейских странах, Канаде, США частота контаминации зерна охратоксином А составляет 5 % и характеризуется диапазоном содержаний токсина от 5 до 360 мкг/кг[75].
Из культуры гриба А. ochraceus выделено четыре охратоксина — А, В, С и D (ТА). Все охратоксины проявляют сильную нефротоксичность. В крови они быстро связываются с белками. Наиболее распространённым и токсичным является охратоксин А. Охратоксины незначительно различаются между собой (имеют сходную структуру молекул). Так, например, охратоксин В отличие от типа А не содержит атома хлора; охратоксин С — это этилохратоксин А[76].

 Охратоксин B
Охратоксин B Охратоксин C
Охратоксин C Охратоксин TA
Охратоксин TA
Токсичность охратоксинов
Охратоксины входят в группу микотоксинов, преимущественно поражающих почки (нефротоксины). Охратоксин А нефротоксичен для всех изученных до сих пор видов животных даже при воздействии в наименьших из исследованных концентрациях (200 мкг/кг корма у крыс и свиней). Поражение включает атрофию канальцев, интерстициальный фиброз и, в поздних стадиях, гиалинизацию клубочков. При остром токсикозе, вызванном охратоксинами, патологические изменения выявляются и в печени, и в лимфоидной ткани, и в желудочно-кишечном тракте. В настоящее время уже доказано, что охратоксин А обладает сильным тератогенным действием. Вопрос о канцерогенности охратоксинов для человека остаётся нерешёнными.
Биохимические, молекулярные, клеточные механизмы действия охратоксинов изучены недостаточно. В исследованиях in vitro показано, что они активно связываются с различными белками: альбуминами сыворотки крови, тромбином, альдолазой, каталазой, аргиназой, карбоксипептидазой А. Некоторые моменты подтверждены и в исследованиях in vivo. Результаты изучения влияния охратоксинов на синтез макромолекул свидетельствуют о том, что охратоксин А ингибирует синтез белка и матричной РНК (токсин действует как конкурентный ингибитор), но не действует на синтез ДНК.
Для охратоксина А период полураспада в организме человека определён в 840 часов.
Фумонизины

Фумонизины — органические соединения, микотоксины, вторичные метаболиты, продуцируемые некоторыми видами микроскопических плесневых грибов (микромицетами) рода Fusarium (в частности, Fusarium verticillioides[77]), Lesiola[78]. Характерной особенностью этих микотоксинов является необычайное структурное сходство с молекулой жирного спирта — сфинганина, предшественника сфингозина и сфинголипидов[79]. Существует большое количество различных видов фумонизинов (более 100), однако, наиболее опасными контаминантами сырья и продуктов из них являются только 4: фумонизин B1 (самый распространённый и токсичный), В2, В3 и В4.
 Фумонизин B1
Фумонизин B1 Фумонизин B2
Фумонизин B2
Впервые фумонизины (ФB1 и ФB2) были обнаружены и идентифицированы в 1970 году, в поражённой микромицетом F. verticillioides кукурузе, которая при употреблении вызвала вспышку лейкоэнцефаломаляции у лошадей. Однако, впоследствии они были найдены и в других злаковых культурах: пшенице, сорго, рисе. Фумонизин В2 методом ВЭЖХ и тандемной масс-спектроскопии был обнаружен в зёрнах кофе[80].
Токсичность фумонизинов
Токсичность фумонизинов невелика, но несмотря на это, они способны к серьёзным провреждениям клеточных мембран, вызывая апоптоз (вследствие нарушения целостности) гепатоцитов и клеток почек. Структурная аналогия фумонизинов приводит к тому, что они способны блокировать синтез сфинголипидов, посредством ингибирования ферментов 3-кетосфинганин редуктазы (шифр КФ 1.1.1.102) и N-ацетилсфингозин трансферазы (церамидсинтазы, шифр КФ 2.3.1.24). В клетках накапливаются субстраты данных ферментов, молекулы сфинганина, сфингозина и их 1-фосфатных метаболитов и снижаются концентрации сложных сфинголипидов. Накопление сфинганина и сфингозина является основной причиной токсичности фумонизина В1. Сфинганин и сфингозин в больших количествах цитотоксичны и ингибируют рост. Фумонизин В2 более цитотоксичен, чем фумонизин B1.
Считается, что существует связь между интоксикацией F. verticillioides и раком пищевода человека. Низкий социально-экономический статус и менее разнообразное питание, в основном состоящее из кукурузы и пшеницы, связаны с возникновением рака пищевода. Данная связь основана на эпидемиологических исследованиях в различных странах. Другие исследования показывают, что более высокие концентрации ФB1, ФB2 и F. verticillioides присутствуют в кукурузе, выращиваемой в регионах с высоким процентом рака пищевода.
Острый фумонизинотоксикоз (микотоксикоз) — пищевое отравление при употреблении продуктов, заражённых микромицетами, продуцирующие фумонизины. В 1995 году в 27 деревнях Индии произошла вспышка заболевания, характеризоваваяся диареей и болями в животе. Это произошло в результате употребления заплесневелого сорго и кукурузы, образовавшиеся в результате повышенной влажности (сезон дождей). Данная вспышка была изучена, и микотоксикоз был связан с употреблением пресного хлеба. Образцы кукурузы и сорго были собраны в домохозяйствах и исследованы. Кукуруза и сорго были заражены Fusarium и Aspergillus и содержали высокие уровни ФВ1 по сравнению с выборками незатронутых интоксикацией домохозяйств[81].
Патулин

Патулин — особо опасное вещество, обладающее канцерогенными и мутагенными свойствами, производное пирана (4-гидроксифуропиранон), трикетид, вторичный метаболит и микотоксин, продуцируемый некоторыми видами микроскопических плесневых грибов рода Aspergillus, Penicillium и реже Byssochlamys. Широко распространён. Является биологическим контаминантом. Высокотоксичен (при пероральном приёме, LD50 ≈ 17-20 мг/кг), поражает органы ЖКТ, обладает канцерогенным и генотоксическим воздействием, сообщалось, что он является иммуносупрессором для животных[82]. Помимо этого он проявляет свойства антибиотика, действуя на некоторые виды микроорганизмов[83]. Термостабилен, не разрушается при продолжительном нагревании и пастеризации.
Основными продуцентами патулина являются микроскопические грибы Penicillium patulum и Penicillium expansu. Но и другие виды этого рода микроскопических грибов, а также Byssochlamys fulva и B. nivea способны синтезировать патулин. Максимальное токсинообразование отмечается при температуре 21-30 °С.
Биологическое действие патулина проявляется как в виде острых токсикозов, так и в виде ярко выраженных канцерогенных и мутагенных эффектов. Биохимические механизмы действия патулина изучены недостаточно. Предполагают, что патулин блокирует синтез ДНК, РНК и белков, причём блокирование инициации транскрипции осуществляется за счёт ингибирования ДНК-зависимой РНК-полимеразы. Кроме этого, микотоксин активно взаимодействует с SH-группами белков и подавляет активность тиоловых ферментов.
Продуценты патулина поражают в основном фрукты и некоторые овощи, вызывая их гниение[84]. Патулин обнаружен в яблоках, грушах, абрикосах, персиках, вишне, винограде, бананах, клубнике, голубике, бруснике, облепихе, айве, томатах. Наиболее часто патулином поражаются яблоки[85], где содержание токсина может доходить до 17,5 мг/кг. Патулин концентрируется в основном в подгнившей части яблока, в отличие от томатов, где он распределяется равномерно по всей ткани.
Патулин в высоких концентрациях обнаруживается и в продуктах переработки фруктов и овощей: соках, компотах, пюре и джемах. Особенно часто его находят в яблочном соке (0,02-0,4 мг/л). Содержание патулина в других видах соков: грушевом, айвовом, виноградном, сливовом, манго — колеблется от 0,005 до 4,5 мг/л. В России приняты санитарно-гигиенические нормативы, допускающие уровень содержания патулина в плодово-овощной продукции не более 0,05 мг/кг[84]. Интересным представляется тот факт, что цитрусовые и некоторые овощные культуры, такие как картофель, лук, редис, редька, баклажаны, цветная капуста, тыква и хрен обладают естественной устойчивостью к заражению грибами-продуцентами патулина.
Цитринин

Микотоксин цитринин является поликетидом, продуцируется Penicillium citrinum, P. veridicatum и в меньшей степени другими микромицетами (Aspergillus). Он был выделен из полированного риса, плесневелого хлеба, очищенной ветчины, пшеницы, овсяных зёрен, ржи и других продуктов. Под ультрафиолетовым излучением он флуоресцирует лимонно-жёлтым цветом.
Хотя цитринин-продуцирующие организмы были обнаружены на бобах какао и кофе, эти микотоксины, как и другие, не найдены на этих продуктах в процессе их роста. Очевидная причина — ингибирование синтеза цитринина кофеином. Ингибирование цитринина является, вероятнее всего, специфичным, поскольку отмечается лишь небольшое уменьшение в росте продуцирующих его организмов.
Известен как канцероген. Высокотоксичен (LD50 = 19,0 мг/кг). Обладает также антибиотическим действием, но использовать его в качестве антибиотика нельзя, так как цитринин проявляет сильную нефротоксичность.
Контроль за загрязнением микотоксинами
В настоящее время вопросы контроля за загрязнением продовольственного сырья, пищевых продуктов и кормов микотоксинами решаются не только в рамках отдельных государств, но и на международном уровне под эгидой ВОЗ и ФАО.
В системе организации контроля за загрязнением продовольственного сырья и пищевых продуктов можно выделить два уровня: инспектирование и мониторинг, которые включают регулярные количественные анализы продовольственного сырья и пищевых продуктов.
Мониторинг позволяет установить уровень загрязнения, оценить степень реальной нагрузки и опасности, выявить пищевые продукты, являющиеся наиболее благоприятным субстратом для микроскопических грибов — продуцентов микотоксинов, а также подтвердить эффективность проводимых мероприятий по снижению загрязнения микотоксинами.
Особое значение имеет контроль за загрязнением микотоксинами при характеристике качества сырья и продуктов, импортируемых из других стран. С целью профилактики алиментарных микотоксикозов основное внимание следует уделять зерновым культурам. В связи с этим необходимо соблюдать следующие меры по предупреждению загрязнения зерновых культур и зернопродуктов:
- Своевременная уборка урожая с полей, его правильная агротехническая обработка и хранение.
- Санитарно-гигиеническая обработка помещений и ёмкостей для хранения.
- Закладка на хранение только кондиционного сырья.
- Определение степени загрязнения сырья и готовых продуктов.
- Выбор способа технологической обработки в зависимости от вида и степени загрязнения сырья.
Токсины грибов
В эту группу включены токсины, продуцируемые высшими грибами, которые могут вызвать отравления и/или смерть при употреблении в пищу. Отравления токсинами грибов — мицетизмы — нередко являются тяжёлыми.
Аматоксины

Аматоксины, также аманитотоксины — группа органических соединений, представляют собой циклические пептиды (октапептиды), состоящие из восьми аминокислотных остатков. Все токсины аманита содержат γ-гидроксилированные аминокислоты, что является условием их токсичности[86]. Чрезвычайно токсичны, сильнейшие гепатотоксины, поражают клетки печени (гепатоциты), вызывая их некроз, и тем самым представляют большую угрозу здоровью и жизни человека при интоксикации.

Всего известно десять видов аматоксинов, представленных в виде таблицы[87]:
| Название | R1 | R2 | R3 | R4 | R5 |
|---|---|---|---|---|---|
| α-Аманитин | OH | OH | NH2 | OH | OH |
| β-Аманитин | OH | OH | OH | OH | OH |
| γ-Аманитин | H | OH | NH2 | OH | OH |
| ε-Аманитин | H | OH | OH | OH | OH |
| Амануллин | H | H | NH2 | OH | OH |
| Амануллиновая кислота | H | H | OH | OH | OH |
| Аманинамид | OH | OH | NH2 | H | OH |
| Аманин | OH | OH | OH | H | OH |
| Проамануллин | H | H | NH2 | OH | H |
Источниками аматоксинов являются некоторые виды грибов рода Аманита (бледная поганка, белая поганка, весенняя поганка и др.), Галерина (галерина окаймлённая и др.) и Лепиота или Чешуйница (лепиота коричнево-красная, лепиота каштановая, лепиота розоватая и др.). Наиболее распространённые и смертельно опасные грибы, содержащие аматоксины:
 Лепиота коричнево-красная (Lepiota brunneoincarnata) — один из наиболее смертельно опасных грибов своего рода
Лепиота коричнево-красная (Lepiota brunneoincarnata) — один из наиболее смертельно опасных грибов своего рода Галерина окаймлённая (Galerína margináta), смертельно ядовитый гриб
Галерина окаймлённая (Galerína margináta), смертельно ядовитый гриб Белая поганка или белый мухомор — один из смертельно опасных видов грибов рода Аманита
Белая поганка или белый мухомор — один из смертельно опасных видов грибов рода Аманита Лепиота каштановая, ещё один смертельно опасный гриб, содержащий большое количество аматоксинов
Лепиота каштановая, ещё один смертельно опасный гриб, содержащий большое количество аматоксинов Бледная поганка (Amanita phalloides), самый распространённый на Земле смертельно ядовитый базидиальный гриб из всех известных грибов[88][89], относящийся к роду Аманита (Мухомор). Токсины бледной поганки включают в себя две большие группы циклических пептидов — фаллотоксины (гексапептиды) и аматоксины (октапептиды). Было подсчитано, что всего лишь половина гриба содержит такие концентрации токсинов, которые способны убить взрослого человека[90]
Бледная поганка (Amanita phalloides), самый распространённый на Земле смертельно ядовитый базидиальный гриб из всех известных грибов[88][89], относящийся к роду Аманита (Мухомор). Токсины бледной поганки включают в себя две большие группы циклических пептидов — фаллотоксины (гексапептиды) и аматоксины (октапептиды). Было подсчитано, что всего лишь половина гриба содержит такие концентрации токсинов, которые способны убить взрослого человека[90] Лепиота розоватая (Lepiota subincarnata) смертельно ядовитый гриб[91]
Лепиота розоватая (Lepiota subincarnata) смертельно ядовитый гриб[91]
Все аматоксины — СДЯВ, с ярко выраженным цитотоксическим воздействием. Вызывают деструкции (разрушения) клеток желудка и особенно энтероцитов кишечника. Наиболее чувствительными к воздействию аматоксинов являются клетки печени и почек. Однако воздействие происходит медленно. Минимальная летальная доза колеблется от 0,1 мг (α-аманитин) до 7 мг/кг тела человека.
Фаллотоксины

Фаллотоксины, также фаллоидины — группа органических соединений, представляют собой циклические гептапептиды, состоящие из 7-ми аминокислотных остатков, соединённые мостиками боковых цепей остатков триптофана и цистеина. За исключением указанных остатков все аминокислоты имеют L-конфигурацию[92]. Фаллотоксины относятся к ингибиторам цитоскелета и блокируют его ремоделирование. Все фаллоидины это чрезвычайно токсичные вещества, которые проявляют гепатотоксическое воздействие, посредством поражения клеток паренхимы печени (некрозы). Отличаются более быстрым периодом токсического воздействия на неё и латентным периодом, а также меньшей токсичностью (ЛД50 фаллоидина ~ 1,9 мг/кг, остальные 9-12 мг/кг), нежели аматоксины. Встречаются вместе с аматоксинами в плодовых телах грибов рода Аманита (Мухомор).

Известные виды фаллотоксинов представлены в виде таблицы:
| Название | R1 | R2 | R3 | R4 |
|---|---|---|---|---|
| Фаллацин | CH2CH(OH)(CH3)2 | CH(CH3)2 | CH(OH)COOH | OH |
| Фаллацидин | CH2C(OH)(CH3)CH2OH | CH(CH3)2 | CH(OH)COOH | OH |
| Фаллизацин | CH2C(OH)(CH2OH)2 | CH(CH3)2 | CH(OH)COOH | OH |
| Фаллизин | CH2C(OH)(CH2OH)2 | CH3 | CH(OH)CH3 | OH |
| Фаллоидин | CH2C(OH)(CH3)CH2OH | CH3 | CH(OH)CH3 | OH |
| Фаллоин | CH2CH(OH)(CH3)2 | CH3 | CH(OH)CH3 | OH |
| Профаллоин | CH2CH(OH)(CH3)2 | CH3 | CH(OH)CH3 | H |
Болесатин

Болесатин представляет собой гликопротеин, с молекулярной массой ~ 63 кДа, обнаруженный и выделенный из плодовых тел сатанинского гриба (Boletus satanas). Является термолабильным (неустойчивым к нагреванию) ингибитором белкового синтеза[93][94]. Относится к группе рибосомо-инактивирующих белков, токсинов, встречающихся в бактериях и растениях.
Чрезвычайно токсичен, ингибирует синтез белков и ДНК посредством гидролиза нуклеотидов, поражает органы ЖКТ, сильнейший гематический токсин, вызывает обширные тромбозы и гемостаз в печени и почках млекопитающих[95]. ЛД50 = 3,3 мг/кг (мыши, перорально).
Отравление болесатином возникает при употреблении сырых плодовых тел сатанинского гриба. Симптомы отравления наступают в среднем после 6 часов лантентного периода и включают в себя: диспепсию, тошноту, сильную рвоту, повышение температуры, абдоминальную боль, острый гастроэнтерит, геморрагический синдром, понос с кровью, возможно возникновение гепатита с тромботическим поражением сосудов печени и почечной недостаточностью[96][97][98][99].
Гиромитрин



Гиромитрин (N'-этилиден-N-метилформогидразид) — азотсодержащее органическое вещество, производное гидразина, обладает высокой токсичностью и канцерогенностью. Найден в плодовых телах сумчатых грибов рода Строчок (Gyromitra). Гиромитрин нестабилен и легко гидролизуется до чрезвычайно токсичного соединения монометилгидразина. Монометилгидразин (ММН) действует на центральную нервную систему, вызывает гемолиз эритроцитов и нарушает обмен витамина В6. Отравление приводит к тошноте, спазмам желудка и диарее, в то время как тяжёлое отравление может привести к судорогам, желтухе или даже коме или смерти. Было показано, что воздействие монометилгидразина является канцерогенным для мелких млекопитающих. Токсичность гиромитрина сильно варьируется в зависимости от исследуемых видов животных. Средняя летальная доза (LD50) составляет 244 мг/кг для мышей, 50-70 мг/кг для кроликов и 30-50 мг/кг для людей[102]. Токсичность в значительной степени обусловлена образующихся в результате гидролиза молекул ММН; около 35 % проглоченного гиромитрина превращается в MMH. На основании этого преобразования было оценено, что ЛД50 ММН для человека составляет 1,6-4,8 мг/кг (дети) и 4,8-8 мг/кг (взрослые)[102].
Меры предосторожности

Отравления грибами часто возникают ввиду неправильного сбора смертельно ядовитых грибов, приняв последние за съедобные. Наибольшую опасность представляет бледная поганка, её плодовые тела могут накапливать высокие дозы смеси чрезвычайно токсичных соединений (аматоксины и фаллотоксины), которые не разрушаются при термической обработке, замораживании и высушивании[103]. Интересной особенностью плодовых тел этого гриба является приятный вкус. Помимо этого манифестация отравления (первые симптомы) наступает после продолжительного латентного периода, что приводит к серьёзным последствиям с высокой долей вероятности летального исхода, особенно опасно данное отравление для детей.
Во избежание интоксикаций ядовитыми грибами ни в коем случае не рекомендуется сбор плодовых тел неизвестных видов грибов, осуществление сбора проводить только с опытными грибниками.
Фитотоксины

Фитотоксины (от др.-греч. φυτόν — «растение» и τοξικός — «яд», «ядовитый») — токсины, которые образуются и продуцируются растениями. Обычно такие растения принято называть ядовитыми[105]. Являясь продуктами метаболизма растений, фитотоксины порой выполняют защитные функции, отпугивая от них потенциальных консументов (защищают от поедания). Фитотоксины включают большую группу разнообразных органических соединений, как низко-, так и высокомолекулярные: непротеиногенные аминокислоты, гликозиды, алкалоиды, стероиды, изопреноиды, фенольные соединения, лектины, и т. д. Но наиболее встречаемыми и разнообразными по структуре считают алкалоиды.
Фитотоксины проявляют свойства биологических контаминантов.
Все фитотоксины в какой-то степени представляют опасность для здоровья и жизни человека.
Алкалоиды
Алкалоиды — весьма обширный класс азотсодержащих органических соединений, оказывающих самое различное действие на организм человека. Это и сильнейшие яды, и полезные лекарственные средства (обладают сильными физиологическими воздействиями)[106].
- Некоторые алкалоиды
 Атропин — алкалоид тропанового ряда, впервые обнаружен в ягодах Красавки обыкновенной или белладонны (от лат. Atrópa belladónna), также встречается в разных частях белены (Hyoscyamus niger) и некоторых видах дурмана (Datura stramonium). Является неселективным мускариновым холиноблокатором (холинолитик), блокирует м-холинорецепторы постганглионарных парасимпатических нервов, делая их нечувствительными к ацетилхолину. Такое воздействие приводит к мидриазу (расширение зрачка), атропин снижает слюновыделение (сухость во рту), происходит ослабление тонуса гладких мышц внутренних органов, например — броноходилатация (расширение просвета бронхов). Он усиливает сердцебиение (тахикардия) и вентиляцию лёгких, вызывает покраснение кожи лица (т.н. румянец), возбуждает ЦНС (возможны бред, галлюцинации, при сильном отравлении возможны психозы), данные свойства белладоны широко использовали богатые итальянские дамы. Опасным проявлением отравления является паралич дыхания, следствием которого является летальный исход. Отравление происходит при поедании или втирании ягод белладоны. ЛД50 = 300-400 мг/кг
Атропин — алкалоид тропанового ряда, впервые обнаружен в ягодах Красавки обыкновенной или белладонны (от лат. Atrópa belladónna), также встречается в разных частях белены (Hyoscyamus niger) и некоторых видах дурмана (Datura stramonium). Является неселективным мускариновым холиноблокатором (холинолитик), блокирует м-холинорецепторы постганглионарных парасимпатических нервов, делая их нечувствительными к ацетилхолину. Такое воздействие приводит к мидриазу (расширение зрачка), атропин снижает слюновыделение (сухость во рту), происходит ослабление тонуса гладких мышц внутренних органов, например — броноходилатация (расширение просвета бронхов). Он усиливает сердцебиение (тахикардия) и вентиляцию лёгких, вызывает покраснение кожи лица (т.н. румянец), возбуждает ЦНС (возможны бред, галлюцинации, при сильном отравлении возможны психозы), данные свойства белладоны широко использовали богатые итальянские дамы. Опасным проявлением отравления является паралич дыхания, следствием которого является летальный исход. Отравление происходит при поедании или втирании ягод белладоны. ЛД50 = 300-400 мг/кг Структурная формула кониина — алкалоида, производного пиперидина. Встречается в листьях, плодах и корнях растения рода болиголов (Conīum). Очень токсичен, LD50 = 1 мг/кг (перорально). Отравление наступает быстро, так как он легко проникает через органы ЖКТ в кровь. Кониин обладает сильным нейротропным воздействием, сначала поражает двигательные и чувствительные нервные окончания, далее, затрагивая нервы и органы ЦНС, вызывает так называемый «восходящий паралич». Отравление кониином возможно при ошибочном сборе ядовитых частей болиголова, приняв их за съедобные (например, корни сходны с корневищем хрена, листья очень похожи на листья петрушки, а плоды могут быть неправильно применены как плоды аниса)
Структурная формула кониина — алкалоида, производного пиперидина. Встречается в листьях, плодах и корнях растения рода болиголов (Conīum). Очень токсичен, LD50 = 1 мг/кг (перорально). Отравление наступает быстро, так как он легко проникает через органы ЖКТ в кровь. Кониин обладает сильным нейротропным воздействием, сначала поражает двигательные и чувствительные нервные окончания, далее, затрагивая нервы и органы ЦНС, вызывает так называемый «восходящий паралич». Отравление кониином возможно при ошибочном сборе ядовитых частей болиголова, приняв их за съедобные (например, корни сходны с корневищем хрена, листья очень похожи на листья петрушки, а плоды могут быть неправильно применены как плоды аниса) Стрихнин — алкалоид индолового ряда, впервые обнаружен и выделен из рвотных орешков — семян растения чилибу́хи (Strychnos nux-vomica). Чрезвычайно токсичное вещество, нейротоксичной природы, является антагонистом глициновых рецепторов ЦНС. При отравлении симптоматическая картина напоминает столбняк: происходит возбуждение ЦНС, risus sardonicus, возможны генерализованные судороги мышц — тетания, дыхательный паралич и смерть от остановки дыхания или асфиксии[107]. LD50 ~ 1 мг/кг
Стрихнин — алкалоид индолового ряда, впервые обнаружен и выделен из рвотных орешков — семян растения чилибу́хи (Strychnos nux-vomica). Чрезвычайно токсичное вещество, нейротоксичной природы, является антагонистом глициновых рецепторов ЦНС. При отравлении симптоматическая картина напоминает столбняк: происходит возбуждение ЦНС, risus sardonicus, возможны генерализованные судороги мышц — тетания, дыхательный паралич и смерть от остановки дыхания или асфиксии[107]. LD50 ~ 1 мг/кг
Гликозиды
Гликозиды — представляют собой органические соединения, состоящих из двух компонентов — одного или более углеводного остатка (молекул пиранозного или фуранозного цикла) и неуглеводного компонента или агликона. Гликозиды разнообразны по строению и образуют довольно обширную группу производных углеводов. Многие растительные гликозиды ядовиты, обладают высокой биологической активностью, особенно на миокард сердца, поэтому некоторые из них, например, ландыша, наперстянки или строфанта (Strophanthus kombe) используют в качестве лекарственных препаратов в очень низких концентрациях (так называемая группа сердечных гликозидов)[108].
Цианогенные гликозиды

Цианогенные гликозиды — это гликозиды некоторых цианогенных альдегидов и кетонов, которые при ферментативном или кислотном гидролизе выделяют очень ядовитую синильную кислоту HCN, вызывающую общетоксическое и поражение нервной системы.
Из представителей цианогенных гликозидов целесообразно отметить линамарин, содержащийся в белой фасоли, льне и маниоке, и амигдалин, который обнаружен в косточках некоторых растений семейства розовых (Rosaceae) — миндаля (до 8 %), персиков, слив, абрикос (от 4 до 6 %).
Амигдалин представляет собой сочетание дисахарида генциобиозы и агликона, включающего остаток синильной кислоты и бензальдегида.
Линамарин является гликозидом ацетонциангидрина, в качестве углеводной части выступает молекула глюкозы.
Лектины

Лектины — группа веществ гликопротеидной природы с молекулярной массой от 60 до 120 тысяч дальтон. Они широко распространены в семенах и других частях растений. Лектины обнаружены в бобовых, арахисе, проростках растений, а также в икре рыб.
Лектины обладают способностью: повышать проницаемость стенок кишечника для чужеродных веществ; нарушать всасывание нутриентов; вызывать агглютинацию (склеивание) эритроцитов крови. С этим связано их негативное действие при высоких концентрациях. Некоторые лектины чрезвычайно токсичны, например, лектин из семян клещевины (Ricinus communis) — рицин[110], а также лектины некоторых животных и микроорганизмов, в частности холерный токсин.
Непротеиногенные аминокислоты
Некоторые непротеиногенные аминокислоты являются токсичными, из-за их способности к имитации структур протеиногенных аминокислот, такие, как тиализин. Другие же подобны структурам аминокислотам-нейромедиаторам, они обладают нейротоксичностью, например, квискваловая кислота, канаванин и азетидин-2-карбоновая кислота[111].
-Azetidine-2-carboxylic_acid-Structural_formula_V1.svg.png) Азетидин-2-карбоновая кислота (сокр. Aze) — непротеиногенная аминокислота, структурный аналог и антагонист пролина. Обладает токсичностью, ошибочно встраивается в белки организма. Неправильное включение Aze в человеческие белки может изменить структуру коллагена, кератина, гемоглобина и фолдинг белков[112]. Обнаружен в ландыше майском (Convallaria majalis) и спарже, также встречается во многих растениях семейства бобовых (Fabaceae), в небольших количествах обнаруживается в столовой и сахарной свёкле[113].
Азетидин-2-карбоновая кислота (сокр. Aze) — непротеиногенная аминокислота, структурный аналог и антагонист пролина. Обладает токсичностью, ошибочно встраивается в белки организма. Неправильное включение Aze в человеческие белки может изменить структуру коллагена, кератина, гемоглобина и фолдинг белков[112]. Обнаружен в ландыше майском (Convallaria majalis) и спарже, также встречается во многих растениях семейства бобовых (Fabaceae), в небольших количествах обнаруживается в столовой и сахарной свёкле[113]. Гипоглицин A — непротеиногенная аминокислота, фитотоксин, содержится в незрелых плодах и семенах Аки (Blighia sapida) и личи (Litchi chinensis)[114]. Высокотоксичен, вызывает специфическое заболевание «Ямайскую рвотную болезнь», сопровождаемое сильнейшей интоксикацией и гипогликемией[115].
Гипоглицин A — непротеиногенная аминокислота, фитотоксин, содержится в незрелых плодах и семенах Аки (Blighia sapida) и личи (Litchi chinensis)[114]. Высокотоксичен, вызывает специфическое заболевание «Ямайскую рвотную болезнь», сопровождаемое сильнейшей интоксикацией и гипогликемией[115].
Канаванин

Канаванин — непротеиногенная аминокислота, структурный аналог аргинина. Обнаружен в некоторых растениях семейства бобовых (например, в семенах и ростках люцерны), при употреблении в больших количествах у человека может вызвать симптомы системной красной волчанки[116].
Механизм токсичности канаванина заключается в том, что организмы, потребляющие его, обычно по ошибке включают его в свои собственные белки вместо L-аргинина (у животных и человека аминоацил-тРНК-синтетазы не обладают высокой специфичностью к L-аргинину, в отличие от растений), тем самым синтезируются структурно аберрантные («неправильные») белки, которые не могут функционировать должным образом.
Меры предосторожности

Ядовитые растения часто путают с неядовитыми, ввиду морфологических сходств некоторых частей. Особенно часто сходства наблюдаются в строении побегов, цветков или плодов. Неопытные сборщики могут легко перепутать несъедобные и ядовитые растения с лекарственными и используемых в пищу, и тем самым подвергнут своё или здоровье близких риску отравления или даже смерти. Например, ягоды очень ядовитого и смертельно опасного вороньего глаза имеют большое сходство с ягодами черники. Часто плоды ядовитых растений имеют прекрасный запах и вполне съедобный вид, однако, такая обманчивость может быть очень опасной, как, например, с плодами манцинеллового дерева[117] или ягодами клещевины. Поэтому не следует собирать ягоды, плоды, семена или другие части растений, для использования в гастрономических целях, если они неизвестны и встречаются впервые.
Некоторые ядовитые растения
В галереи представлены те растения или их части, которые могут быть ошибочно использованы в гастрономических целях.
- Ядовитые растения
 Иллюстрация Нарцисса поэтического (Narcissus poeticus), ядовитого растения из семейства амариллисовых. Особенно ядовитыми частями растения являются луковицы, содержащие фитотоксин — алкалоид нарциссин. Луковицы нарцисса имеют большое сходство с луком-пореем случайное употребление приводит к нарушениям со стороны ЖКТ (диспепсию, рвоту, абдоминальную боль диарею), неврологические симптомы, включая тетанию, судороги и паралич, при употреблении большего количества луковиц возможен летальный исход
Иллюстрация Нарцисса поэтического (Narcissus poeticus), ядовитого растения из семейства амариллисовых. Особенно ядовитыми частями растения являются луковицы, содержащие фитотоксин — алкалоид нарциссин. Луковицы нарцисса имеют большое сходство с луком-пореем случайное употребление приводит к нарушениям со стороны ЖКТ (диспепсию, рвоту, абдоминальную боль диарею), неврологические симптомы, включая тетанию, судороги и паралич, при употреблении большего количества луковиц возможен летальный исход Вороний глаз четырёхлистный (Pāris quadrifōlia) — смертельно ядовитое растение из семейства Мелантиевые. Опасность растения представляют плоды (содержат сильно ядовитый гликозид паридин и сапонин паристифин), похожие на ягоды черники или голубики, приняв их за съедобные происходит сильнейшее отравление, особенно им подвержены дети. Паридин обладает ярко выраженной кардиотоксичностью, подобно конваллятоксину действует на миокард сердца. Симптомы отравления: боли в животе, диарея, рвота, приступы головокружения, судороги, нарушение работы сердца вплоть до его остановки
Вороний глаз четырёхлистный (Pāris quadrifōlia) — смертельно ядовитое растение из семейства Мелантиевые. Опасность растения представляют плоды (содержат сильно ядовитый гликозид паридин и сапонин паристифин), похожие на ягоды черники или голубики, приняв их за съедобные происходит сильнейшее отравление, особенно им подвержены дети. Паридин обладает ярко выраженной кардиотоксичностью, подобно конваллятоксину действует на миокард сердца. Симптомы отравления: боли в животе, диарея, рвота, приступы головокружения, судороги, нарушение работы сердца вплоть до его остановки Болиголов пятнистый (Conīum maculātum) очень ядовитое растение из семейства Зонтичных. Болиголов содержит в листьях, корнях и плодах чрезвычайно токсичное вещество, нейротоксин — кониин. Отравление болиголовом происходит при неправильном сборе его частей, приняв последние за съедобные, например, листья похожи на листья петрушки, а плоды на анисовые семена. Картина отравления сходна с воздействием яда кураре или никотина. Основные симптомы отравления: тошнота, слюнотечение, головокружение, нарушение глотания, речи, побледнение кожи. Начальное возбуждение сопровождается судорогами и переходит в угнетение ЦНС. Характерным является так называемый восходящий паралич, начинающийся с нижних конечностей, сопровождающийся потерей кожной чувствительности. Зрачки расширены, на свет не реагируют. Нарастающее удушье может привести к остановке дыхания
Болиголов пятнистый (Conīum maculātum) очень ядовитое растение из семейства Зонтичных. Болиголов содержит в листьях, корнях и плодах чрезвычайно токсичное вещество, нейротоксин — кониин. Отравление болиголовом происходит при неправильном сборе его частей, приняв последние за съедобные, например, листья похожи на листья петрушки, а плоды на анисовые семена. Картина отравления сходна с воздействием яда кураре или никотина. Основные симптомы отравления: тошнота, слюнотечение, головокружение, нарушение глотания, речи, побледнение кожи. Начальное возбуждение сопровождается судорогами и переходит в угнетение ЦНС. Характерным является так называемый восходящий паралич, начинающийся с нижних конечностей, сопровождающийся потерей кожной чувствительности. Зрачки расширены, на свет не реагируют. Нарастающее удушье может привести к остановке дыхания Зрелые ягоды волчеягодника обыкновенного (Dáphne mezéreum) содержат в себе большое количество фитотоксинов, включая гликозид дафнин (является антивитамином К, вызывает геморрагии и снижает свёртываемость крови) и мезереин (ирритант, сильно раздражает кожу и слизистые оболочки)[118]. Поедание ягод волчеягодника в количестве более 3 г (в среднем 6-10 ягод) смертельно опасно
Зрелые ягоды волчеягодника обыкновенного (Dáphne mezéreum) содержат в себе большое количество фитотоксинов, включая гликозид дафнин (является антивитамином К, вызывает геморрагии и снижает свёртываемость крови) и мезереин (ирритант, сильно раздражает кожу и слизистые оболочки)[118]. Поедание ягод волчеягодника в количестве более 3 г (в среднем 6-10 ягод) смертельно опасно Нераскрывшийся плод Аки (Blighia sapida) содержит непротеиногенную аминокислоту гипоглицин[119] — высокотоксичное вещество, которое может привести к сильному отравлению, сопровождаемой упорной рвотой и гипогликемией, к так называемой «Ямайской рвотной болезни»
Нераскрывшийся плод Аки (Blighia sapida) содержит непротеиногенную аминокислоту гипоглицин[119] — высокотоксичное вещество, которое может привести к сильному отравлению, сопровождаемой упорной рвотой и гипогликемией, к так называемой «Ямайской рвотной болезни»- Клещевина обыкновенная (Ricinus communis), красивое декоративное растение, однако, её семена содержат сильнейший белковый фитотоксин — рицин. При поедании семян возникает сильнейшая интоксикация с гемолитическим и геморрагическим синдромом, поражается кишечник и сосуды (нарушается целостность стенок, образуются тромбы, снижается кровоток итд.), как следствие гемолитическая анемия, угнетается деятельность ЦНС, возникает тотальное падение артериального давления, летальный исход происходит почти в 100% случаев интоксикаций. Сырьё или жмых, контаминированный рицином также смертельно опасен и для домашних животных (крупный и мелкий рогатый скот, лошади)
Зоотоксины и токсины морских беспозвоночных
Зоотоксины от (др.-греч. ζῷον — «животное», «живое существо» и τοξικός — «ядовитый») — токсины, продуцируемые животными, в частности позвоночными (рыбы, земноводные, рептилии, птицы, млекопитающие), такие животные являются ядовитыми по аналогии с растениями. Токсины морских беспозвоночных рассматриваются обычно отдельно. Среди зоотоксинов, наиболее часто встречаемые контаминанты это токсины рыб.
Нейротоксины моллюсков

Отравление нейротоксичными моллюсками связано с употреблением в пищу мидий, устриц, морских гребешков или сердцевидок. Двустворчатые моллюски становятся ядовитыми после питания определёнными динофлагеллятами или цианобактериями. Парализующим токсином моллюска (PSP) является сакситоксин.
Действие сакситоксина проявляется у людей в виде сердечно-сосудистого коллапса и паралича дыхания. Он блокирует распространение нервных импульсов без деполяризации, и нет никакого известного противоядия. Он устойчив к высокой температуре, растворим в воде, не разрушается при варке. Он может быть разрушен кипячением в течение 3-4 ч при pH 3,0.
Признаки синдрома PSP развиваются в течение 2 ч после приёма пищи ядовитых моллюсков, они характеризуются парестезией (покалывание, нечувствительность или жжение), которая начинается со рта, губ и языка, которая позднее распространяется по лицу, голове и шее к кончикам пальцев руки ног. Смертность по разным данным колеблется от 1 до 22 %.
Тетродотоксин

Тетродотоксин представляет собой органическое вещество, небелковый токсин с сильнейшим нервно-паралитическим действием, плохо растворим в воде, хорошо в неполярных органических растворителях. Впервые был обнаружен и выделен в 1909 году японским химиком Ёшизуми Тахара[120] из печени бурой собаки-рыбы (Takifugu rubripes), входящей в отряд четырёхзубообразные (Tetraodontiformes), откуда и происходит название токсина. Смертельная доза для человека составляет менее чем 0,1 мг. Токсин накапливается главным образом в печени, яичниках и икре рыб семейства иглобрюхие, включая и смертоносную собаку-рыбу. Исследования показали, что иглобрюхи не способны вырабатывать нейротоксин, а лишь аккумулируют его в своём организме. Изначально тетродотоксин вырабатывается морскими бактериями, которые затем поедаются разнообразными живыми организмами.
Токсическое воздействие

Тетродотоксин относится к сильнейшим природным нейротоксинам. Его действие обусловлено воздействием на натриевые каналы нейронов, ингибируя их путём изменения структуры (не позволяет проникать ионам натрия внутрь клеток), токсин делает процесс передачи нервного импульса по нервным волокнам невозможным, что приводит к параличу мышц[121]. Токсин легко всасывается в кишечнике в кровь, проникает через практически любые тканевые барьеры, во все внутренние органы, включая головной мозг, может накапливаться в сердце и почках.
Картина отравления сходна с сакситоксином. Сначала развивается онемение, зуд языка, нёба, губ, возникают боли в животе, тошнота, рвота, понос, затем происходит тремор и угнетение мышечного движения, дисфагия, афония и потеря сознания, смерть возникает в результате дыхательной недостаточности, вызванной параличом мышц участвующих в дыхании и поражении блуждающего нерва (n.vagus). Противоядия не существует. Активный антагонист более токсичный батрахотоксин, использовать которого не является целесообразным (минимальная летальная доза составляет порядка 20 мкг). Лечение при отравлении только симптоматическое, единственная возможность спасти отравившегося человека состоит в искусственном поддержании работы дыхательной и кровеносной систем до тех пор, пока не закончится действие яда. Минимальные концентрации токсина, вызывающие токсические эффекты составляют порядка 0,01-0,02 мг.
Меры предосторожности

Мясо иглобрюхов в Японии и странах Юго-Восточной Азии считается деликатесным, знаменитое блюдо фугу, приготавливают именно из них, особенно вкусным получается из мяса бурого скалозуба. Но несмотря на все необходимые меры безопасности приготовления этого экзотического блюда с эффектом онемения губ и языка, каждый год в Японии регистрируют несколько десятков отравлений. В странах Юго-Восточной Азии (особенно в Таиланде) количество отравлений намного больше (до нескольких сотен) учитывая, что в большинстве случаев рыбы вылавливаются и приготавливаются без должных мер безопасности, имеется высокий риск смертельного отравления. Вследствие этого не рекомендуется приобретать мясо фугу на рыбных рынках.
 Тарелка с fugu sashimi
Тарелка с fugu sashimi- Fugu no Shirako
- Fugu no ransou nukazuke, Яичники иглобрюха, маринованные в пасте из рисовых отрубей
Сигуатоксин и сигуатера

Сигуатера (или чигуатера) — является острым отравлением, которое вызывается самыми различными тропическими морскими рифовыми или прибрежными рыбами, в телах которых накапливается токсин, выделяемый динофлагеллятами вида Gambierdiscus toxicus (сигуатоксин). Установлено, что это заболевание могут вызывать рыбы более 300 видов. Очевидно, любая морская рыба при соответствующих обстоятельствах может содержать такой яд, так как обычно рыб всех этих видов едят и считают вполне съедобными. Полагают, что эти рыбы становятся ядовитыми, когда поедают ядовитую пищу, как говорилось выше[122].
Сигуатера является серьёзной проблемой в некоторых районах, вроде центральной и южной частей Тихого океана и Вест-Индии. К сожалению, её нельзя предвидеть, и потому с ней чрезвычайно трудно бороться. Известно, что рыбы внезапно становились несъедобными[122].
Механизм токсического воздействия и клинические проявления

Сигуатоксин — сложное органическое вещество, относится к так называемым полициклическим полиэфирам, является сильным нейротоксином, обладает липофильностью, проходит через ГЭБ, тем самым, легко воздействует на органы ЦНС и процессы передачи нервных импульсов. Попавший в организм токсин селективно нарушает функцию натриевых каналов в мембранах нервных и мышечных клеток, влияет на передачу сигнала в синапсах. К сигуатоксину наиболее чувствительны теплокровные животные и человек. Существует несколько представителей сигуатоксина. ЛД50 для сигуатоксина CTX1B составляет 0,25 мкг/кг (мыши, внутрибрюшинно)[123].
Манифестация сигуатеры происходит в течение 1-6 часов. При отравлении рыбой, содержащий сигуатоксин наблюдаются следующие симптомы: со стороны желудочно-кишечного тракта, такие как боли в животе, рвота, диарея, но могут быть и неврологические расстройства, в том числе онемение языка и губ, зуд, светобоязнь, металлический вкус во рту, замена ощущений тепла и холода на противоположные. Однако в редких случаях могут иметь место нарушения со стороны дыхательной и сердечно-сосудистой систем, которые могут привести к смерти.
Лечение только симптоматическое, антидота нет. Несмотря на отсутствие антидота, летальность при таких отравлениях рыбой относительно низка, умирает ~ 7 % отравившихся. Если пострадавший выживет, выздоровление идёт чрезвычайно медленно. При сильном отравлении для полного выздоровления может потребоваться много месяцев или даже лет[122].
Меры предосторожности

Ядовитую рыбу нельзя распознать по внешнему виду. Кроме того, нет простого химического способа обнаружения яда[122]. Наиболее надёжный метод — приготовление тканевых вытяжек, которые впрыскивают в брюшную полость мышам, или скармливание внутренностей и мяса кошкам и собакам; потом следят, не появятся ли у этих животных симптомы интоксикации. Никогда не следует есть внутренностей (печень и кишечник) тропических морских рыб. Икра и молоки большинства морских рыб тоже потенциально опасны, и в некоторых случаях могут стать причиной быстрой смерти. Рыб, которые необычно толсты для своих размеров, надо есть с осторожностью. Это особенно относится к барракуде (Sphyraena), каранксам (Caranx) и групперам (Epinephelus) в период их размножения. Если человек голодает и вынужден есть рыбу, в доброкачественности которой не уверен, рекомендуется нарезать рыбу тонкими ломтиками и вымачивать в пресной или солёной воде не менее 30 минут, несколько раз меняя воду. Не варите рыбу в той воде, в которой её промывали. Яд немного растворим в воде и при промывке отчасти вымывается. Если сомнительную рыбу варят, воду следует вылить. Надо подчеркнуть, что при обычных способах приготовления пищи сигуатоксин не разрушается (термостабилен)[124], а лишь незначительно ослабляется. Мнение местных жителей о съедобности тропических морских рыб часто бывает противоречивым и ошибочным, особенно если они живут в этой местности недавно. Не забывайте, что рыба, съедобная в одном районе, может оказаться смертельно ядовитой в другом[122].
Скумбриевое отравление или отравление, вызванное гистамином

Данная интоксикация, вызванная потреблением рыбы или рыбопродуктов семейства скумбриевых, содержащих высокие уровни гистамина, часто упоминается как «скумбриевое отравление» или «скомброид»[22]. Среди скумбриевых рыб — тунец, макрель, скумбрия и другие. В одном сообщении гистаминовое отравление было связано с рыбой парусником, не относящейся к скумбриевым рыбам. В отличие от многих видов пищевых отравлений, скумбриевое отравление не вызывается попаданием в организм возбудителя[125].
Гистамин образуется в результате бактериального декарбоксилирования (ферментативный процесс) большого количества аминокислоты гистидина в мышцах этой группы рыб.

Достаточные уровни гистамина могут быть образованы в продукте с хорошей органолептикой, так что в итоге «скумбриевое отравление» может быть вызвано как свежей, так и испорченной рыбой.

Бактериями, чаще всего связанными с этим синдромом, являются Morganella spp., особенно M. morganii, у которых все штаммы образуют гистамин в количествах > 5000 ppm. Среди других бактерий, у которых обнаружены гистидиндекарбоксилазы (шифр КФ 4.1.1.22), Raoulella planticola и R. ornithinolytica, Hafnia alvei, Citrobacter freundii, Clostridium perfringens, Enterobacter aerogenes, Vibrio alginolyicus и Proteus spp. Выделенный штамм Morganella morganii из альбакора, хранившегося с нарушением температурного режима, образовал 5253 ppm гистамина в вытяжке из тунца при 25 °C и 2769 ppm при 15 °C. Роста микроорганизма и образования гистамина не наблюдалось при 4 °C. P. phosphoreum образует гистамин при температурах ниже 10 °C.
Образованию гистамина способствует низкий показатель pH, но чаще это происходит, когда продукты хранятся при температуре, превышающей температуры холодильника. Самая низкая температура для образования существенных уровней была 30 °C для H. alvei, C. freundii и E. coli и 15 °C для двух штаммов M. morganii. Синдром связали с употреблением свежей или приготовленной рыбы определённого типа; симптомы проявляются от нескольких минут до 3 ч после приёма токсичной пищи, в большинстве случаев они проявляются в течение 1 ч. Типичные симптомы заключаются в приливе крови к лицу и шее, сопровождаемом интенсивным повышением температуры, общим дискомфортом и диареей. Часто за ними появляется сыпь на лице и шее. Прилив крови сопровождается интенсивной пульсирующей головной болью, приводящей к непрерывной тупой боли. Другие симптомы включают головокружение, зуд, слабость, жжение рта и горла и неспособность глотать. Минимальный уровень гистамина, способный вызвать эти симптомы, равен 100 мг/дл. Большое число M. morganii в рыбе, относящейся к видам, способным вызывать этот синдром и содержащей гистамин на уровне больше, чем 10 мг/дл, считают существенными в зависимости от качества продукта.
Первые 50 инцидентов в Великобритании произошли между 1976 и 1979 гг., 19 произошли в 1979 г. Консервированная и копчёная макрель были самыми распространёнными рыбами, вызвавшими интоксикацию, наряду с бонитой, килькой и сардинами. Самым частым симптомом среди 196 случаев была диарея.
Меры предосторожности

Чтобы избежать отравления высокими концентрациями гистамина скумбриевых рыб, их необходимо хранить при температурах ниже 0 °C. Свежепойманную рыбу лучше употреблять сразу[122]. В большинстве случаев скумбриевые отравления возникают, если рыба хранилась при температурах выше 5 °С, замороженная рыба с соблюдением всех требований пищевой безопасности, пригодна к употреблению в течение нескольких недель после отлова. Если рыба имеет неприятный запах, после долгого хранения (более месяца) и процесса разморозки, то лучше отказаться от её употребления, однако, даже при отсутствии запахов не исключается интоксикация. Термическая обработка не уменьшает количества гистамина в контаминированной рыбе[22]. Лица, с непереносимостью, бронхиальной астмой и/или аллергией на скумбриевых рыб и рыбную продукцию, имеют высокие риски к возникновению тяжёлой формы интоксикации.
Самостоятельное лечение скумбриевоего отравления проводится только при лёгкой форме, сопровождаемой симптомами схожих с аллергической реакцией (жжением, зудом, покраснением лица, ангионевротическим отёком). При более тяжёлом протекании отравления, когда наблюдаются гипертермия, тахикардия, падение артериального давления (гипотония), бронхоспазм и анафилаксия — немедленно обратиться за медицинской помощью!
Простейшие как контаминанты пищевых продуктов
Токсоплазма и токсоплазмоз

Токсоплазмоз. Эта болезнь вызывается токсоплазмой Toxoplasma gondii, кокцидиозным простейшим, которое является облигатным внутриклеточным паразитом. Родовое название основывается на характерной форме амёбной стадии простейшего (от греч. τόξο — токсо, «дуга»). Впервые он был выделен в 1908 г. от африканского грызуна гонди, откуда и пошло его видовое название. В большинстве случаев попадание ооцист T. gondii в организм человека алиментарным путём не вызывает характерных симптомов, или инфекция является самоизлечивающейся. В этих случаях простейшее инцистируется и становится латентным. Однако когда иммунокомпетентный статус ослаблен, опасный для жизни токсоплазмоз проявляется в результате обострения латентной инфекции. Домашние и дикие кошки — единственные окончательные хозяева (носители) кишечной или половой фазы этого организма, что делает их первичными источниками токсоплазмоза человека. Обычно болезнь передаётся от кошки к кошке, но фактически все позвоночные животные восприимчивы к ооцистам, распространяющимся кошками. Доза в 100 ооцист может вызвать клинический токсоплазмоз у человека, и ооцисты могут оставаться жизнеспособными более года в тёплой сырой окружающей среде[127]. Свиньи — главный источник токсоплазмоза среди животной пищи для человека.
Токсоплазмоз у людей может быть предотвращён, если избегать экологического загрязнения кошачьими фекалиями из окружающей среды (из кошачьих туалетов, например) и потреблять мясо и мясные продукты, которые не содержат жизнеспособных цист. Цисты T. gondii могут быть разрушены термообработкой мяса выше 60 °C или облучением на уровне 300 Гр или выше. Паразит может быть инактивирован замораживанием, но так как результаты являются переменными, замораживание не гарантирует инактивации ооцисты.
Дизентерийная амёба и амёбиаз

Entamoeba histolytica внедряется внутрь при проглатывании цист, которые передаются в основном фекально-оральным путём[128] через контаминированную пищу и воду. Резервуара среди животных не существует. Проглоченные внутрь цисты дифференцируются в трофозоиты (бесполая вегетативная стадия и/или форма) в подвздошной кишке, но, как правило, колонизируют слепую и толстую кишки. Организм необычен тем, что является анаэробным, и трофозоиты не имеют митохондрий. Это — аэротолерантный анаэроб, которому необходима глюкоза или галактоза в качестве главного дыхательного субстрата[129]. Трофозоиты E. histolytica имеют размер в диапазоне от 10 до 60 мкм, тогда как размеры шаровидных цист обычно составляют от 10 до 20 мкм. Трофозоиты подвижны, а цисты — нет. Хотя трофозоиты не выживают в условиях окружающей среды, инцистированные формы могут сохранить жизнеспособность целых 3 месяца в осадке сточных вод[130].
Трофозоиты внедряются в эпителий толстой кишки и выделяют ферменты, вызывающие локальный некроз. В этом участке развивается небольшой очаг воспаления. Когда поражение достигает мышечного слоя, образуются типичные колбообразные язвы, которые могут разрушать кишечный эпителий на большом протяжении. Поражение подслизистого слоя приводит к инвазии трофозоитов в кровь через систему портальной вены. Наиболее часто поражается печень, где в абсцессах обнаруживают трофозоитные формы. Миграция трофозоитов в другие органы (наиболее часто в брюшную полость, лёгкие или головной мозг) и ткани нередко вызывают перитонит[131], плеврит и энцефалиты. Особенно опасны энцефалиты, которые могут привести к летальному исходу.
Острый кишечный амёбиаз протекает как дизентерия[131](то есть диарея с примесями крови и слизи). Сопровождается дискомфортом в нижней части живота (абдоминальная боль), метеоризмом и болезненными позывами на дефекацию. При хроническом амёбиазе симптомы слабо выражены. Наблюдаются редкие случаи диареи, потеря веса и утомляемость. Примерно у 90 % пациентов инфекции проходят бессимптомно[128] , но они могут быть носителями, в фекалиях содержатся цисты, которые могут быть переданы другим людям. Человек с этой болезнью может передавать до 4,5 × 107 цист каждый день. У некоторых пациентов в слепой кишке или ректосигмоидной области толстой кишки образуются гранулематозные поражения, называемые амёбной гранулёмой. Эти поражения могут напоминать аденокарциному толстой кишки, но их необходимо чётко различать. Считается, что 10 % населения в мире заражены E. histolytica и что каждый год происходят до 100 млн случаев амёбного колита или абсцессов печени.
С целью профилактики необходимо избегать употребления загрязнённых фекальными массами воды и пищи и соблюдать правила личной гигиены, в первую очередь мыть руки. Очистка муниципального водоснабжения, как правило, достаточно эффективна, но, тем не менее, вспышки амёбиаза у городских жителей всё ещё происходят в случаях сильного загрязнения. Использование нечистот (человеческих фекалий) в качестве удобрения почвы должно быть запрещено. В районах эндемичных инфекций овощи необходимо подвергать термической обработке.
Химические контаминанты

_-_Ukraine_(42185631740).jpg)
К химическим или антропогенным контаминантам относят разнообразные химические соединения или их смеси, чужеродного происхождения (являются результатом деятельности человека — ксенобиотиками), обладающие высокой биологической активностью, присутствие которых в пищевых продуктах может серьёзно ухудшить здоровье или даже привести к смерти людей. Подразделяются на две группы: неорганические и органические (составляют большую часть). Примером таких соединений являются метанол, аммиак, формальдегид, неорганические соединения мышьяка, соединения бериллия, некоторые соединения тяжёлых металлов (бария, кадмия, сурьмы, меди, свинца, таллия, ртути итд.), поверхностно-активные вещества (моющие средства или детергенты), пестициды (например, хлорорганические: группы альдрина, гексахлоран, ДДТ; паракват; фосфорорганические: фосдрин, ДФФ, тиофос и др.) и минеральные удобрения (основу, которых составляют нитраты), нефтепродукты (топливо, синтетические масла, бензол и ряд его производных, и другие ароматические соединения), органические растворители, фенолы и их производные (в частности, фенолформальдегидные смолы), эпоксид этилена, пластмассы и некоторые полимеры (ПВХ, поливинилиденхлорид и т. д.), искусственные пищевые и непищевые красители, лаки и краски, продукты сгорания биомассы, диоксины и диоксинподобные соединения, канцерогены антропогенного происхождения (полициклические ароматические углеводороды — бензпирен, бензантрацен, ДМБА, ароматические амины и др.) и многие другие.
- Некоторые химические контаминанты
 Бензпирен, широко распространённый полициклический ароматический углеводород, канцероген, мутаген. Образуется в результате процессов риформинга, происходящих при сжигании бытовых отходов, нефтепродуктов, табачного дыма, выхлопных газов, а также при термической обработке мяса[132][133]
Бензпирен, широко распространённый полициклический ароматический углеводород, канцероген, мутаген. Образуется в результате процессов риформинга, происходящих при сжигании бытовых отходов, нефтепродуктов, табачного дыма, выхлопных газов, а также при термической обработке мяса[132][133] Диметилртуть — ртутьорганическое соединение, чрезвычайно токсична[134], обладает биоаккумуляцией в морских животных, но особенно в рыбе, вызывает тяжёлое поражение ЦНС — болезнь Минамата
Диметилртуть — ртутьорганическое соединение, чрезвычайно токсична[134], обладает биоаккумуляцией в морских животных, но особенно в рыбе, вызывает тяжёлое поражение ЦНС — болезнь Минамата.png) Ацетат свинца (II), также известный, как «свинцовый сахар» (сладкий свинец). Кристаллическое вещество, напоминающее по виду кристаллы сахарозы, сладкое на вкус, с металлическим привкусом (сладость достигает 1,2 по относительной шкале сладости), хорошо растворяется в воде. Известен с древнейших времён, использовался в качестве подсластителя (так называемый дефрутум) в древнем Риме. В средние века использовался в качестве отравляющего вещества (из-за своего вкуса). Высокотоксичен, обладает нейротропным воздействием, смертельная доза для человека составляет менее 3500 мг (в пересчёте на свинец)
Ацетат свинца (II), также известный, как «свинцовый сахар» (сладкий свинец). Кристаллическое вещество, напоминающее по виду кристаллы сахарозы, сладкое на вкус, с металлическим привкусом (сладость достигает 1,2 по относительной шкале сладости), хорошо растворяется в воде. Известен с древнейших времён, использовался в качестве подсластителя (так называемый дефрутум) в древнем Риме. В средние века использовался в качестве отравляющего вещества (из-за своего вкуса). Высокотоксичен, обладает нейротропным воздействием, смертельная доза для человека составляет менее 3500 мг (в пересчёте на свинец) Пентахлорфенол — гербицид и десикант. Высокотоксичный. Обладает политропным воздействием на организм человека, в первую очередь поражает нервную систему и клетки миелоидной ткани. Сильный ирритант, при попадании на открытые участки кожи вызывает ожоги и поражения кожи, сходные с хлоракне. ЛД100 для человека составляет 1,5-1,7 г
Пентахлорфенол — гербицид и десикант. Высокотоксичный. Обладает политропным воздействием на организм человека, в первую очередь поражает нервную систему и клетки миелоидной ткани. Сильный ирритант, при попадании на открытые участки кожи вызывает ожоги и поражения кожи, сходные с хлоракне. ЛД100 для человека составляет 1,5-1,7 г Эндрин — хлорорганическое соединение с необычайно сильным инсектицидным действием, а также чрезвычайно токсичное вещество, вызывает сильнейшую интоксикацию, поражение печени и в особенности ЦНС[135]
Эндрин — хлорорганическое соединение с необычайно сильным инсектицидным действием, а также чрезвычайно токсичное вещество, вызывает сильнейшую интоксикацию, поражение печени и в особенности ЦНС[135] Бензол — простейший ароматический углеводород, один из самых распространённых ксенобиотиков. Токсичен, сильный канцероген, обладает мутагенными свойствами, миелотоксичен (поражает красный костный мозг)[136][137]
Бензол — простейший ароматический углеводород, один из самых распространённых ксенобиотиков. Токсичен, сильный канцероген, обладает мутагенными свойствами, миелотоксичен (поражает красный костный мозг)[136][137] Метанол — одноатомный спирт, сильный яд, вызывающий поражение зрения (дегенерацию зрительного нерва) в небольших дозах (5-15 мл), в больших кому и летальный исход (30-50 мл)[138][139]
Метанол — одноатомный спирт, сильный яд, вызывающий поражение зрения (дегенерацию зрительного нерва) в небольших дозах (5-15 мл), в больших кому и летальный исход (30-50 мл)[138][139] Нитрат натрия, вместе с нитратами калия и аммония, являются наиболее используемыми азотными удобрениями в сельском хозяйстве. Поступают в организм человека с овощами и в меньшей степени с фруктами и ягодами, которые накапливают нитраты в своих плодах. Овощи (особенно корнеплоды), содержащие большие количества нитрата натрия или других нитратов, вследствие окисления в организме человека, которое происходит под действием фермента бактерий кишечной микрофлоры — нитратредуктазы, до более токсичных нитритов, вызывают серьёзные расстройства и нарушения работы со стороны органов ЖКТ, а также метгемоглобинемию со стороны системы крови[140]
Нитрат натрия, вместе с нитратами калия и аммония, являются наиболее используемыми азотными удобрениями в сельском хозяйстве. Поступают в организм человека с овощами и в меньшей степени с фруктами и ягодами, которые накапливают нитраты в своих плодах. Овощи (особенно корнеплоды), содержащие большие количества нитрата натрия или других нитратов, вследствие окисления в организме человека, которое происходит под действием фермента бактерий кишечной микрофлоры — нитратредуктазы, до более токсичных нитритов, вызывают серьёзные расстройства и нарушения работы со стороны органов ЖКТ, а также метгемоглобинемию со стороны системы крови[140]![2,3,7,8-Тетрахлородибензодиоксин, сокр. ТХДД — органическое бифункциональное соединение (хлорорганический циклический эфир), представитель полихлорированных дибензодиоксинов (ПХДД), чрезвычайно токсичен, одно из самых токсичных веществ антропогенного происхождения (ЛД50 = 0,5 мкг/кг морская свинка (перорально)). Сильный мутаген, доказанный канцероген[страница не указана 643 дня], обладает ярко выраженным тератогенным воздействием, снижает деятельность эндокринной и репродуктивной системы](./2%252C3%252C7%252C8-tetrachlorodibenzo(b%252Ce)(1%252C4)dioxine_200.svg.png) 2,3,7,8-Тетрахлородибензодиоксин, сокр. ТХДД — органическое бифункциональное соединение (хлорорганический циклический эфир), представитель полихлорированных дибензодиоксинов (ПХДД), чрезвычайно токсичен, одно из самых токсичных веществ антропогенного происхождения (ЛД50 = 0,5 мкг/кг морская свинка (перорально)). Сильный мутаген, доказанный канцероген[141][страница не указана 643 дня], обладает ярко выраженным тератогенным воздействием, снижает деятельность эндокринной и репродуктивной системы
2,3,7,8-Тетрахлородибензодиоксин, сокр. ТХДД — органическое бифункциональное соединение (хлорорганический циклический эфир), представитель полихлорированных дибензодиоксинов (ПХДД), чрезвычайно токсичен, одно из самых токсичных веществ антропогенного происхождения (ЛД50 = 0,5 мкг/кг морская свинка (перорально)). Сильный мутаген, доказанный канцероген[141][страница не указана 643 дня], обладает ярко выраженным тератогенным воздействием, снижает деятельность эндокринной и репродуктивной системы
Тяжёлые металлы, мышьяк и их соединения
В так называемую группу тяжёлых металлов входят металлы с плотностью более 8 г/см3 (в некоторых источниках более 5 г/см3 или 3,5 г/см3[142][143]) и атомной массой более 40 а. е. м.. Однако с точки зрения медицины и экотоксикологии тяжёлыми металлами считаются те металлы, которые обладают высокой биологической активностью, в частности, токсичностью и способностью внедрения в пищевые цепи. К таким металлам относятся:
- Свинец
- Кадмий
- Ртуть
- Таллий
- Сурьма
- Барий
- Медь
- Хром
- Никель
- Цинк и их соединения.
Помимо данных элементов в группу входят: Мышьяк, Бериллий и Алюминий. Два последних элемента по плотности и атомной массе нельзя отнести к тяжёлым металлам, однако, бериллий является сильным канцерогеном (категория 1 по списку МАИР[144]), помимо этого, он и особенно его растворимые соединения обладают высокой токсичностью. Алюминий, несмотря на низкую токсичность способен к накоплению в организме до токсичных концентраций (более 0,1 г/кг), образуя нерастворимые и плохо выводимые соединения, например, фосфатные конкременты (камни) в почках. Барий имеет невысокое значение плотности (3,7 г/см3), но имеет высокотоксичные растворимые соединения, которые при контаминации пищевых продуктов вызывают серьёзные интоксикации организма человека.
![Свинец — наиболее распространённый тяжёлый металл.[источник не указан 732 дня] Свинец ядовит, а его растворимые (ацетат II) и летучие (тетраэтилсвинец) соединения высокотоксичны и смертельно опасны. Избыток свинца (сатурнизм) даже в небольших дозах, опасен для здоровья и негативно влияет на органы ЖКТ, ЦНС, в частности на кору головного мозга, а также нарушает обмен кальция. Особенно чувствительны к токсичному воздействию дети](./Lead_electrolytic_and_1cm3_cube.jpg) Свинец — наиболее распространённый тяжёлый металл. Свинец ядовит[145], а его растворимые (ацетат II) и летучие (тетраэтилсвинец) соединения высокотоксичны и смертельно опасны[146]. Избыток свинца (сатурнизм) даже в небольших дозах, опасен для здоровья и негативно влияет на органы ЖКТ, ЦНС, в частности на кору головного мозга, а также нарушает обмен кальция. Особенно чувствительны к токсичному воздействию дети
Свинец — наиболее распространённый тяжёлый металл. Свинец ядовит[145], а его растворимые (ацетат II) и летучие (тетраэтилсвинец) соединения высокотоксичны и смертельно опасны[146]. Избыток свинца (сатурнизм) даже в небольших дозах, опасен для здоровья и негативно влияет на органы ЖКТ, ЦНС, в частности на кору головного мозга, а также нарушает обмен кальция. Особенно чувствительны к токсичному воздействию дети Ртуть — единственный жидкий тяжёлый металл. Ртуть сильно ядовита, особенно опасны её пары. Все соединения ртути (в большей степени органические) сильные нейротропные яды, некоторые из них до сих пор используются в качестве инсектицидов в сельском хозяйстве (этилмеркурхлорид). При остром отравлении или меркурализме возникает поражение слизистых, глаз, рта, наблюдается высокая температура, тошнота, рвота и так называемая ртутная кайма. Хроническое отравление ртутью или её соединениями приводит к болезни Минамата, которое сопровождается глубоким поражением органов ЦНС, часто заканчивается летально
Ртуть — единственный жидкий тяжёлый металл. Ртуть сильно ядовита, особенно опасны её пары. Все соединения ртути (в большей степени органические) сильные нейротропные яды, некоторые из них до сих пор используются в качестве инсектицидов в сельском хозяйстве (этилмеркурхлорид). При остром отравлении или меркурализме возникает поражение слизистых, глаз, рта, наблюдается высокая температура, тошнота, рвота и так называемая ртутная кайма. Хроническое отравление ртутью или её соединениями приводит к болезни Минамата, которое сопровождается глубоким поражением органов ЦНС, часто заканчивается летально Кадмий и его соединения (особенно растворимые в воде) высокотоксичны. Кадмий нефротоксичен, он отрицательно влияет на обмен кальция[147], цинка, меди и железа в организме человека, избыток кадмия повышает риск возникновения заболеваний со стороны сердечно-сосудистой системы, злокачественных опухолей (канцероген) и остеопороза. Хроническое отравление кадмием приводит к болезни итай-итай
Кадмий и его соединения (особенно растворимые в воде) высокотоксичны. Кадмий нефротоксичен, он отрицательно влияет на обмен кальция[147], цинка, меди и железа в организме человека, избыток кадмия повышает риск возникновения заболеваний со стороны сердечно-сосудистой системы, злокачественных опухолей (канцероген) и остеопороза. Хроническое отравление кадмием приводит к болезни итай-итай
Ртуть и её соединения


Ртуть — один из самых опасных и высокотоксичных элементов, обладающий способностью накапливаться в растениях и в организме животных и человека, то есть являющийся ядом кумулятивного действия.
В организм человека ртуть поступает в наибольшей степени с рыбопродуктами, в которых её содержание может многократно превышать ПДК.
Токсичность ртути зависит от вида её соединений, которые по-разному всасываются, метаболизируются и выводятся из организма. Наиболее токсичны алкилртутные соединения с короткой углеродной цепью — метилртуть, этилртуть, диметилртуть. Механизм токсического действия ртути связан с её взаимодействием с сульфгидрильными группами белков (SH-группы). Блокируя их, ртуть изменяет свойства или инактивирует ряд жизненно важных ферментов. Неорганические соединения ртути нарушают обмен аскорбиновой кислоты, пиридоксина, кальция, меди, цинка, селена, а органические — обмен белков, цистеина, аскорбиновой кислоты, токоферолов, железа, меди, марганца, селена. Защитным эффектом при воздействии ртути на организм человека обладают цинк и особенно селен. Предполагают, что защитное действие селена обусловлено деметилированием ртути и образованием нетоксичного соединения — селено-ртутного комплекса. Человек получает с суточным рационом около 0,05 мг ртути, что соответствует рекомендациям ФАО/ВОЗ.
Мясо рыбы отличается наибольшей концентрацией ртути и её соединений, поскольку активно аккумулирует их из воды и корма, в который входят различные гидробионты, богатые ртутью. Например, хищные пресноводные рыбы могут содержать от 107 до 509 мкг/кг, нехищные пресноводные рыбы — от 78 до 200 мкг/кг, а океанские нехищные рыбы — от 300 до 600 мкг/кг Hg. Организм рыб способен синтезировать метилртуть, которая накапливается в печени. У некоторых видов рыб в мышцах содержится белок — металлотионеин, который с различными металлами, в том числе и с ртутью, образует комплексные соединения, способствуя тем самым накапливанию ртути в организме и передаче её по пищевым цепям. У таких рыб содержание ртути достигает очень высоких концентраций: рыба-сабля содержит её от 500 до 20 000 мкг/кг, а тихоокеанский марлин — от 5000 до 14 000 мкг/кг. Для других продуктов характерно следующее содержание ртути (в мкг/кг) — в продуктах животноводства: мясо — 6-20, печень — 20-35, почки — 20-70, молоко — 2-12, сливочное масло — 2-5, яйца — 2-15; в съедобных частях сельскохозяйственных растений: овощи — 3-59, фрукты — 10-124, бобовые — 8-16, зерновые — 10-103; в шляпочных грибах — 6-447, в перезрелых — до 2000 мкг/кг, причём, в отличие от растений, в грибах может синтезироваться метилртуть. При варке рыбы и мяса концентрация ртути в них снижается, при аналогичной обработке грибов — остаётся неизменной. Это различие объясняется тем, что в грибах ртуть связана с аминогруппами азотсодержащих соединений, в рыбе и мясе — с серосодержащими аминокислотами.
Болезнь Минамата
Наиболее печально известные примеры массового отравления ртутью были вызваны именно метилртутью CH3Hg+. В 1953 году в Японии у 121 жителя побережья в бухте Минамата было зафиксировано заболевание, сопровождавшееся ломотой в суставах, нарушением слуха и зрения. Это заболевание, вошедшее в литературу под названием «болезнь Минамата», закончилась смертью для почти трети больных.
В дальнейшем в 1959 году удалось установить, что эта болезнь вызывается употреблением в пищу рыбы, отравленной ртутью в форме хлорида CH3HgCl, сбрасываемого химическим предприятием (Chicco corp.) прямо в воды залива. Концентрация ртути была настолько велика, что рыба погибала; поедавшие эту рыбу птицы падали прямо в море, а отведавшие отравленной пищи кошки передвигались, «кружась и подпрыгивая, зигзагами и коллапсируя». К 1954 году популяция кошек в этих местах заметно снизилась. Однако до 1959 года никаких замеров ртутного загрязнения вод залива в этом районе не проводилось (мониторинг отсутствовал).
Интенсивное расследование позволило установить, что на заводе по производству ацетальдегида и уксусной кислоты из ацетилена (по реакции Кучерова) ртутные отходы (в виде отработанного сульфата ртути HgSO4) сбрасывались в реку, впадающую в бухту Минамата. При этом ртуть, о чём первоначально и не подозревали, микробиологическим путём превращалась в метилртуть, которая через планктон, моллюсков и рыб в конце концов попадала в пищу. В этом цикле ртуть постепенно концентрировалась и в конце пищевой цепи, дойдя до человека, достигала токсической концентрации. Загрязнение в устье канала сточными водами было настолько сильным, что измеренные значения концентраций составили 2 кг ртути на тонну отложений.
Свинец и его соединения

Acetate.jpg)
Свинец — один из самых распространённых и опасных экотоксикантов. История его применения очень древняя, что связано с относительной простотой его получения и большой распространённостью в земной коре (1,6·10−3 %). Соединения свинца — Pb3O4 и PbSO4 — основа широко применяемых пигментов: сурика и свинцовых белил. Глазури, которые используются для покрытия керамической посуды, также содержат соединения Pb. Металлический свинец со времён Древнего Рима применяют при прокладке водопроводов. В настоящее время перечень областей его применения очень широк: производство аккумуляторов, электрических кабелей, химическое машиностроение, атомная промышленность, производство эмалей, замазок, лаков, хрусталя, пиротехнических изделий, спичек, пластмасс и т. п. Мировое производство свинца составляет более 11,2 млн тонн в год. В результате производственной деятельности человека в природные воды ежегодно попадает более 1 млн тонн, а в атмосферу в переработанном и мелкодисперсном состоянии выбрасывается около 700 тыс. тонн, подавляющее большинство которого оседает на поверхности Земли.
Токсичность свинца

Механизм токсического действия свинца имеет двойную направленность. Во-первых, блокада функциональных SH-групп белков и, как следствие, инактивация ферментов, во-вторых, проникновение свинца в нервные и мышечные клетки, образование лактата свинца, затем фосфата свинца, которые создают клеточный барьер для проникновения ионов Са2+.
Свинцовая интоксикация может приводить к серьёзным нарушениям здоровья, проявляющимся в частых головных болях, головокружениях, повышенной утомляемости, раздражительности, ухудшении сна, мышечной гипотонии, а в наиболее тяжёлых случаях к параличам и парезам, умственной отсталости. Неполноценное питание, дефицит в рационе кальция, фосфора, железа, пектинов, белков (или повышенное поступление кальциферола) увеличивают усвоение свинца, а следовательно, его токсичность. Среднесмертельная доза свинца составляет 500 мг для взрослого человека, и менее 150 мг для детей.
Свинец в пищевых продуктах
Свинец обнаруживается в питьевой воде и некоторых пищевых продуктах.
Ежедневное поступление свинца в организм человека колеблется от 70 до 400 мкг. Основной источник поступления соединений свинца в организм — пища, преимущественно растительная. Поступление свинца в организм человека с питьевой водой составляет лишь несколько процентов от того количества свинца, которое вводится с пищей и воздухом. Основной источник свинца в воде — сплавы, используемые при соединении водопроводных труб. Имеются доказательства того, что содержание свинца в хлорированной водопроводной воде больше, чем в нехлорированной.
Отравления свинцом иногда носит массовый характер, например, в 2019 году в Бангладеш соединения свинца были добавлены в куркуму, чтобы сделать её более жёлтой[151]. Считается, что это началось в 1980-х и продолжается до сих пор.
Кадмий и его соединения

Кадмий — высокотоксичный металл и микроэлемент, является одним из основных загрязнителей окружающей среды[152]. Кадмий широко применяется в различных отраслях промышленности. Широко используется в ядерной энергетике, электронной и радиотехнической промышленности; а также при производстве аккумуляторов, различных сплавов и красок; кадмий добавляют в пластик (основа ПВХ) в качестве стабилизатора.
В воздух кадмий поступает вместе со свинцом при сжигании топлива на ТЭЦ, с газовыми выбросами предприятий, производящих или использующих кадмий. Загрязнение почвы кадмием происходит при оседании аэрозолей из воздуха и дополняется внесением минеральных удобрений: суперфосфата (7,2 мг/кг), фосфата калия (4,7 мг/кг), селитры (0,7 мг/г). Заметно содержание кадмия и в навозе, где он обнаруживается в результате следующей цепи переходов: воздух — почва — растения — травоядные животные — навоз. В некоторых странах соли кадмия применяют в качестве антисептических и антгельминтных препаратов в ветеринарии. В медицинских целях сульфат кадмия используют при проведении исследований свёртываемости крови. Всё это определяет основные пути загрязнения кадмием окружающей среды, а следовательно, продовольственного сырья и пищевых продуктов.
Токсичность кадмия и его соединений
В организм взрослого человека в течение суток поступает 10-20 мкг кадмия. Однако считается, что оптимальная интенсивность поступления кадмия должна составлять 1-5 мкг. Пищевыми источниками кадмия являются морепродукты (особенно мидии и устрицы), злаки (зерновые) и листовые овощи. Содержание кадмия (в мкг/кг) в различных продуктах выглядит следующим образом — растительные продукты: зерновые — 28-95, горох — 15-19, фасоль — 5-12, картофель — 12-50, капуста — 2-26, помидоры — 10-30, салат — 17-23, фрукты — 9-42, растительное масло — 10-50, сахар — 5-31, грибы — 100—500; продукты животноводства: молоко — 2,4, творог — 6,0, яйца — 23-250. Установлено, что примерно 80 % кадмия поступает в организм человека с пищей. Дефицит кадмия в организме может развиться при недостаточном поступлении этого элемента (0,5 мкг/сутки и менее), а порог токсичности равен 30 мкг/сутки. В тонком кишечнике адсорбируется менее 5 % поступившего с пищей кадмия. На всасывание кадмия существенно влияет присутствие других биоэлементов и пищевых веществ, таких как Ca, Zn, Cu, пищевые волокна и др. Кадмий, поступающий в организм с вдыхаемым воздухом, усваивается значительно лучше (10-50 %). В организме человека кадмий аккумулируется в основном в почках, печени и двенадцатиперстной кишке. С возрастом содержание кадмия в организме увеличивается, особенно у мужчин. Средняя концентрация кадмия у мужчин и женщин составляет соответственно в почках 44 и 29 мкг/г, печени — 4,2 и 3,4 мкг/г. Содержание кадмия в рёбрах составляет 0,4-0,5 мкг/г. Кадмий выводится из организма преимущественно через кишечник. Среднесуточная скорость выведения этого элемента очень незначительна и составляет, по некоторым данным, не более 0,01 % от общего количества кадмия содержащегося в организме. Эстрогены усиливают выведение кадмия, что может быть связано с активизацией обмена меди. Физиологическая роль кадмия изучена недостаточно. Кадмий обнаруживается в составе так называемого «металлотионеина» — белка, для которого характерно высокое содержание сульфгидрильных групп и тяжёлых металлов. Функция тионеина заключается в связывании и транспортировке тяжёлых металлов и их детоксикации. In vitro кадмий активирует несколько цинкзависимых ферментов: триптофан оксигеназу, ДАЛК-дегидратазу, карбоксипептидазу. Однако ферментов, которые бы активировались только кадмием, не обнаружено. Помимо ярко выраженной токсичности, кадмий проявляет канцерогенные свойства, вызывает риск возникновения кардиоваскулярных заболеваний и остеопороза[153][154][155][156].
Токсическая доза для человека: 3-330 мг. Летальная доза для человека: от 350 до 3500 мг. Растворимые соли кадмия — нитрат и хлорид, имеют летальные дозы в пределах от 50 до 150 мг. Сульфид кадмия наиболее токсичный из солей, наименьшая смертельная концентрация составляет менее 30 мг.
По рекомендациям ВОЗ допустимая суточная доза (ДСД) кадмия — 1 мкг.
Большое значение в профилактике интоксикации кадмием имеет правильное питание (включение в рацион белков, богатых серосодержащими аминокислотами, аскорбиновой кислоты, железа, цинка, селена, кальция), контроль за содержанием кадмия (полярографический, атомно-абсорбционный анализы) и исключение из рациона продуктов, богатых кадмием.
Токсичность алюминия

Алюминий — самый распространённый металл на Земле, он, как элемент занимает 3-место по распространёности и запасам, после кислорода и кремния. Алюминий занимает одно из ведущих мест среди важнейших металлов по уровню использования человеком. Из алюминия и его сплавов производят большое количество различных предметов, широко применяемых в быту: в первую очередь посуду и столовые приборы. Но несмотря на довольно низкую токсичность для млекопитающих и человека, он способен накапливаться в организме и вызывать негативные последствия.
Основным поставщиком алюминия в организм человека является алюминиевая посуда, если она контактирует с кислой или щелочной средой, вода, которая обогащается ионами Аl3+ при обработке её сульфатом алюминия на водоочистительных станциях. Существенную роль в загрязнении окружающей среды ионами Аl3+ играют и кислотные дожди. Не следует злоупотреблять содержащими гидроксид алюминия лекарствами: противогеморроидальными, противоартритными, понижающими кислотность желудочного сока (антацидные препараты). Как буферную добавку вводят гидроксид алюминия и в некоторые препараты аспирина, и в губную помаду. Среди пищевых продуктов наивысшей концентрацией алюминия (до 20 мг/г) обладает чай. Поступающие в организм человека ионы Аl3+ в форме нерастворимого фосфата выводятся с фекалиями, частично всасываются в кровь и выводятся почками. Токсичность алюминия во многом связана с его антагонизмом по отношению к магнию, фосфору, цинку и меди, а также способностью влиять на функции околощитовидных желёз, легко образовывать соединения с белками, накапливаться в почках (наиболее часто в виде фосфатов), костной (замещает кальций в гидроксиапатитах и вызывает остеомаляцию) и нервной ткани (приводит к энцефалопатиям)[157].
Установлено, что в реакциях алюминия с ионами железа возникает конкурентное взаимодействие, посредством которого металл связывается с трансферрином, что позволяет в его составе проходить гематоэнцефалический барьер.
В сутки взрослая женщина потребляет около 7,2 мг алюминия, взрослый мужчина — 8,6 мг.
Предельно допустимая концентрация для организма человека может достигать 100 мг/кг, а для растений — до 250 мг/кг. Совместный комитет экспертов ФАО/ВОЗ по пищевым добавкам установил величину переносимого суточного потребления (ПСП) на уровне 1 мг/кг веса.
Мышьяк и его соединения как контаминанты пищевых продуктов

Мышьяк как элемент в чистом виде ядовит только в высоких концентрациях. Он принадлежит к тем микроэлементам, необходимость которых для жизнедеятельности организма человека не доказана[158][159][160] , а его соединения, такие как мышьяковистый ангидрид, арсениты и арсенаты, сильно токсичны. Помимо этого мышьяк, как и его соединения сильные канцерогены (внесены в список: категория 1 от МАИР[161]). Мышьяк содержится во всех объектах биосферы (в земной коре — 2 мг/кг, морской воде — 5 мкг/кг). Известными источниками загрязнения окружающей среды мышьяком являются электростанции, использующие бурый уголь, медеплавильные заводы; он используется при производстве полупроводников, стекла, красителей, инсектицидов, фунгицидов и др.
Нормальный уровень содержания мышьяка в продуктах питания не должен превышать 1 мг/кг. Так, например, фоновое содержание мышьяка (в мг/кг): в овощах и фруктах — 0,01-0,2; в зерновых — 0,006-1,2; в говядине — 0,005-0,05; в печени — 2,0; яйцах — 0,003-0,03; в коровьем молоке — 0,005-0,01. Повышенное содержание мышьяка отмечается в рыбе и других гидробионтах, в частности в ракообразных и моллюсках.
По данным ФАО/ВОЗ, в организм человека с суточным рационом поступает в среднем 0,05-0,45 мг мышьяка. ДСД — 0,05 мг/кг массы тела.
В зависимости от дозы мышьяк может вызывать острое и хроническое отравление; разовая доза мышьяка 30 мг — смертельна для человека. Механизм токсического действия мышьяка связан с блокированием SH-групп белков и ферментов, выполняющих в организме разнообразные функции.
Барий и его соединения как контаминанты пищевых продуктов

Барий — мягкий, серебристо-белый щёлочноземельный металл, широко используется в виде сплавов и соединений в промышленности и сельском хозяйстве, в производстве инсектицидов (хлорид бария, BaCl2)[162] и родентицидов (карбонат бария, BaCO3)[162], медицине (бариевая каша, BaSO4), пиротехнике (пероксид, хлорат и нитрат бария[162]), ядерной энергетике (оксид бария), химических источников электрического тока (фторид и оксид бария). Барий относится к токсичным ультрамикроэлементам, он обладает высокой химической активностью (пожаро- и взрывоопасен), при попадании на открытые участки кожи и слизистые оставляет глубокие химические ожоги. Его биологическая роль в организме человека не выявлена. Содержание бария в организме взрослого человека (~ 70 кг), в среднем составляет 18-20 мг, большая часть приходится на костную ткань (> 90 %). Барий плохо всасывается в кишечнике человека (~ 10 %), поэтому и редко встречаются случаи интоксикаций им и/или его солями. Но несмотря на редкость отравлений, описаны довольно серьёзные последствия избыточного поступления растворимых соединений с пищей, например, при употреблении рафинированного сахара, контаминированного гидроксидом бария.
Токсичность бария и его соединений
Все растворимые соли и гидроксид бария являются довольно токсичными соединениями, но особенно хлорид, среднесмертельная доза которого составляет порядка 800 мг[162][163].
Барий как и стронций, может изоморфно замещать кальций гидроксиапатита, основного минерального компонента костной ткани, вызывая так называемый «бариевый рахит».
Механизм изоморфного замещения ионов Ca2+ ионами Ba2+ в молекулах гидроксиапатита:
Ca10(PO4)6(OH)2 + Ba2+ → Ca9Ba(PO4)6(OH)2 + Ca2+.
По токсичному механизму действия на организм, барий относится к нейротропным и кардиотропным ядам. Ионы Ba2+ имеют схожий ионный радиус, что и ионы калия К+, являются антагонистами калиевых ионных каналов[164], ингибируя работу последних. Вследствие чего, происходит повышение внутриклеточной концентрации ионов калия, сопровождаемое сильнейшей гипокалиемией, что ведёт к нарушениям нейрональной проводимости и спазмам миокарда (экстрасистолия) и гладкой мускулатуры. При остром отравлении наблюдают следующие признаки: со стороны сердечно-сосудистой и дыхательной системы: цианоз (синюшность), одышку, гипотонию (снижение АД), слабость пульса, брадикардию и нарушения сердечного ритма; со стороны органов ЦНС: судороги, головную боль, нарушения мозговой деятельности — энцефалопатия (зрения, слуха), координации движений и равновесия, головокружение, в некоторых случаях (тяжёлых) возникают и параличи всех конечностей (квадраплегия); со стороны органов ЖКТ: абдоминальную спастическую боль, тошноту и рвоту, жжение в ротовой полости и пищеводе, обильное слюноотделение, диарею; со стороны кожных покровов: бледность, и обильный холодный пот; со стороны опорно-двигательного аппарата: невозможность поворота головы, вследствие нарушения мионевральной связи мышц шеи и возможного паралича, нарастающую гипотонию мышц, особенно верхних конечностей. При тяжёлых отравлениях, смерть возникает вследствие резкого коллапса сердца и поражения блуждающего нерва (дыхательная и сердечно-сосудистая недостаточность).
Описано единственное, но довольно массовое отравление, вызванное одновременно хлоридом и карбонатом бария, которые контаминировали пшеничную муку (содержание в муке, соответственно для хлорида 340 мг/кг и 657 мг/кг для карбоната). Хлеб, выпеченный из такой муки, привёл к отравлению несколько десятков человек, большая часть (~ 70 %) которых имела симптомы кишечной формы, у остальных пациентов наблюдались симптомы с преобладанием кардиотропного и нейтропного характера. Также имеются описания случайной контаминации месторождения поваренной соли, хлоридом бария (пласты хлоридов бария и натрия, случайно оказались совместными), которая в дальнейшем вызвала значительную интоксикацию большого количества людей в китайской провинции Сычуань в 1943 году (т. н. отравление Па Пинг).
При хроническом отравлении соединениями бария возникает баритоз.
Минимальная токсическая доза соединений бария составляет порядка 0,01-0,03 г для хлорида бария, и 0,15-0,2 г для остальных растворимых соединений (нитрата, ацетата, хлората, сульфида, гидроксида). Дневная суточная доза (ДСД) для бария точно не определена; среднесуточное поступление в организм человека лежит в пределах 0,3-1 мг[165].
Нитраты, нитриты и нитрозамины в пищевых продуктах
.jpg)
Нитраты и нитриты — это химические неорганические и органические соединения, соли и эфиры, соответственно, азотной (HNO3) и азотистой (HNO2) кислот. Нитраты натрия, калия, кальция и особенно аммония, широко применяют в сельском хозяйстве, в качестве азотсодержащих удобрений (так называемые «селитры»). Из почвы они всасываются растениями, некоторая часть нитратов может проникать в подпочвенные воды, оттуда в колодцы и ручьи, которые могут быть связаны с крупными реками или водоёмами, используемые для водоснабжения. Нитраты способны интенсивно накапливаться в некоторых растениях, обеспечивая их быстрый рост и созревание. Домашние животные со свободным выпасом (крупный рогатый скот, овцы, свиньи) получают избыток нитратов, из поедаемых растений с высоким их содержанием. Далее, они попадают в организм человека с пищей (в основном растительного происхождения), водой, соками и молоком. Нитраты образуются и в нашем собственном организме (эндогенные нитраты), выполняя роль антимикробного агента в слюне, а также участвуя в работе сердечно-сосудистой системы, регулируя кровяное давление. Избыток нитратов, также образуется на поверхности эмали зубов (благодаря бактериальной микрофлоре) при злоупотреблении табачными изделиями (курение сигарет, сигар, итд.). В большей степени нитриты являются продуктами восстановления нитратов под действием фермента — нитратредуктазы, которое происходит в клетках бактерий кишечной микрофлоры. Из кишечника нитриты всасываются в кровь. Нитриты обладают более высокой токсичностью (например, ЛД50 нитрита натрия составляет около 22-23 мг/кг[166]), чем нитраты, так как быстрее и эффективнее переводят гемоглобин в неактивную форму — метгемоглобин (окисляют Fe2+ гема до Fe3+), который не способен переносить кислород, так, 1 мг нитрита натрия (NaNO2) может перевести в метгемоглобин около 2000 мг гемоглобина, что и приводит к метгемоглобинемии.
Согласно данным ФАО/ВОЗ, ДСД нитритов составляет 0,2 мг/кг массы тела, исключая грудных детей. Острая интоксикация отмечается при одноразовой дозе с 200—300 мг, летальный исход при 300—2500 мг. Токсичность нитритов будет зависеть от пищевого рациона, индивидуальных особенностей организма, в частности от активности фермента метгемоглобинредуктазы, способного восстанавливать метгемоглобин в гемоглобин. Хроническое воздействие нитритов приводит к снижению в организме витаминов А, Е, С, В1, В6, что, в свою очередь, сказывается на снижении устойчивости организма к воздействию различных негативных факторов, в том числе и онкогенных. Кроме того, из нитритов в присутствии различных вторичных аминов могут образовываться высокотоксичные N-нитрозамины.
Нитрозамины


Нитрозамины — это азотсодержащие соединения, которые имеют в своём составе нитрозофункциональную группу (R1(R2)-N-N=O) и являющиеся хорошо известными высокотоксичными загрязнителями, которые образуются реакциями при взаимодействии в основном вторичных аминов (в гораздо меньшей степени с третичными) с нитритами в кислотных условиях (например, в среде желудочного сока). Представляют собой маслянистые жидкости (низшие имеют желтоватый оттенок) либо твёрдые вещества. Многие нитрозамины хорошо растворимы в воде (низшие представители) или органических растворителях. Вследствие этого, они легко проникают через слизистые и тканевые барьеры, имеют свойство кумуляции. Обладают довольно высокой стабильностью во внешней среде, также высокая температура разложения (более 450—500 °С), позволяют нитрозаминам оставаться в продуктах питания очень долго. Химически стойкие, не разлагаются при действии на них растворами разбавленных кислот и щелочей, устойчивы к действию солнечного света. Интенсивное разложение нитрозаминов происходит при использовании сильных окислителей, например, хромовой смесью или озона, коротковолнового УФ-излучения или гамма-лучей.
В зависимости от природы радикала могут образовываться разнообразные нитрозамины, 80 % из которых помимо ярко выраженной токсичностью (LD50 10-220 мг/кг, перорально), обладают канцерогенным, мутагенным, тератогенным воздействиями, причём канцерогенное действие этих соединений определяющее.
Нитрозамины могут образовываться в окружающей среде; так, с суточным рационом человек получает примерно 1 мкг нитрозосоединений, с питьевой водой — 0,01 мкг, с вдыхаемым воздухом — 0,3 мкг, но эти значения могут значительно колебаться в зависимости от степени загрязнения окружающей среды. В результате технологической обработки сырья, полуфабрикатов (при интенсивной термической обработке, копчении, засолке, длительном хранении и т. п.) образуется широкий спектр нитрозосоединений.
Наибольшее распространение получили такие нитрозосоединения, как N-нитрозодиметиламин (НДМА), N-нитрозодиэтиламин (НДЭА), N-нитрозодипропиламин (НДПА), N-нитрозодибутиламин (НДБА), N-нитрозопиперидин (НПиПА), N-нитрозопирролидин (НПиР). Для предотвращения образования нитрозосоединений в организме человека реально лишь снизить содержание нитратов и нитритов, так как спектр нитрозируемых аминов и амидов слишком обширен. Существенное снижение синтеза нитрозосоединений может быть достигнуто путём добавления к пищевым продуктам аскорбиновой или изоаскорбиновой кислоты или их натриевых солей.
Допустимая суточная доза согласно рекомендации ВОЗ для взрослого человека нитрозаминов составляет от 26,5 нг для НДЭА до 96,0 нг для НДМА.
Меры предосторожности

Отравления, вызванные нитратами и нитритами являются одними из самых распространённых, наиболее часто они происходят в летний сезон. Причинами возникновения интоксикаций являются потребление зелени, овощных и/или бахчевых культур не прошедших санитарно-эпидемиологический контроль, они могут содержать потенциально опасные концентрации нитратов и представляют серьёзную угрозу здоровью человека.
Клинические признаки отравления проявляются уже через 1-6 часов и характеризуются расстройствами пищеварения с увеличением печени, пожелтением склер глаз (иктеричность). При этом наблюдается недомогание, слабость, сильные головные боли, сонливость, головокружение, потемнение в глазах, нарушение координации. Сосудорасширяющий эффект нитратов приводит к понижению артериального давления (гипотонии), синусовой аритмии, болям в груди, одышке. При определённых условиях в пищевых продуктах или уже в кишечнике (особенно у детей) часть нитратов может восстанавливаться в более токсичные нитриты с последующим развитием нитритной метгемоглобинемии. Среднее содержание метгемоглобина в крови здорового человека — 1-2 %, однако уже при 8-10 % отмечается синюшность кожи, при 30 % и выше развиваются симптомы острой гипоксии (низкая сатурация (80-85 %), одышка, тахикардия, гипотония, слабость, головная боль, слизистые приобретают коричнево-серый оттенок), летальной концентрацией в плазме крови, считается содержание метгемоглобина превышающая 70 %[168]. Тяжёлые отравления со смертельными исходами имели место при поступлении нитратов на уровне 1200—2000 мг/кг продукта, например, арбузами.
Чтобы снизить риск интоксикаций, вызванных избыточным содержанием нитратов и нитритов в растительных продуктах, необходимо придерживаться следующих правил:
- Приобретайте свежие растительные продукты, покупайте овощи и фрукты в сезон; в созревших плодах нитраты, как правило, содержатся в допустимых количествах.
- Овощи и зелень, выращенные на открытом грунте, содержат меньше нитратов, чем аналогичные в теплицах.
- Мытьё и чистка овощей сокращает количество нитратов на 10 %. Варка — на 40-70 %. Это связано с тем, что нитраты хорошо растворяются в воде и разрушаются при нагревании. При этом помните, что при варке овощей в воду переходит около 30-40 % нитратов, а значит использовать первый отвар в пищу нельзя. Тщательно промывайте в проточной воде зелень. У капусты удаляйте верхние листья и особенно кочерыжку — настоящий «кладезь» нитратов.
- Помните, что употребление сырых овощных соков, в особенностм свекольного, несёт риск возникновения интоксикации организма нитратами.
- Используйте нитрат-тестеры в тех случаях, когда сомневаетесь в качестве продукции. Современные нитрат-тестеры довольны компактны и удобны в использовании, результаты анализа можно получить в течение 20 секунд.
- При появлении первых симптомов отравления нитратами следует немедленно обратиться к врачу!
Пестициды в пищевых продуктах
Пестициды — вещества различной химической природы, применяемые в сельском хозяйстве и быту для защиты культурных растений от сорняков, а также вредителей и переносчиков заболеваний (насекомых, клещей, грызунов итд.), то есть они являются химическими средствами защиты растений и животных. Мировое производство пестицидов (в пересчёте на активные вещества) составляет более 2 млн тонн в год, причём эта цифра непрерывно растёт. В настоящее время в мировой практике используют около 10 тыс. наименований пестицидных препаратов на основе 1500 действующих веществ, которые относятся к различным химическим группам. Наиболее распространены следующие: хлорорганические, фосфорорганические, карбаматы (производные карбаминовой кислоты), ртутьорганические, синтетические пиретроиды и медьсодержащие фунгициды. С гигиенических позиций принята следующая классификация пестицидов:
- по токсичности при однократном поступлении через желудочно-кишечный тракт пестициды делятся на сильнодействующие ядовитые вещества (ЛД50 до 50 мг/кг), высокотоксичные (ЛД50 от 50 до 200 мг/кг), среднетоксичные (ЛД50 от 200 до 1000 мг/кг), малотоксичные (ЛД50 более 1000 мг/кг);
- по кумулятивным свойствам пестициды делятся на вещества, обладающие сверхкумуляцией (коэффициент кумуляции меньше 1), выраженной кумуляцией (коэффициент кумуляции от 1 до 3), умеренной кумуляцией (коэффициент кумуляции от 3 до 5), слабовыраженной кумуляцией (коэффициент кумуляции больше 5);
- по стойкости пестициды делятся на очень стойкие (время разложения на нетоксичные компоненты свыше 2 лет), стойкие (от 0,5 до 1 года), умеренно стойкие (от 1 до 6 месяцев), малостойкие (1 месяц).
Нарушения гигиенических норм хранения, транспортировки и применения пестицидов, низкая культура работы с ними приводят к их накоплению в кормах, продовольственном сырьё и пищевых продуктах, а способность аккумулироваться и передаваться по пищевым цепям — к их широкому распространению и негативному влиянию на здоровье человека. Применение пестицидов и их роль в борьбе с различными вредителями в повышении урожайности сельскохозяйственных культур, их влиянии на окружающую среду и здоровье человека вызывают неоднозначные оценки различных специалистов.
Пестициды группы альдрина

Пестициды группы альдрина — хлорорганические соединения, полихлорциклодиены, производные альдрина, одни из самых опасных веществ, представляют серьёзную угрозу здоровью человека и окружающей среде. Все производные альдрина — высокотоксичные вещества (для некоторых групп животных чрезвычайно токсичные, например, для холоднокровных — рыб, земноводных, пресмыкающихся, особенно в виде аэрозоля), химические контаминанты, обладающие свойствами биоаккумуляции, отравляя тем самым пищевые цепи и устойчивостью к биохимическому разложению. Несмотря на токсичность, пестициды этой группы обладают необычайно высокой инсектицидной, а также гербицидной активностью[135], превосходя ДДТ и гексахлоран. По решению Стокгольмской конвенции от 23 мая 2001 года альдрин и его производные признаны стойкими органическими загрязнителями и имеют глобальный запрет на производство, использование и реализацию[169]. Несмотря на запрет Стокгольмской конвенции, дильдрин до сих пор производится и применяется в качестве инсектицида в некоторых странах: например, в Малайзии, Венесуэле, Таиланде, некоторых странах Африки.
 Альдрин
Альдрин Дильдрин
Дильдрин Эндрин
Эндрин
Токсичность
Все производные альдрина — СДЯВ, нейротоксичной природы, имеются данные о бластомогенном действии альдрина. Имеются ярко выраженные мутагенные эффекты у дильдрина и эндрина. По своей токсичности некоторые производные (эндрин) близки к цианидам.
| Организм | Альдрин | Дильдрин | Эндрин |
|---|---|---|---|
| Мыши (перорально) | 50 мг/кг | 20-22,5 мг/кг | 9,5-10 мг/кг |
| Кролики (перорально) | 55-58 мг/кг | 12-15 мг/кг | 7-10 мг/кг. |
| Человек (ЛД100, аэрозоль) | 12 мг/кг | 8 мг/кг | <5 мг/кг |
| Форель (ЛК50) | 0,00005 мг/л | 0,000035 мг/л | 0,00073 мг/л |
Наибольшая токсичность пестицидов группы альдрина проявляется в газообразном или аэрозольном состоянии. Альдрин и его производные возможно использовать в качестве БОВ (в виде аэрозолей). Большинство пестицидов этой группы хорошо проникают через кожу.
Фитотоксичность
Растения, обработанные альдрином или его производными могут накапливать (кумулировать) их в довольно больших концентрациях, особенно это выражено у растений семейства Мятликовых (Poaceae).
Массовые отравления эндрином в Пакистане
С 14 июля по 26 сентября 1984 года длилась вспышка отравлений эндрином в 21 деревне района Талаганг провинции Пенджаб в Пакистане, в результате которой пострадало более 190 человек, 80 % составили дети в возрасте до 15 лет, 19 человек погибли. Отравление сопровождалось сильнейшими судорогами, рвотой, отёками лёгких и гипоксии. У людей, имеющих высокую температуру тела, рвота проявлялась в меньшей степени, чем у имеющих более низкую или нормальную. Большинству пострадавших была оказана медицинская помощь[25].
Причиной отравлений являлось загрязнение эндрином сельскохозяйственной культуры, употребляемой в пищу — сахарного тростника, в то же время наблюдались отравления людей, имеющих дело с хлопчатником. Ряд водителей грузовиков, перевозивших в провинцию Талаганг этот пестицид, утверждают, что скорее всего загрязнение сельскохозяйственных культур произошло при транспортировке[170].
Фосфорорганические пестициды
Бензол и его производные как контаминанты

Бензол будучи одним из наиболее синтезируемых органических соединений (более 60 миллионов тонн в год (оценка на 2019)), при этом является и высокоопасным для здоровья человека веществом. Токсичность бензола долгое время была недооценённой. Бензол обладает политропным воздействием, с преимущественно миелотоксичным и мутагенным эффектами. Хроническое воздействие бензолом может увеличить риск возникновения злокачественных новообразований системы крови, клеток паренхимы печени и лимфоидной ткани. Наиболее чувствительны к бензолу клетки активно делящихся тканей — миелоидной и лимфоидной, так как он обладает радиомиметичностью (сходством с ионизирующим излучением). ЛД100 для человека составляет около 55-70 мл, минимальные летальные дозы могут быть намного меньше — 15-17 мл. Бензол в организме человека в большей степени подвергается биотрансформации в печени, где и происходит образование высокореакционных продуктов.
Трансформация бензола в клетках печени и миелоидной ткани

Попав в клетки печени (гепатоциты) или миелоидной ткани бензол претерпевает биотрансформацию, происходящую при участии фермента цитохрома P450, которая приводит к образованию высоко реакционноспособных соединений (эпоксид и оксид бензола) и генерирует свободные радикалы, вследствие активации цитохрома P450 (образуются в первую очередь активные формы кислорода — пероксид радикалы). Конечным продуктом биотрансформации бензола является фенол. Реакция протекает по уравнению:
- CYР450 + NADPH + H- + O2 → CYP450 + NADP+ + HOOH,
- HOOH → 2OH·,
- C6H6 + 2OH· → C6H5OH + H2O.
Образовавшиеся активные формы кислорода способны повреждать клетки миелоидной ткани, которые очень чувствительны к такому роду воздействию (оксидативный стресс). Это приводит к дегенерации и деструкции миелоидной ткани, которые имеют очень серьёзные последствия (миелодисплазии, апластическая анемия и лейкозы)[136]. Повреждения миелоидной ткани ведёт к дисфункциям, сопряжённой с ней иммунной системы.
Таким образом бензол проявляет радиомиметический эффект (эффект, сходный с воздействием ионизирующего излучения).
Эпоксид и оксид бензола имеют высокое угловое напряжение связей -С-О-С- и легко превращаются в электрофильные молекулы, посредством разрыва данных связей. Образованные электрофильные молекулы легко образуют прочные ковалентные связи с нуклеофильными центрами аминогрупп в молекулах нуклеиновых кислот (реакция нуклеофильного замещения SN2), в частности, с нуклеотидами ДНК, образовавшиеся продукты носят названия ДНК-аддуктов (например, N7-фенилгуанин). ДНК-аддукты изменяют структуру нативной молекулы ДНК, таким образом, что происходит невозможность протекания нормальных процессов удвоения (репликации) и транскрипции. Это в свою очередь приводит к повреждениям участков ДНК (генотоксичность), образованию мутантных белков, торможению апоптоза, подавлению экспрессии некоторых белков-антионкогенов (вплоть до утраты) и в конечном итоге возможна трансформация клеток (малигнизация) или смерть (некроз). Таким образом, продукты окисления бензола проявляют мутагенные и канцерогенные свойства. К тому же оксид является довольно токсичным веществом.

Накопление продуктов окисления бензола, крайне негативно сказывается на целостности клеток. Активные формы кислорода могут начать процесс перекисного окисления липидов и перегрузить антиоксидантную систему. Помимо этого в больших концентрациях бензол может разрушать биомембраны клеток, посредством солюбилизации и растворения липидного бислоя. Хроническое воздействие продуктов окисления бензола увеличивают риск возникновения злокачественных опухолей системы крови и паренхимы печени.
Бензол в пищевых продуктах
Впервые большие дозы бензола были обнаружены в газированных напитках ещё в 1990 г. в США (Perrier).
Фенолы

Фенолы — кислородсодержащие органические соединения, в составе которых имеется одна или несколько гидроксильных групп (-OH) и арильный (ароматический) углеводородный радикал. Общая формула фенолов, схожа с формулой спиртов, однако, в фенолах гидроксильная группа присоединена непосредственно к арильному радикалу. Примеры фенолов:
 Фенол или гидроксибензол
Фенол или гидроксибензол Пирокатехин или 1,2-дигидроксибензол
Пирокатехин или 1,2-дигидроксибензол Резорцин или 1,3-дигидроксибензол
Резорцин или 1,3-дигидроксибензол Гидрохинон или 1,4-дигидроксибензол
Гидрохинон или 1,4-дигидроксибензол Пара-крезол или 1-метил-4-гидроксибензол
Пара-крезол или 1-метил-4-гидроксибензол
Фенолы отличаются от спиртов значительно более сильными кислотными свойствами. В водных растворах едких щелочей образуют соли — феноляты, которые гидролизуются водой и разлагаются кислотами, образуя свободные фенолы. На воздухе фенолы постепенно окисляются. Фенолы отличаются значительным разнообразием — от практически нетоксичных до весьма токсичных. Часть одноатомных фенолов — сильные нейротоксины, поражают печень, почки, проникают через кожу; однако высшие члены ряда в производственных условиях мало опасны. Многоатомные фенолы при длительном поступлении в организм нарушают ферментативные процессы.
Токсичность фенолов зависит от строения, положения и количества радикалов, от растворимости в воде и жирах. В порядке повышения токсичности они располагаются следующим образом: пирогаллол—резорцин—фенол—крезолы—ксиленолы—нитрофенолы—нафтолы—гидрохинон—хлорфенолы.
Фенолы способны накапливаться в рыбах и передаваться по трофической цепи. В наибольшем количестве они обнаруживаются в печени, а затем (в порядке уменьшения) в жабрах, почках, селезёнке, мышцах и кишечнике. При остром отравлении карпов и форели (10 мг/л) содержание фенолов составляло в печени 119 мг/кг, в жабрах 17,7, внутренних органах 7,9; при хроническом отравлении (0,02-0,07 мг/л) — 2,0-3,0 мг/кг. В реках, не загрязнённых фенолом, в теле плотвы его содержание составляло 0,3 мг/кг.
Обратимость фенольной интоксикации высокая, так как соединения фенола распадаются или выводятся из организма в течение 1-2 суток, а некоторые соединения сохраняются несколько недель. Рыба приобретает фенольный запах и вкус при содержании в воде смеси фенола и крезолов 0,02-0,03 мг/л, хлорфенолов 0,015-0,001 мг/л, а также после поедания загрязнённых кормовых объектов (тубифацид, хирономид).
Фенольная катастрофа в Уфе
Наглядным примером воздействия фенола на окружающую среду стал случай весной 1990 года в Уфе. В результате техногенной аварии на предприятии ПО «Уфахимпром» произошла утечка большого количества фенола в речку Шугуровка, впадающую в более крупную реку Уфу, являющуюся источником хозяйственно-питьевого водоснабжения города Уфы. Загрязнение воды в районе Южного водозабора превышало ПДК более чем в 100 раз. Опасность загрязнения питьевой воды фенолом проявляется в том, что при очистке вод использовался хлор, который, взаимодействуя с фенолом, образовывал хлорпроизводные (смесь хлорфенолов) — более токсичные вещества (некоторые в 100—250 раз превышают токсичность самого фенола). Население Уфы было оповещено об опасности употребления водопроводной воды для питья. Общая численность населения, потреблявшего питьевую воду, загрязнённую фенолом из Южного водозабора Уфы, составила 672 876 человек[171].
Нитробензол

Нитробензол представляет собой органическое вещество, нитропроизводное бензола. Это тяжёлая маслянистая бесцветная жидкость с характерным сильным горько-миндальным запахом. Нитробензол гидрофобный и не растворяется в воде, растворим в неполярных органических растворителях: в бензоле (неограниченно), толуоле, гексане, диэтиловом эфире. Широкое использование в химической промышленности, нитробензол получил в результате реакции гидрирования (реакция Зинина), с образованием ценного органического продукта — анилина (более 95 % нитробензола используют для синтеза анилина). Также нитробензол используются в качестве растворителя и мягкого окислителя, его производные применяют в синтезе взрывчатых веществ, компонентов ракетного топлива, лакокрасочных изделий, некоторые в медицине. Нитробензол высокотоксичен (II класс опасности), относится к гематропным ядам, с превалирующим гемолитическим и метгемоглобинобразующим воздействиями, также поражает органы ЦНС.
Токсичность и механизм токсического воздействия

Летальная доза нитробензола для человека составляет 10 мг/кг, но смертельный исход может наступить уже от приёма 1-2 мл или нескольких капель вещества. Механизм токсического воздействия нитробензола основан на влияние процессов транспортировки молекул кислорода гемоглобином. Несмотря на высокое значение дипольного момента (4,237 D), нитробензол легко проникает в «гидрофобный карман» гемоглобина. Где связывается с железом гема. Нитрогруппа в молекуле обладает довольно сильным метгемоглобинобразующим свойством, окисляет двухвалентное железо (Fe2+) гема в трёхвалентное, которое не способно переносить кислород (обладает очень низким сродством).
Схема реакции образования метгемоглобина:
- Hb(Fe2+) + NO2-C6H5 = MetHb(Fe3+) + 1/2O2 + NO-C6H5.
Помимо этого, молекулы нитробензола способны нарушать целостность мембран эритроцитов и ингибировать ферменты пентозофосфатного пути (глюкозо-6-фосфатдегидрогеназа), вызывая накопления свободных радикалов, что приводит к деструкции мембран и гемолизу.
Анилин
Диоксины в пищевых продуктах

Диоксины представляют собой бифункциональные органические высокотоксичные соединения (некоторые, как, например, ТХДД — чрезвычайно токсичные), обладающие политропным воздействием, с ярко выраженными мутагенными, канцерогенными, иммунодепрессивными, эмбриотоксическими и тератогенными свойствами. Диоксины — твёрдые вещества, без вкуса и наличия запаха, гидрофобные и нерастворимые в воде (растворимость составляет 10−12−10−13 г/мл), однако хорошая растворимость проявляется в неполярных растворителях и липофильных веществах. Реакционная способность у диоксинов очень низкая, они не взаимодействуют с водой, растворами кислот и щелочей, окислителями. Температуры разложения диоксинов лежат в пределах от 800 до 1100 °С. Поэтому они обладают высокой устойчивостью в окружающей среде и могут оставаться неизменными многие годы, особенно в почве (более 10 лет). Особую опасность диоксины как экотоксиканты представляют живым существам, так как они могут накапливаться в организмах животных (в жировой ткани), тем самым способствуют хроническому отравлению и миграции по цепи питания. Ещё большую опасность для здоровья и жизни человека представляет накопление диоксинов в пищевых продуктах, в основном животного происхождения (мясе, печени, рыбе, яйцах, молоке итд.), реже они встречаются в растительном масле, овощных консервах и питьевой воде.
Большой вклад (более 97-98 %) в генерации диоксинов вносит человеческая деятельность, однако и природные процессы, такие, как массовые лесные пожары, способны к генерации диоксинов, но в гораздо меньшей степени. Диоксины образуются в результате производства пестицидов, гербицидов, деятельности мусоросжигающих заводов, функционирования объектов деревообрабатывающей, целлюлозно-бумажной, химической, нефтехимической промышленности, хлорирования воды в бассейнах и др. Особенно опасны аварийные ситуации, связанные с пожарами. По мнению ВОЗ, в более 90 % случаев влияние диоксинов на людей происходит через пищевые продукты.
Примером экстремального роста уровня диоксинов в питьевой воде могут служить события, случившиеся в Уфе в 1989—1990 гг. и потом ставшие известными, как крупнейшая экологическая катастрофа СССР — фенольная катастрофа. Анализ образцов вод, отобранных 21 апреля 1990 года, то есть спустя 3-4 недели после начала событий, был выполнен в Научном центре по разработке и внедрению современных методов молекулярной диагностики (НЦМД, Москва). Были найдены следующие концентрации диоксинов (в нг/л), превышавшие предел обнаружения использованной аппаратуры и потому зафиксированные.
| Место взятия проб | Общее содержание диоксинов (нг/л) | Содержание ТХДД (нг/л) |
|---|---|---|
| Территория ПО «Уфахимпром» | 26,92 | 8 |
| р. Уфа (южный водозабор) | 38,4 | 7,6 |
| Верхняя зона № 2 машинного зала | 17 | 7,4 |
| Водоразборная колонка на ул. Ахметова | 13,78 | ~ 1,15 |
В бывшем СССР на то время действовала лишь одна норма — содержание диоксинов в любых водах не должно было превышать 0,26 пг/л.
Оценки показали, что даже 3-4 недели спустя после начала событий содержание диоксинов в воде в тысячи раз превышало допустимые уровни того времени:
- территория ПО «Химпром» — в > 100000 раз,
- Река Уфа — в > 147000 раз,
- верхняя зона № 2 машинного зала (южный водозабор) — в > 23000 раз,
- водоразборная колонка на ул. Ахметова — в > 53000 раз.
Токсичность и механизмы действия


Диоксины токсичны при любых концентрациях. В малых дозах (менее 100 нг/кг) они вызывают мутагенный эффект, отличаются кумулятивными свойствами, ингибируют различные ферментные системы организма. Опасность кумуляции диоксинов заключается в том, что новые дозы, попавшие в организм извне могут вызвать молниеносные формы отравления в ничтожных количествах (менее 100 нг/кг).
Острые токсические дозы наблюдаются уже при концентрации 100—2000 нг/кг, манифестируют процессы снижения лимфо- и лейкопоэза, снижается процесс деления сперматоцитов, в клетках лимфоидной, миелоидной, а также в гепатоцитах и селезёнки появляется оксидативный стресс, из-за торможения всасывания и метаболизма витаминов A и E, уровни глутатиона имеют довольно низкие значения. В сублетальных дозах (более 10000-50000 нг/кг) наблюдается поражение практически всех внутренних органов (ЖКТ, почек, ЦНС, итд.) и желёз внутренней секреции (тимус, щитовидная железа, гонады), селезёнки, печени, кожи (хлоракне), происходят изменения в составе крови, ликвора, быстро падает уровень лимфоцитов, снижаются обменные процессы, антиоксидантная защита, поражается миелоидная ткань и лимфоидная ткань, появляются морфологические изменения в структуре клеток Лейдига и сперматоцитов итд. Дозы диоксинов в больших концентрациях (более 70000-90000 нг/кг), полученных за относительно короткий промежуток времени смертельно опасны.
Источники, содержание в пищевых продуктах, система менеджмента безопасности
Источниками поступления диоксинов в организм человека являются продукты питания (до 95 %), воздух (3,5 %), почва (1,3 %), вода (0,001 %). Признано недопустимым присутствие диоксинов в продуктах питания, воздухе и питьевой воде. Однако достичь этого практически невозможно. Пороговые дозы и нормы — это условность.
Суммарное суточное поступление диоксинов в организм человека с продуктами питания в Германии составляет 79 пг, в Японии — 63 пг, в Канаде — 92 пг, в США — 119 пг. В основных пищевых продуктах рекомендован допустимый уровень диоксинов — от 0,75 до 4 нг/кг (в пересчёте на жиры). В ряде продуктов их содержание не допускается (в пределах обнаружения существующих методов). Допустимые уровни содержания диоксинов в основных пищевых продуктах в России (СанПиН 2.3.2.2401-08) и ВОЗ представлены в таблице Гигиенические нормативы диоксинов в пищевых продуктах гармонизированы с зарубежными значениями (ВОЗ).
| Наименование продукта | Допустимая концентрация диоксинов, не более (нг/кг) | WHOPCDD/F-TEQ*, пг/г липидов |
|---|---|---|
| Мясо и мясопродукты, консервы, жир-сырец: свинина, говядина, баранина, субпродукты | 1-6 | 1,0-6,0 |
| Мясо и мясопродукты из птицы | 2 | 2,0 |
| Яйца и яичные продукты | 3 | 3,0 |
| Молоко и молочные продукты | 3 | 3,0 |
| Рыба, консервы рыбные | 4 | 4,0** |
| Рыбий жир (в пересчёте на липиды) | 2 | 2,0 |
| Растительное масло | 7,5 | 7,50 |
| Примечание:* Коэффициент эквивалентной токсичности WHOPCDD/F-TEQ, ** пг/г сырого веса. |
В целом, установление санитарных норм по диоксинам в различных странах базируется на разных критериях. В Европе как основной принят показатель онкогенности (то есть за основу берут возможность возникновения злокачественных опухолей), в США — показатель иммунотоксичности (то есть угнетение иммунной системы). Расчёт ДСД (допустимой суточной дозы) ведётся таким образом, чтобы за 70 лет жизни в организм человека поступило диоксинов не больше 10−11 г/кг в день[172].
Полициклические ароматические углеводороды


Полициклические ароматические углеводороды (сокр. ПАУ) — особый класс ароматических углеводородов, представляющие серьёзную угрозу пищевой безопасности и здоровью человека. Несмотря на это, большинство ПАУ не обладают высокой токсичностью или канцерогенностью (>65 %), однако, имеются несколько десятков довольно распространённых соединений, которые могут иметь очень мощный канцерогенный эффект, вызывать мутагенез, и при этом являться очень ядовитыми.
ПАУ образуются в результате процессов высокотемпературной деструкции и риформинга биологической массы, особенно при жарке мяса (включая и рыбу) и мясных продуктов (например, барбекю или шашлыка из мяса, с повышенным содержанием жиров или холестерина).
Долговременное потребление продуктов с повышенным содержанием ПАУ может иметь риск развития онкологических заболеваний ЖКТ, в меньшей степени лёгких и половой системы.
Некоторые канцерогенные ПАУ




pyrene.svg.png) Дибензо(а,i)пирен
Дибензо(а,i)пирен
Радиоактивные контаминанты

Радиоактивные контаминанты представляют собой особую группу, которая включает природные радиоактивные элементы (уран, торий, радий, полоний, протактиний и многие другие) и их соединения, а также радионуклиды антропогенного происхождения, таких, как например, короткоживущий изотоп 131I (Т1/2 = 8 суток), и более продолжительно живущие 90Sr (Т1/2 ~ 29,15 лет), 137Cs (Т1/2 ~ 30,2 лет), 239Pu (Т1/2 ~ 24,4 тыс. лет). Космогенные радионуклиды не рассматриваются, так как их вклад в контаминацию пищевых продуктов и кормов крайне мал (менее 10−5 %).
Главный путь попадания внутрь организма радиоактивных веществ — через ЖКТ. С пищей в организм животных и человека поступает от 60 до 90 % радионуклидов. Радиоизотопы, попавшие в организм человека, называют инкорпорированными.
Участь радиоактивных веществ в животном организме не отличается от таковой обычных химических элементов, входящих в состав пищи. Поступая в ЖКТ, пищевые продукты подвергаются механической и биологической обработке, превращаясь в соединения, которые могут быть усвоены организмом. В процессе метаболизма с участием радиоактивных веществ различают два этапа.
Первый этап — переход радиоактивных веществ в удобные для усвоения формы. Для этого в ЖКТ существуют все благоприятные условия: способность к механическому разрушению и измельчению пищи в ротовой полости и желудке; большое количество разнообразных ферментов, осуществляющих начальные стадии расщепления белков, жиров и углеводов на более простые соединения; кислая среда, обеспечиваемая за счёт содержания соляной кислоты желудочного сока, которая способствует переходу радиоактивных веществ в легко усваиваемые состояния.
Второй этап — всасывание радиоактивных веществ. Установлено, что они поглощаются практически на всём протяжении ЖКТ, хотя интенсивность этого процесса в различных его отделах неодинакова: в желудке, слепой и двенадцатиперстной кишках она минимальна, в толстой, тощей и подвздошной кишках — средняя и в прямой кишке — максимальна. Процесс всасывания зависит от очень многих условий, в частности, характера пищи, её количества, степени загрязнения радиоактивными веществами, их растворимости. Но главными факторами, определяющими биологическую подвижность радиоактивных веществ в животном организме, в том числе и всасывание, являются их физико-химические характеристики, формы соединений, вид животного, его возраст, физиологическое состояние. Радиоактивные вещества, всосавшиеся в кровь, распространяются с её током по организму, где частично задерживаются, избирательно концентрируясь в отдельных органах и тканях. Однако большая их часть сразу же выводится из организма.
Участь радионуклидов, включившихся в метаболизм, неодинакова. Как правило, они задерживаются в тех органах и тканях, в состав которых входят их нерадиоактивные изотопы или химические аналоги. Поскольку химический состав тканей животных изучен довольно хорошо, можно с уверенностью предположить, в какие именно части организма попадёт тот или иной радионуклид. Выделяют три основных типа распределения радионуклидов в организме позвоночных животных: скелетный, ретикуло-эндотелиальный и диффузный. Скелетный, или остеотропный тип характерен в первую очередь радиоактивным изотопам щелочноземельной группы, главным представителем которой являются изотопы кальция и его химического аналога стронция. В минеральной части скелета накапливаются также изотопы бария, радия, плутония, урана, бериллия, циркония, иттрия. Ретикулоэндотелиальное распределение характерно для радиоактивных изотопов редкоземельных металлов: церия, празеодима, прометия, а также цинка, тория, некоторых трансурановых элементов. Диффузный тип присущ изотопам щелочных элементов: калию, натрию, цезию, рубидию, а также водороду, азоту, углероду, полонию и некоторым другим.
Воздействие радиоактивных контаминантов

В отличие от внешнего облучения опасность радионуклидов, попавших внутрь организма, обусловлена следующими причинами.
Первая — способность селективного (избирательного) накопления некоторых радионуклидов в отдельных органах и тканях, называемые критическими (например, радиоизотоп 131I, который способен накапливаться в достаточно больших количествах в щитовидной железе (до 30 %), при этом она имеет массу всего ~ 0,03 % от массы тела человека), и, таким образом, отдавать свою энергию относительно небольшому объёму ткани (по сравнению с объёмом тела), создавая высокие локальные дозы излучения.
Вторая — значительное время облучения до момента выведения радионуклида из организма или уменьшение активности вследствие распада. Для характеристики сроков пребывания в организме отдельных радионуклидов существует понятие периода их полувыведения. Период полувыведения (биологический) Тб — это время, в течение которого радиоактивность нуклида, накопленного в организме (или в отдельном органе), уменьшается в два раза в ходе естественных процессов обмена и выделения.
Третья — высокая опасность воздействия ионизирующих α- и β-частиц, которые несущественны при внешнем облучении, вследствие низкой проницаемости.
В таблице 1 показаны некоторые радиоизотопы, которые могут проникнуть в организм человека с пищей, места накопления (депонирования), их периоды полураспада и полувыведения.
| Радиоизотоп | Место депонирования | Период полураспада, T1/2 | Период полувыведения, Тб |
|---|---|---|---|
| 3H | Всё тело | 12,32 года | 12 сут. |
| 14С | Всё тело | 5730 лет | 10 сут. |
| ---- | Кости | 5730 лет | 40 сут. |
| 24Na | Всё тело | 14,96 ч. | 11 сут. |
| 32P | Всё тело | 14,3 сут. | 267 сут. |
| ---- | Кости | 14,3 сут. | 3,16 года |
| 35S | Всё тело | 87,51 сут. | 90 сут. |
| ---- | Кости | 87, 51 сут. | 1,7 года |
| 42K | Всё тело | 12,36 ч. | 58 сут. |
| 60Co | Всё тело | 5,27 года | 9,6 сут. |
| 90Sr | Кости | 29 лет | 50 лет |
| 131I | Всё тело | 8 сут. | 138 сут. |
| ---- | Щитовидная железа | 8 сут. | 138 сут. |
| 137Cs | Всё тело | 30,16 года | 70,3 сут |
| 140Ba | Всё тело | 12,75 сут. | 65 сут. |
| 210Po | Всё тело | 138,37 сут. | 30 сут. |
| 226Ra | Кости | 1600 лет | 44,5 лет |
| 235U | Всё тело | 7,12×108лет | 100 сут. |
| ---- | Кости | 7,12×108лет | 300 сут. |
| 239Pu | Всё тело | 2,44×104 лет | 178 лет |
| ---- | Кости | 2,44×104 лет | 200 лет |
| 241Am | Кости | 432,6 года | 32 года |
| 242Cm | Кости | 162,8 сут. | 30 лет |
Основные негативные биологические эффекты радиоактивных контаминантов проявляются в высокой ионизации пищевых продуктов, так как большинство живых клеток организма человека высокочувствительны к ней (в особенности это клетки активно делящихся тканей — миелодной, лимфоидной, слизистых оболочек и половых желёз, а также эмбриональной у зародышей). Радиоактивные соединения, попадают внутрь организма вместе с контаминированными продуктами, где в результате ионизации и избыточного образования токсичных перекисных соединений, возникают цепные реакции сильно перегружающие антиоксидантную систему, что приводит к негативным последствиям, например, к таким, как серьёзные поражения органов ЖКТ (особенно печени, так как в ней происходят процессы депонирования и обезвреживание образовавших токсичных продуктов). Токсичные перекисные соединения и свободные радикалы способствуют разрушению нативных структур молекул нуклеиновых кислот (ДНК, РНК), липидов мембран клеток, белков и ферментов. За счёт гибели клеток происходят процессы снижения или подавления репродуктивной функции (гипоспермия, азоспермия, бесплодие и др.).

2. Физико-химическая стадия. Перераспределение избыточной энергии между возбуждёнными молекулами.
3. Химическая стадия. Взаимодействие активных продуктов друг с другом и с окружающими молекулами[175]
Долговременное (хроническое) поступление и воздействие или однократная большая концентрация высокорадиоактивного контаминанта (например, 226Ra) способствует массовой гибели клеток тканей, дегенерации и/или канцерогенезу, мутагенезу, тератогенезу (в клетках эмбриона), снижению функций эндокринной системы (например, в щитовидной железе селективно депонируется радиоизотоп йод-131), накоплению в мышцах, костных тканях и дальнейшему усилению дегенерации миелоидной ткани, как следствие — лучевая болезнь, лейкозы и другие злокачественные новообразования системы гемопоэза (кроветворения), соединительных тканей (кости, хрящи, суставы итд.), а также сердечно-сосудистой, эндокринной и половой систем. Особенно опасен в этом отношении остеотропный стронций-90, который легко замещает кальций в костях, тем самым повышается риск возникновения их ломкости (остеомаляция, остеопороз), а также приводит к возникновению радиогенной остеосаркомы (вследствие высокой активности).
Таким образом, эффект облучения радиоактивными контаминантами зависит от поглощённой дозы и временного распределения её в организме. Облучение может вызвать повреждения от незначительных, не дающих клинической картины, до летальных. Однократное острое, а также пролонгированное (долгого действия), дробное или хроническое облучение увеличивают риск возникновения дистанционных (отдалённых) эффектов — злокачественных опухолей и генетических мутаций (генетических заболеваний).
Радиочувствительность тканей и органов человека
Радиочувствительность — это свойство восприимчивости клеток, тканей, органов или организмов к воздействию ионизирующего излучения. Противоположным термином является радиоустойчивость (радиорезистентость).
Количественной характеристикой радиочувствительности является доза излучения, преводящая к определённой гибели облучаемого объекта (организма). Измеряется в LD50.
Радиочувствительность ткани прямо пропорциональна пролиферативной активности и обратно пропорциональна степени дифференцированности составляющих её клеток. Эта закономерность по имени учёных, открывших её в 1906 году, получила в радиобиологии название «правило Бергонье — Трибондо». Радиочувствительность лимфоцитов не соответствует этому правилу.
В порядке убывающей радиочувствительности все органы и ткани организма человека подразделяются на группы критических органов, то есть органов, тканей, частей тела или всего тела, облучение которых в данных условиях наиболее существенно в отношении возможного ущерба здоровью.
К радиорезистентным тканям относятся соединительные ткани: костная (у взрослых), хрящевая (у взрослых), плотная волокнистая — сухожилия, связки, мышечная ткань, а также нервная ткань. Абсолютно устойчивой является жировая ткань (устойчива к облучению 200—400 Гр и выше).
К средней радиочувствительности относятся: ткани желёз эндокринной системы (кроме половых) — гипофиза, щитовидной (кроме депонирования в ней радиойода) и поджелудочной железы, кожи, сосуды и миокард сердца.
К высокорадиочувствительным тканям относятся: лимфоидная, миелоидная, ткани тонкого кишечника и половых желёз.
Эмбрион и плод. Наиболее серьёзные последствия облучения — гибель до или во время родов, задержка развития, аномалии многих тканей и органов тела, возникновение опухолей в первые годы жизни.
Органы зрения. Известны 2 вида поражения органов зрения — воспалительные процессы конъюнктивы и катаракта при дозе 6 Гр у человека.
Радиотоксичность
Все радиоактивные изотопы в зависимости от вреда, который они могут нанести здоровью человека, условно разделены на четыре группы радиотоксичности (+ дополнительная группа, которая включает изотопы с очень низкими значениями радиотоксичности).
Радиотоксичность — это свойство радиоактивных изотопов вызывать патологические изменения при попадании в организм. Вред радиоактивного изотопа определяется характером радиоактивного распада, типом и энергией излучения, периодом полураспада, участием его в процессах метаболизма и некоторыми другими факторами. Наиболее опасными из них являются изотопы с высокой энергией излучения, высокой плотностью ионизации, продолжительными периодами полураспада и полувыведения, способностью накапливаться в больших количествах в определённых органах и тканях организма, особенно в критических. В основе классификации лежит величина минимально значимой радиоактивности на рабочем месте (примеры показаны в таблице 2.).
| Группа опасности | Примеры изотопов | Суммарная активность на рабочем месте, кБк |
|---|---|---|
| Группа А (особо радиотоксичные) | 210Рb, 210Po, 226Ra, 228Th, 230Th, 232Th, 232U, 237Np, 238Pu, 239Pu, 241Am, 242Cm | < 1,0 |
| Группа Б (высоко радиотоксичные) | 90Sr, 106Ru, 124Sb, 126I, 129I, 131I, 134Cs, 137Cs,144Ce, 170Tm, 210Bi, 223Ra, 224Ra, 227Th, 234Th, 230U, 233U, 234U, 235U, 241Pu | < 10,0 |
| Группа В (со средней радиотоксичностью) | 22Na, 24Na, 32P, 35S, 36Cl, 54Mn, 56Mn, 59Fe, 60Co, 82Br, 89Sr, 91Y, 90Y, 95Nb, 95Zr, 105Ru, 125Sb, 132I, 133I, 134I, 141Ce, 171Tm, 203Pb, 206Bi, 231Th, 239Np | < 100,0 |
| Группа Г (с малой радиотоксичностью) | 14C, 38Cl, 55Fe, 64Cu, 69Zn, 71Ge, 91mY, 97Zr, 96mTc, 99mTc, 131Cs, 134mCs, 136Cs | < 1000,0 |
| Группа Д (дополнительная, с очень малой радиотоксичностью) | 3H | 1000,0 |
Такое разделение радиоактивных изотопов по группам радиотоксичности носит довольно условный характер, потому что степень их вреда может определяться не только вышеперечисленными, но и некоторыми другими факторами. В частности, она весьма существенно может зависеть от химического соединения, вещества, в состав которого входит радиоактивный изотоп. Так, например, тритий (3Н) — низкоэнергетический β-излучатель, средняя длина пробега частиц которого в ткани составляет всего 1 мкм, отнесён к группе Д. Действительно, попав в организм в составе воды (3Н2О), он через несколько недель практически полностью выводится, не нанеся существенного вреда. Но, поступив в составе меченых нуклеотидов или нуклеозидов, которые часто используются в научных исследованиях, может концентрироваться в ДНК, нанося ей существенное повреждение. В этой ситуации по своей токсичности он может быть приравнен к изотопам группы Б и даже А. То же самое относится к 14С и некоторым другим радиоактивным изотопам.
Противорадиационные меры защиты питания
Важнейшим фактором предотвращения накопления радионуклидов в организме людей является питание. Это и употребление в пищу определённых продуктов и их отдельных компонентов. Особенно это касается защиты организма от долгоживущих радионуклидов, которые способны мигрировать по пищевым цепям, накапливаться в органах и тканях, подвергать хроническому облучению костный мозг, костную ткань и т. п. Установлено, что обогащение рациона рыбой, кальцием, фтором, витаминами А, Е, С, которые являются антиоксидантами, а также неусвояемыми углеводами (пектин), способствует снижению риска онкологических заболеваний, играет большую роль в профилактике радиоактивного воздействия наряду с радиопротекторами, к которым относятся вещества различной химической природы, в том числе и серосодержащие соединения, такие как цистеин и глутатион.
Существует современная концепция радиозащитного питания, которая базируется на трёх основных положениях:
- максимально возможное уменьшение поступления радионуклидов с пищей;
- торможение процессов сорбции и накопления радионуклидов в организме;
- соблюдение принципов рационального питания.
Нормы радиационной безопасности
В Российской федерации содержание радионуклидов в пищевых продуктах регламентируется согласно СанПиН 2.3.2.1078-01 «Гигиенические требования безопасности и пищевой ценности пищевых продуктов». Радиационная безопасность пищевых продуктов по цезию-137 и стронцию-90 определяется их допустимыми уровнями удельной активности радионуклидов, установленными СанПиН 2.3.2.1078-01. Радиационная безопасность продуктов, загрязнённых другими радионуклидами, определяется СанПиН 2.6.1.2523-09 «Нормы радиационной безопасности» (НРБ-99/2009).
Контаминация пищевых продуктов
Контаминация пищевых продуктов — процесс загрязнения контаминантами, приводящий к нецелесообразности употребления, порчи и изменениям органолептических свойств продуктов (изменение вкуса, внешнего вида, консистенции, запаха, цвета и, как следствие снижение пищевой ценности) и повышения опасности для здоровья и жизни, в случае алиментарного применения (употребления) данных продуктов питания. В большинстве случаев загрязнение пищевого продукта контаминантами является причиной алиментарных расстройств желудочно-кишечного тракта человека (пищевые интоксикации).
Контаминанты обладают высокой подвижностью и скоростью миграции и, тем самым довольно легко проникают в организм человека из внешней среды[176].
Существует большое количество путей поступления контаминантов из внешней среды в сырьё и пищевые продукты. Основные из них:
- Почвенный, таким путём в растительное сырьё и сельскохозяйственные продукты проникают нитраты, тяжёлые металлы и их соединения, хлорорганические пестициды, диоксины, радионуклиды.
- Водный, примером служат наличие вируса гепатита A в питьевой воде или пресноводные и морские виды рыб, а также морепродукты (крабы, моллюски и др.), которые способные накапливать тяжёлые металлы, пестициды, нефтепродукты, ПАВ, ртутьорганические соединения, и многие другие контаминанты
- Воздушный, характерен для процессов возделывания сельскохозяйственных культур, которые могут поглощать из воздуха многие токсичные вещества — диоксины, нитрозные газы, аммиак, формальдегид, пестициды в виде аэрозоля и многие другие.
Помимо указанных путей, контаминанты могут проникать в пищевые продукты и во время технологической обработки. Следовательно, контаминация может происходить практически на всех этапах производства, хранения и транспортировки (реализации) пищевых продуктов.
Также возможна преднамерная и диверсионная контаминация, направленные на устранение нежелательных физических лиц (путём отравления пищевых продуктов биологическими агентами, радионуклидами или боевыми отравляющими веществами, например, отравление Литвиненко полонием-210, отравление Ющенко диоксинами) и нанесение серьёзного урона продовольственной безопасности государству (используются также различные биологические, химические или радиоактивные контаминанты).
Действия контаминантов на организм человека


На организм человека, действия оказываемые контаминантами, подразделяются на:
- ближайшие — проявляются довольно быстро по времени (не более 6 часов, некоторые всего за несколько минут) в виде острых токсикозов (пищевых отравлений, например, вызванные повышенным содержанием в продуктах питания нитратов или микотоксинов) или инфекционными заболеваниями (сальмонеллёз, ботулизм, амёбиаз, холера итд.), аллергических и специфических иммуннологических реакциях (ангионевротический отёк, бронхоспазм, анафилаксия, агглютинация);
- отдалённые или дистанционные — довольно продолжительные по времени (более 2-3 суток, месяцы или в некоторых случаях более 1-2 лет), примером служат: иммуносупрессивное, канцерогенное, мутагенное, тератогенное или политропное воздействие (множественное) на органы, систему органов или даже на весь организм человека (апластическая анемия, хронический афлатоксикоз, болезнь Минамата, итд.).
Количественной характеристикой токсического воздействия контаминантов является ЛД50. По токсическому воздействию (значения ЛД50 даны в мг/кг) контаминанты делятся на:
- Низкотоксичные (слаботоксичные) (>1500)
- Умеренно-токсичные (1500—150)
- Высокотоксичные (150-15)
- Чрезвычайно токсичные (<15).
Большую опасность представляют высокотоксичные и чрезвычайно токсичные контаминанты, которые могут оказывать негативные воздействия в крайне низких концентрациях (10−2−10−6 кг и менее на кг веса).
Патофизиологические эффекты, оказываемые контаминантами
![Токсоплазма (Toxoplasma gondii) — самый распространённый паразит-простейшее, который может попадать в организм человека через пищевые продукты (животного происхождения). Вызывает токсоплазмоз, который приводит к тератогенному эффекту (уродства), олигофрении, поражениям нервной системы или гибели плода, у взрослых в острой форме протекает подобно брюшному тифу, с увеличением некоторых внутренних органов (печени, селезёнки), температурой или с поражением нервной системы, может протекать и бессимптомно. Токсоплазмы также обладают свойствами влиять на сознание организма носителя[источник не указан 739 дней]](./Toxoplasma_gondii_tachy.jpg) Токсоплазма (Toxoplasma gondii) — самый распространённый паразит-простейшее, который может попадать в организм человека через пищевые продукты (животного происхождения). Вызывает токсоплазмоз, который приводит к тератогенному эффекту (уродства), олигофрении, поражениям нервной системы или гибели плода, у взрослых в острой форме протекает подобно брюшному тифу, с увеличением некоторых внутренних органов (печени, селезёнки), температурой или с поражением нервной системы, может протекать и бессимптомно. Токсоплазмы также обладают свойствами влиять на сознание организма носителя
Токсоплазма (Toxoplasma gondii) — самый распространённый паразит-простейшее, который может попадать в организм человека через пищевые продукты (животного происхождения). Вызывает токсоплазмоз, который приводит к тератогенному эффекту (уродства), олигофрении, поражениям нервной системы или гибели плода, у взрослых в острой форме протекает подобно брюшному тифу, с увеличением некоторых внутренних органов (печени, селезёнки), температурой или с поражением нервной системы, может протекать и бессимптомно. Токсоплазмы также обладают свойствами влиять на сознание организма носителя Аспергилл жёлтый (Aspergillus flavus) или просто жёлтая плесень, один из самых распространённых (организм-космополит) токсинообразующих плесневых грибов-микромицетов. Продуцирует сильнейшие гепатоканцерогены и гепатотоксины — афлатоксины, опасен и патогенен для животных и человека[178]. Контаминирует многие пищевые продукты и сырьё, но в основном растительного происхождения (субстратом служат продукты с повышенным содержанием крахмала и растительных масел — зерновые, бобовые, масличные культуры, некоторые виды сухофруктов итд.). Токсинообразование происходит при довольно высоких значениях влажности и температуры[179]
Аспергилл жёлтый (Aspergillus flavus) или просто жёлтая плесень, один из самых распространённых (организм-космополит) токсинообразующих плесневых грибов-микромицетов. Продуцирует сильнейшие гепатоканцерогены и гепатотоксины — афлатоксины, опасен и патогенен для животных и человека[178]. Контаминирует многие пищевые продукты и сырьё, но в основном растительного происхождения (субстратом служат продукты с повышенным содержанием крахмала и растительных масел — зерновые, бобовые, масличные культуры, некоторые виды сухофруктов итд.). Токсинообразование происходит при довольно высоких значениях влажности и температуры[179] Бледная поганка (Amanita phalloides) может быть очень похожа на некоторые виды съедобных грибов (например, на шампиньоны или сыроежки), для неё характерен приятный вкус. Однако гриб содержит в себе токсины, которые не разрушаются при термической обработке и обладают сильнейшей гепатотоксичностью, вызывают дегенерацию, разрушение и некролитическую смерть клеток печени. Опасностью отравления является долгий период бессимптомного протекания (более 10 часов). Летальный исход при отравлении бледной поганкой довольно высок
Бледная поганка (Amanita phalloides) может быть очень похожа на некоторые виды съедобных грибов (например, на шампиньоны или сыроежки), для неё характерен приятный вкус. Однако гриб содержит в себе токсины, которые не разрушаются при термической обработке и обладают сильнейшей гепатотоксичностью, вызывают дегенерацию, разрушение и некролитическую смерть клеток печени. Опасностью отравления является долгий период бессимптомного протекания (более 10 часов). Летальный исход при отравлении бледной поганкой довольно высок Тихоокеанские устрицы (Magallana gigas) могут накапливать в себе смертельно опасные дозы нейротоксичных соединений (от 400 мкг до 15000-25000 мкг), главным из которых является сакситоксин. Помимо этого, у некоторых групп людей, при поедании мяса устриц (оно содержит специфические антигены), провоцируется сильная и скоротечная аллергенная реакция — анафилаксия, которая может стать причиной летального исхода
Тихоокеанские устрицы (Magallana gigas) могут накапливать в себе смертельно опасные дозы нейротоксичных соединений (от 400 мкг до 15000-25000 мкг), главным из которых является сакситоксин. Помимо этого, у некоторых групп людей, при поедании мяса устриц (оно содержит специфические антигены), провоцируется сильная и скоротечная аллергенная реакция — анафилаксия, которая может стать причиной летального исхода- На микрофотографии представлена одна из форм дизентерийной амёбы — трофозоиты, которые поглощают эритроциты крови. Дизентерийная амёба (Entamoeba histolytica) — опасный биологический контаминант, попав во внутрь толстого кишечника она, приступает к разрушению слизистой оболочки кишечника, вызывая кровотечения, диарею, деструкцию (разрушение) слизистой и некролитические процессы (язвы, отторжения слизистой, гнойное поражение, некрозы)
- Спорынья (Claviceps purpurea), паразитирующая на колосе ржи. Хлеб, выпеченный из муки, контаминированной алкалоидами спорыньи (лизергиновая кислота, эрготамин, эргин (лизергамид), эргометрин и др.)[180][181] вызывает сильнейшее отравление — эрготизм
 Вирус гепатита A (НVA), возбудитель вирусного гепатита A (болезнь Боткина), РНК-содержащий вирус относится к семейству Picornaviridae[182]. Данный вирус высококонтагиозный (опасен для человека, так как может вызвать гепатит B большинстве случаев заражения), обладает высокой устойчивостью к действию хлора, поэтому способен проникать в водопроводную воду через барьеры водоочистных сооружений[183]
Вирус гепатита A (НVA), возбудитель вирусного гепатита A (болезнь Боткина), РНК-содержащий вирус относится к семейству Picornaviridae[182]. Данный вирус высококонтагиозный (опасен для человека, так как может вызвать гепатит B большинстве случаев заражения), обладает высокой устойчивостью к действию хлора, поэтому способен проникать в водопроводную воду через барьеры водоочистных сооружений[183] Тихоокеанский голубой тунец (Thunnus orientalis) — один из основных источников ртутьорганических соединений[184]. Мясо тунца, как и многих морских хищных рыб может накапливать большие дозы метилртути (от 1500 до 20 000 мкг/кг)
Тихоокеанский голубой тунец (Thunnus orientalis) — один из основных источников ртутьорганических соединений[184]. Мясо тунца, как и многих морских хищных рыб может накапливать большие дозы метилртути (от 1500 до 20 000 мкг/кг)
Наиболее частые патофизиологические эффекты, оказываемые контаминантами:
- Токсичность — свойство негативно влиять на физиологические и биохимические процессы, протекающих в нормальных клетках, результатом которого является обратимые или необратимые изменения, нарушения или даже ингибирование (подавление) данных процессов, и как следствие смерть клеток и организма в целом. Многие, если не большинство контаминантов обладают токсичностью. Токсичность зависит от целого ряда физиологических и токсико-химических факторов, главные из которых, возраст, пол, количество токсичных веществ поступивших в организм, период действия, период выведения, тропность, комплексообразование, способность к гидролизу, биоаккумуляция, тканевая или органная специфичность и другие.
- Альтеративный воспалительный процесс — нарушения целостности структуры клеток т.е их повреждения, возникающие в результате воздействия биологических агентов и/или химических соединений (включая радиоактивные) и, последующие за ними некролитический путь смерти, деструктивных клеток. Многие контаминанты обладают альтеративным эффектом.
- Канцерогенное воздействие или канцерогенность — свойство химических и радиоактивных соединений или их смесей, а также биологических агентов, включая вирусы вызывать злокачественные заболевания организма человека. К этой группе относятся ПАУ, которые образуются в результате термической обработки (при жарке) мяса и продуктов из неё (копчённости), нитрозамины[185](образуются из нитратов и нитритов), ароматические амины, диоксины и диоксибензофураны (в частности 2,3,7,8-ТХДД), соединения мышьяка, кадмия и шестивалентного хрома, афлатоксины, бензол, стронций-90, этанол (при долговременном употреблении).
- Мутагенное воздействие или мутагенность — свойство негативного воздействия химических соединений, физических факторов или биологических агентов на генетический аппарат клеток, следствием которого являются мутации. Генотоксичность — предельная форма мутагенности, при которой происходят нарушения целостности структуры молекул ДНК (вследствие встраивания ксенобиотических молекул в молекулу ДНК — ковалентного или интеркаляции), вплоть до утраты генов или деструкции (разрушения). Часто мутагены могут быть канцерогенами и/или тератогенами. Многие диоксины, и в особенности ТХДД являются сильными мутагенами, такими же свойствами обладают многие ароматические углеводороды и их производные (бензол, ДМБА, метилхолантрен) и органические перекисные соединения.
- Иммуносупрессия или иммунодепрессивный эффект выражается в частичном (вторичные иммунодефицитные состояния или ВИДС) или полном подавлении функций иммунной системы[186][187] (например, иммунодефицитный микотоксикоз). Данным эффектом обладают многие микотоксины, диоксины, некоторые виды вирусов.
- Тератогенное воздействие — негативный эффект воздействия тератогенов на генетический аппарат плода, результатом, которого являются мутации и аномальные морфологические изменения тела (врождённые уродства). Диоксины обладают высоким тератогенным и эмбриотоксичным воздействием, также этим воздействием обладают охратоксины, многие канцерогены, например, метилхолантрен.
- Аллергическое воздействие — происходит при действии специфических антигенов, вызывающих аллергическую реакцию. Некоторые аллергические реакции могут быть очень быстрыми и опасными для жизни, как, например, анафилаксия. Примером могут служить антигены некоторых видов двустворчатых моллюсков (мидии, устрицы и др.), морских рыб, молока, арахиса, употребляемых в пищу.
- Гепатотоксичность — негативный эффект воздействия некоторых биологических агентов, физических факторов и химических соединений на клетки паренхимы печени — гепатоциты. Выражается в дегенерации и некролитическом процессе гибели клеток паренхимы печени, как следствие гепатиты и цирроз. Гепатотоксичностью обладает некоторые микотоксины (афлатоксины, Т-2 токсин, патулин), токсины бледной поганки, этанол, вирусы гепатита.
- Нейротоксичность — свойство химических соединений негативно влиять (вплоть до летального исхода) на процессы и функции клеток (нейроны) центральной и периферической нервной системы[188]. Одними из следствий такого влияния являются повреждения нервной ткани, судороги, парезы и параличи. Например, метанол обладает нейродегенеративным воздействием на зрительный нерв и необратимо поражает его, также этим воздействием обладают некоторые алкалоиды (стрихнин, никотин, кониин и др.), пестициды (группы альдрина, фосфорорганические соединения), некоторые токсины бактерий (ботулотоксин) и беспозвоночных (тетродотоксин, октопотоксины, сакситоксин итд.), ртутьорганические соединения.
- Нефротоксичность — негативный эффект воздействия химических соединений или биологических агентов на структурно-функциональные единицы почки (нефроны), следствием которого являются повреждения нефронов и/или их смерть. Охратоксины, тяжёлые металлы, соединения мышьяка (арсин и др.), аматоксины проявляют нефротоксические свойства.
- Гематотоксичность — негативный эффект от воздействия различных химических соединений (включая радиоактивные) и/или биологических агентов (включая их продукты метаболизма) на функции клеток крови, их качественные характеристики и состав. Например, нитраты и особенно нитриты, а также органические нитросоединения (нитробензол) обладают гематотоксичностью, вызывают резкое падение уровня гемоглобина (метгемоглобинемия) в эритроцитах, переводя его в неактивную для переноса кислорода форму, дафнин является антивитамином К и вызывает геморрагии и повышает время свёртываемости крови, бензол вызывает лейкопении и гемолитическую анемию, такими же свойствами обладает и анилин, но действует гораздо медленнее. Миелотоксичность является частным случаем гематотоксичности и выражается в негативном эффекте воздействия химических соединений, радионуклидов или биологических агентов на клетки миелоидной ткани красного костного мозга, повреждая их вплоть до полной деструкции (разрушения структур) или трансформации в опухолевые.
- Антибиотическое действие — негативный эффект воздействия на микрофлору кишечника биологически активных соединений, следствием которого является снижение числа бактерий кишечника вплоть до полной стерилизации. Многие антибиотики обладают низкой селективностью, и могут существенно влиять на количество бактериальной микрофлоры, данное свойство крайне негативно сказывается на функционировании ЖКТ (дисбактериоз, диарея, нарушения электролитного баланса, итд.). Помимо антибиотиков, данным эффектов обладают сульфаниламидные препараты, препараты нитрофурана и другие.
- Цитотоксичность — свойство химических соединений, физических факторов и/или биологических агентов негативно воздействовать на определённые виды клеток (например на клетки энтероцитов), вызывая их повреждения или смерть. Таким свойством обладают токсины Коли и токсины бледной поганки.
- Политропия или политропное воздействие, также эффект комбинированного воздействия — негативный эффект воздействия токсичных соединений или биологических агентов на многие органы, систему органов или на весь организм. Включает в себя совокупность разнообразных патофизиологических процессов и поэтому является наиболее опасным для здоровья или жизни человека. Таким свойством обладают некоторые радиоактивные элементы, диоксины, тяжёлые металлы и их соединения (ртуть, свинец, таллий, радий, полоний итд.), некоторые радионуклиды.
Причины контаминации пищевых продуктов
Основные причины, из-за которых возникает контаминация пищевых продуктов это не соблюдение или нарушения, а также отсутствие систем менеджмента безопасности и стандартов качества пищевых продуктов (HACCP, ISO 22000:2005 итд.), ГОСТов, санитарно-гигиенических норм и правил (СанПиН) или иных нормативно-правовых актов, установленных и контролируемых действующим законодательством государства, происходящих при обработке сырья или производстве пищевых продуктов.

Гигиенический аспект контаминации пищевых продуктов непосредственно сопряжён с экономическим. Обеспечение большинства населения стран Африки, Латинской Америки, некоторых стран Азии (Индия, Бангладеш, Индонезия итд.) чистой питьевой водой и продовольственными продуктами является одной из самых сложных проблем. Во многих регионах Африки и Азии, нерациональное использование водных ресурсов (загрязнение воды продуктами жизнедеятельности и/или нефтепродуктами, сложность процесса очистки или вовсе её отсутствие), частое применение пестицидов в сельском хозяйстве, отражается на качестве продуктов питания (низкая пищевая ценность, большое количество контаминантов, как следствие частые интоксикации и высокий уровень смертности), происходят частые инфекционные заболевания (холера, амёбиаз, брюшной тиф, кишечные токсоинфекции, итд.), наблюдается низкая осведомлённость населения об использовании чистой питьевой воды (в некоторых регионах Африки она отсутствует) и использовании воды в процессах кулинарной обработки (вода обычно неочищенная (не проходит процессы очистки) и практически не пригодна для употребления, так как содержит большое количество контаминантов различного происхождения).
Экономический аспект также играет важную роль в обеспечении безопасности пищевой продукции и сырья. Наглядный пример демонстрирует корреляция между уровнем потребления контаминированных продуктов афлатоксинами (арахис, зерновые итд.) и заболеваемостью афлатоксикозом, в некоторых странах Африки (где у населения почти в 100 % случаев выявляются циррозное поражение печени и/или рак печени) и западной Европы (единичные случаи)[189]. Данная корреляция показывает на сколько может быть различными уровни продовольственной безопасности и развития медицины в государствах.
Проблема контаминации пищевых продуктов по мнению Всемирной организации продовольствия (ФАО) является одной из главнейших проблем человечества.
Безопасность пищевых продуктов
Под безопасностью пищевых продуктов понимается отсутствие опасности для здоровья и жизни человека при употреблении их, как с точки зрения опасности острого патофизиологического воздействия (пищевые интоксикации или токсоинфекции), так и с точки зрения опасности последствий отдалённого, хронического или долговременного воздействия (канцерогенность, мутагенное воздействие, иммунодепрессивный эффект, миелотоксичность и т. д.).
Пищевые продукты и сырьё являются источниками контаминантов, что влечёт за собой множественные риски для здоровья или жизни потребителя, вследствие этого необходимо проводить комплекс мер по обеспечению безопасности данной категории продуктов, к которым относят деконтаминацию. Деконтаминация как технологический процесс, направлена на удаление или полную инактивацию контаминантов в пищевых продуктах или сырьё, осуществляемую при помощи механических, физических, химических и/или комбинированных (смешанных) методов.
Механические методы деконтаминации
Механические методы деконтаминации наиболее простые и доступные, представляют собой использование механических процессов очистки, таких, как фильтрование или баромембранные процессы. Фильтрование позволяет очистить пищевые продукты от твёрдых частиц химических контаминантов. Баромембранные процессы служат для более глубокой очистки продукта, посредством обратного осмоса и ультрафильтрации.
Физические методы деконтаминации
Физические методы деконтаминации — использование теплового и волнового излучения. Тепловые или термические методы основываются на нагревании пищевых продуктов до определённой температуры, как правило кратковременно в специальных устройствах — пастеризаторах, стерилизаторах или автоклавах, при этом, процесс нагрева происходит с увеличением давления. Также к этому методу относят криоконсервацию, в результате которой происходит глубокая заморозка пищевых продуктов (производится жидким азотом).
Волновые методы основываются на применении электромагнитного излучения с высокой энергией, как правило, такие виды излучения имеют короткие длины волн, к ним относятся: УФ-лучи, рентгеновское или гамма-излучение. Большинство биологических агентов (бактерии, простейшие, микроскопические грибы) очень чувствительны к подобному роду воздействиям (УФ-лучи), что делает волновые процессы эффективными. Однако применение в процессе деконтаминации пищевых продуктов рентгеновского или более агрессивного гамма-излучения во многих странах запрещено. Нежелательные изменения, которые происходят в некоторых облучённых продуктах, могут быть вызваны непосредственно облучением или косвенно в результате пострадиационных реакций. Вода подвергается радиолизу при облучении следующим образом:
3Н2О → Н• + ОН• + Н2О2 + Н2.
Кроме того, свободные радикалы, образованные на всём протяжении пути первичного электрона, реагируют друг с другом, как в случае диффузии. Некоторые из продуктов, образованные вдоль линии прохождения электрона, могут реагировать со свободными молекулами. Облучение в анаэробных условиях несколько снижает образование неприятных запахов и привкусов из-за нехватки кислорода, участвующего в образовании пероксидов. Один из лучших способов минимизировать образование нежелательных ароматов — облучение при температурах подмораживания. Действие температур подмораживания должно уменьшить или остановить радиолиз и образование сопутствующих ему реагентов. Другие способы снижения побочных эффектов в продуктах представлены в таблице 1.
Кроме воды белки и другие азотсодержащие компоненты — самые чувствительные к действию облучения в продуктах. Продукты облучения аминокислот, пептидов и белков зависят от дозы радиации, температуры, количества кислорода, количества влаги и других факторов.
| Метод | Аргументация |
|---|---|
| Снижение температуры | Связывание свободных радикалов |
| Снижение давления кислорода | Сокращение числа окислительных свободных радикалов, активизирующих молекулы |
| Добавление поглотителей свободных радикалов | Конкуренция поглотителей за свободные радикалы |
| Дистилляция | Удаление летучих предшественников неприятных аромата и вкуса |
| Сокращение дозы | Очевидно[190] |
Химические методы деконтаминации
Химические методы деконтаминации — применение химических соединений, предотвращающих контаминацию пищевых продуктов биологическими агентами (условно-патогенные, патогенные бактерии, микроскопические плесневые грибы, биологически-активные продукты их метаболизма итд.). К таким соединениям относятся широко используемые консерванты, как, например, некоторые органические кислоты (уксусная, пропионовая, бензойная[191], сорбиновая итд.) и/или их соли (бензоат натрия, сорбат калия[192] итд.), а также поваренная соль (хлорид натрия), этиловый спирт, мёд или сахар (в высоких концентрациях 65—80 %). Консерванты создают неблагоприятную среду, подавляя рост, развитие и размножение биологических агентов (обладают бактериостатическим и фунгистатическим действиями)[193].
| Консервант | Бактерии | Дрожжи | Плесневые микромицеты |
|---|---|---|---|
| Нитриты | ++ | - | - |
| Неорганические сульфиты | ++ | ++ | + |
| Муравьиная кислота | + | ++ | ++ |
| Пропионовая кислота | + | ++ | ++ |
| Сорбиновая кислота | ++ | +++ | +++ |
| Бензойная кислота | ++ | +++ | +++ |
| Гидроксибензоаты | ++ | +++ | +++ |
| Дифенил | - | ++ | ++ |
| Примечание: — неэффективен; + малая эффективность; ++ средняя эффективность;
+++ высокая эффективность[194]. |
Использование агрессивных химических соединений, таких, как аммиак, формальдегид, гипохлорит натрия. Формальдегидом обрабатывают зёрна злаковых культур, используют в качестве фунгицида, однако, его наличие даже остаточного количества в зёрнах не допустимо. Гипохлорит натрия NaOCl, ввиду своих сильных окислительных свойств в нейтральной среде (молекула неустойчивая и выделяет сильнейший окислитель и биоцидное соединение — синглетный кислород[195]), также применяют в качестве деконтаминанта зерна, защищая его от опасных микромицетов (рода аспергилл, пеницилл, фузариум и т. д.). При этом гипохлорит натрия отлично инактивирует множественные токсины — ботулинистический, токсины морских животных, микотоксины и др[196].
Комбинированные методы деконтаминации

Комбинированные или смешанные методы деконтаминации представляют собой одновременное применение нескольких методов, например, физических совместно с химическими, тем самым повышая эффективность процесса. Являются наиболее оптимальными, приоритетными и действенными в производстве пищевых продуктов или сырья. В настоящее время использование комбинированных методов деконтаминации, позволяют снизить потенциальные риски, которые могут привести к ущербу здоровья человека, в случае контаминации или порчи пищевых продуктов или сырья во много раз, тем самым, обеспечивая безопасность и контроль качества.
Примером использования комбинированных методов служит производство сокосодержащей продукции (соков, нектаров, сокосодержащих напитков итд.), которая проходит различные стадии обработки, например, фильтрацию, стерилизацию/пастеризацию, добавление консервантов (сахара, соли сорбиновой или бензойной кислоты, ксилита, данная стадия используется, без предварительного процесса пастеризации и не является обязательной), гамма-облучение (в некоторых странах, включая страны СНГ и РФ, данная стадия не является обязательной), использование многослойной асептической упаковки (асептическая технология Тетра-Пак). Каждая, из перечисленных стадий увеличивает эффективность деконтаминации при их совместном и последовательном использовании, нежели, если они применяются разрозненно и не последовательно.
Обеспечение качества и безопасности пищевых продуктов
Обеспечение качества и безопасности пищевых продуктов является основной целью сохранения полноценного здоровья человека. Представляет собой комплекс мер, направленных на соответствие пищевых продуктов международным стандартам сертификации, включая этапы производства, транспортировки и хранения. Одним из таких стандартов является система ХАССП, внедрение которой на пищевом производстве позволяет максимально снизить все угрозы и риски, возникающие непосредственно во время процесса производства, повысить качество продукта и сохранить пищевую ценность[197].
В соответствии с решением № 880 от 9 декабря 2011 года Комиссии Таможенного союза Евразийского экономического сообщества с 1 июля 2013 года в Республике Беларусь, Республике Казахстан и Российской Федерации вступает в силу технический регламент Таможенного союза ТР ТС 021/2011 «О безопасности пищевой продукции». Согласно этому регламенту, внедрение принципов ХАССП для организаций, участвующих в цепи создания пищевой продукции, становится обязательным[198][199].
Примечания
- ↑ Светлана Евгеньевна Траубенберг, А.А. Кочеткова; Нечаев, Алексей Петрович. Пищевая химия. — 2-е. — Санкт-Петербург: ГИОРД, 2003. — С. 524. — 640 с. — 3000 экз. — ISBN 5-901065-38-0.
- ↑ Davidson, Alan. The Oxford Companion to Food. — Oxford University Press, 2006. — P. 324. — ISBN 978-0-19-280681-9.
- 1 2 Contaminant Definition & Meaning | Britannica Dictionary (амер. англ.). www.britannica.com. Дата обращения: 21 января 2025. Архивировано 16 августа 2022 года.
- 1 2 3 Загрязняющие примеси | CODEXALIMENTARIUS FAO-WHO. www.fao.org. Дата обращения: 21 января 2025. Архивировано 20 апреля 2025 года.
- 1 2 3 4 5 В.З. Тарантул. Толковый биотехнологический словарь. Русско-английский. — М.: Языки славянских культур, 2009.
- 1 2 3 4 Ветеринарно-санитарные правила применения, реализации, хранения и производства ветеринарных препаратов в Республике Беларусь, утвержденные постановлением Министерства сельского хозяйства и продовольствия Республики Беларусь от 17 марта 2011 г. № 16, с изменениями, внесенными постановлением Министерства сельского хозяйства и продовольствия Республики Беларусь от 27 июня 2017 г. № 36. Национальный центр законодательства и правовой информации Республики Беларусь. Министерство сельского хозяйства и продовольствия Республики Беларусь.
- 1 2 3 А. Котик, Труфанов О. В., Труфанова В. А. Словарь токсикологических терминов, Харьков: НТМТ, 2006.— 100 с.
- 1 2 Зилов Е. А. Химия окружающей среды: Учебное пособие. — Иркутск: Иркут. ун-т, 2006. — С. 49—56. — 176 с. — ISBN 5-9624-0091-7.
- 1 2 Definition of contaminant from the Cambridge Advanced Learner's Dictionary & Thesaurus © Cambridge University Press. Cambridge University Press & Assessment. Cambridge University Press. Дата обращения: 21 января 2025. Архивировано 21 декабря 2023 года.
- 1 2 3 4 5 Сотникова Е. В., Дмитренко В. П. Техносферная токсикология: Учебное пособие. — 2-е изд., испр. и доп. — СПб.: «Лань», 2022. — С. 10, 39—53, 111—120, 231—233, 242—243, 303—339. — 424 с. — ISBN 978-5-8114-1329-4.
- 1 2 Приложение № 2 к главе 4 Правил проведения исследований биологических лекарственных средств Евразийского экономического союза "Указания по расчету факторов снижения вирусной нагрузки", утвержденное решением Совета Евразийской экономической комиссии от 3 ноября 2016 г. № 89. Национальный центр законодательства и правовой информации Республики Беларусь. Официальный сайт Евразийского экономического союза (21 ноября 2016).
- 1 2 И.Г. Широких, А.А. Лещенко. СЛОВАРЬ МИКРОБИОЛОГИЧЕСКИХ ТЕРМИНОВ. — Киров, 2011. — С. 43. — 100 с.
- 1 2 3 Preface: Food—A necessity and a threat // Microbial Food Contamination / Wilson, C.L.. — CRC Press, 2008. — С. xi–xvi. — ISBN 9781420008470.
- ↑ Bohrer, D. Preface // Sources of Contamination in Medicinal Products and Medical Devices (англ.). — John Wiley & Sons, 2012. — ISBN 9781118449059.
- ↑ Rose, M. Environmental Contaminants // Encyclopedia of Meat Sciences / Dikeman, M.; Devine, C.. — 2nd. — Elsevier, 2014. — Т. 1. — С. 497—501. — ISBN 9780123847348.
- ↑ Midcalf, B. Pharmaceutical Isolators: A Guide to Their Application, Design and Control (англ.). — Pharmaceutical Press, 2004. — P. 88—89. — ISBN 9780853695738.
- ↑ Type I host resistance and Trichothecene Accumulation in Fusarium-infected Wheat Heads // American Journal of Agricultural and Biological Sciences. — 2011. — 1 февраля (т. 6, № 2). — С. 231—241. — ISSN 1557-4989. — doi:10.3844/ajabssp.2011.231.241.
- ↑ Beyer M., Klix M. B., Klink H., Verreet J.-A. Quantifying the effects of previous crop, tillage, cultivar and triazole fungicides on the deoxynivalenol content of wheat grain — a review // Journal of Plant Diseases and Protection. — 2006. — Декабрь (т. 113, № 6). — С. 241—246. — ISSN 1861-3829. — doi:10.1007/BF03356188.
- ↑ Ilic Z., Crawford D., Vakharia D., Egner P. A., Sell S. Glutathione-S-transferase A3 knockout mice are sensitive to acute cytotoxic and genotoxic effects of aflatoxin B1. (англ.) // Toxicology and applied pharmacology. — 2010. — Vol. 242, no. 3. — P. 241—246. — doi:10.1016/j.taap.2009.10.008. — PMID 19850059.
- ↑ Соланин // Энциклопедический словарь Брокгауза и Ефрона : в 86 т. (82 т. и 4 доп.). — СПб., 1890—1907.
- ↑ Yong Zhang, Cao Chen, Shuangli Zhu, Chang Shu, Dongyan Wang. Isolation of 2019-nCoV from a Stool Specimen of a Laboratory-Confirmed Case of the Coronavirus Disease 2019 (COVID-19) (англ.) // China CDC Weekly. — 2020-02-01. — Vol. 2, iss. 8. — P. 123—124. — ISSN 2096-7071. Архивировано 23 октября 2021 года.
- 1 2 3 Food Poisoning from Marine Toxins - Chapter 2 - 2018 Yellow Book (амер. англ.). CDC (2017). Дата обращения: 1 июня 2018. Архивировано 11 января 2019 года.
 Эта статья включает текст из этого источника, который находится в общественном достоянии.
Эта статья включает текст из этого источника, который находится в общественном достоянии. - ↑ Страйер Л. Биохимия. — М.: Мир, 1985. — Т. 3. — С. З24. — 400 с.
- ↑ Huot, R. I.; Armstrong, D. L.; Chanh, T. C. Protection against nerve toxicity by monoclonal antibodies to the sodium channel blocker tetrodotoxin (англ.) // Journal of Clinical Investigation : journal. — 1989. — June (vol. 83, no. 6). — P. 1821–1826. — doi:10.1172/JCI114087. — PMID 2542373. — PMC 303901.
- 1 2 Yang, SY; Kim, NH; Cho, YS; Lee, H; Kwon, HJ (2014). Convallatoxin, a dual inducer of autophagy and apoptosis, inhibits angiogenesis in vitro and in vivo. PLOS ONE. 9 (3): e91094. Bibcode:2014PLoSO...991094Y. doi:10.1371/journal.pone.0091094. PMC 3963847. PMID 24663328.
- ↑ Cheng, CJ; Lin, CS; Chang, LW; Lin, SH (2006). Perplexing hyperkalaemia. Nephrology Dialysis Transplantation. 21 (11): 3320–3323. doi:10.1093/ndt/gfl389. PMID 16968727.
- ↑ Schneider, NFZ; Silva, IT; Perish, L; de Carvalho, A; Rocha, SC; Marostica, L; Ramos, ACP; Taranto, AG; Pádua, RM (2017). Cytotoxic effects of the cardenolide convallatoxin and its Na, K-ATPase regulation. Molecular and Cellular Biochemistry. 428 (1–2): 23–29. doi:10.1007/s11010-016-2914-8. PMID 28176244. S2CID 1545339.
- ↑ M. Cochet-Meillhac; Chambon P. Animal DNA-dependent RNA polymerases. 11. Mechanism of the inhibition of RNA polymerases B by amatoxins (англ.) // Biochim Biophys Acta : journal. — 1974. — Vol. 353, no. 2. — P. 160–184. — doi:10.1016/0005-2787(74)90182-8. — PMID 4601749.
- ↑ Staphylococcal Food Poisoning. cdc.gov. hhs.gov (4 октября 2016). Дата обращения: 23 октября 2016. Архивировано 8 февраля 2016 года.
- ↑ «Staphylococcus.» Foodsafety.gov, U.S. Department of Health and Human Services, https://www.foodsafety.gov/poisoning/causes/bacteriaviruses/staphylococcus/ Архивная копия от 30 мая 2019 на Wayback Machine.
- ↑ Bergdoll, M.S. 1972. The enterotoxins. In The Staphylococci, ed. J.O. Cohen, 301—331. New York: Wiley-Interscience.
- ↑ Ryan, Kenneth J.; Ray, C. George. Sherris Medical Microbiology : an Introduction to Infectious Diseases (англ.). — 4th. — New York: McGraw-Hill Education, 2004. — P. 310. — ISBN 978-0-8385-8529-0.
- ↑ Kiu, R; Hall, L. J. An update on the human and animal enteric pathogen Clostridium perfringens (англ.) // Emerging Microbes and Infections : journal. — 2018. — Vol. 7, no. 141. — P. 141. — doi:10.1038/s41426-018-0144-8. — PMID 30082713. — PMC 6079034.
- ↑ Katahira J., Inoue N., Horiguchi Y., Matsuda M., Sugimoto N. Molecular cloning and functional characterization of the receptor for Clostridium perfringens enterotoxin (англ.) // J. Cell Biol. : journal. — 1997. — Vol. 136, no. 6. — P. 1239—1247. — doi:10.1083/jcb.136.6.1239. — PMID 9087440. — PMC 2132509.
- ↑ Janes L.E., Connor L.M., Moradi A., Alghoul M. Current Use of Cosmetic Toxins to Improve Facial Aesthetics. Plast. Reconstr. Surg.. 2021;:644E-657E. doi:10.1097/PRS.0000000000007762
- ↑ Rosales RL, Bigalke H, Dressler D. Pharmacology of botuli- num toxin: Differences between type A preparations. Eur J Neurol. 2006;13(Suppl 1):2-10.
- ↑ Килессо В. А. Сальмонелла // Большая медицинская энциклопедия : в 30 т. / гл. ред. Б. В. Петровский. — 3-е изд. — М. : Советская энциклопедия, 1984. — Т. 22 : Растворители — Сахаров. — С. 450—451. — 544 с. : ил.
- ↑ Escherichia coli. Redorbit (15 апреля 2011). Дата обращения: 27 ноября 2013. Архивировано 3 июня 2015 года.
- ↑ Darnton NC, Turner L, Rojevsky S, Berg HC (March 2007). On torque and tumbling in swimming Escherichia coli. Journal of Bacteriology. 189 (5): 1756–64. doi:10.1128/JB.01501-06. PMC 1855780. PMID 17189361.
- ↑ Retail Establishments; Annex 3 - Hazard Analysis. Managing Food Safety: A Manual for the Voluntary Use of HACCP Principles for Operators of Food Service and Retail Establishments. U.S. Department of Health and Human Services Food and Drug Administration Center for Food Safety and Applied Nutrition (April 2006). Дата обращения: 2 декабря 2007. Архивировано 7 июня 2007 года.
- ↑ Stein PE, Boodhoo A, Tyrrell GJ, Brunton JL, Read RJ (February 1992). Crystal structure of the cell-binding B oligomer of verotoxin-1 from E. coli. Nature. 355 (6362): 748–50. Bibcode:1992Natur.355..748S. doi:10.1038/355748a0. PMID 1741063. S2CID 4274763.
- ↑ Kaper JB, Nataro JP, Mobley HL (February 2004). Pathogenic Escherichia coli. Nature Reviews. Microbiology. 2 (2): 123–40. doi:10.1038/nrmicro818. PMID 15040260. S2CID 3343088.
- ↑ Donohue-Rolfe A, Acheson DW, Keusch GT (2010). Shiga toxin: purification, structure, and function. Reviews of Infectious Diseases. 13 Suppl 4 (7): S293-7. doi:10.1016/j.toxicon.2009.11.021. PMID 2047652.
- ↑ Mansan-Almeda, R. Diffusely adherent Escherichia coli strains isolated from children and adults constitute two different population / R. Mansan-Almeda, L.A. Pereira, L.G. Giugliano // BMC Microbiology. — 2013. — Режим доступа: doi:10.1186/1471-2180-13-22.
- ↑ Servin, A.L. Pathogenesis of Afa/Dr diffusely adhering Escherichia coli / A. L. Servin // Clin. Microbiol. Rev. — 2005. — Vol. 18 (2). — P. 264—292
- ↑ Faruque S. M., Albert M. J., Mekalanos J. J. 1998. Epidemiology, genetics, and ecology of toxigenic Vibrio cholerae. Microbiol Mol Biol Rev. 62(4): 1301—1314.
- ↑ Laboratory Methods for the Diagnosis of Vibrio cholerae. Centre for Disease Control. Дата обращения: 29 октября 2013. Архивировано 4 января 2023 года.
- ↑ Amberlyn M Wands; Akiko Fujita (Октябрь 2015). Fucosylation and protein glycosylation create functional receptors for cholera toxin. eLife. doi:10.7554/eLife.09545.
{{cite news}}: Википедия:Обслуживание CS1 (не помеченный открытым DOI) (ссылка) - ↑ Cervin J, Wands AM, Casselbrant A, Wu H, Krishnamurthy S, Cvjetkovic A, et al. (2018) GM1 ganglioside-independent intoxication by Cholera toxin. PLoS Pathog 14(2): e1006862. https://doi.org/10.1371/journal.ppat.1006862
- ↑ Fucosylated Molecules Competitively Interfere with Cholera Toxin Binding to Host Cells; Amberlyn M. Wands, Jakob Cervin, He Huang, Ye Zhang, Gyusaang Youn, Chad A. Brautigam, Maria Matson Dzebo, Per Björklund, Ville Wallenius, Danielle K. Bright, Clay S. Bennett, Pernilla Wittung-Stafshede, Nicole S. Sampson, Ulf Yrlid, and Jennifer J. Kohler; ACS Infectious Diseases Article ASAP, DOI: 10.1021/acsinfecdis.7b00085
- ↑ Sanchez J., Holmgren J. Cholera toxin - a foe & a friend. (англ.) // The Indian journal of medical research. — 2011. — Vol. 133. — P. 153—163. — PMID 21415489.
- ↑ Joaquín Sánchez; Jan Holmgren (Февраль 2011). Cholera toxin – A foe & a friend (PDF). Indian Journal of Medical Research. Vol. 133. p. 158. Архивировано из оригинала (PDF) 3 февраля 2013. Дата обращения: 15 октября 2022.
- ↑ Singleton P. Bacteria in Biology, Biotechnology and Medicine. — 5th. — Wiley, 1999. — P. 444–454. — ISBN 0-471-98880-4.
- ↑ V. V. Mashin, A. N. Sergeev, N. N. Martynova, T. V. Antipina, E. I. Sakanyan, V. V. Kataeva, N. V. Zagidullin. Minimisation of the viral contamination risk of heterologous immunoglobulins in the context of the requirements of the State Pharmacopoeia of the Russian Federation // Biological Products. Prevention, Diagnosis, Treatment. — 2022-06-02. — Т. 22, вып. 2. — С. 112–123. — ISSN 2619-1156. — doi:10.30895/2221-996X-2022-22-2-112-123.
- ↑ Virus Taxonomy: 2021 Release. International Committee on Taxonomy of Viruses (ICTV). Дата обращения: 19 мая 2022. Архивировано 20 марта 2020 года.
- ↑ Suzuki H (August 2019). Rotavirus Replication: Gaps of Knowledge on Virus Entry and Morphogenesis. The Tohoku Journal of Experimental Medicine. 248 (4): 285–296. doi:10.1620/tjem.248.285. PMID 31447474.
- ↑ Butz AM, Fosarelli P, Dick J, Cusack T, Yolken R (1993). Prevalence of rotavirus on high-risk fomites in day-care facilities. Pediatrics. 92 (2): 202–5. doi:10.1542/peds.92.2.202. PMID 8393172. S2CID 20327842.
- ↑ Rao VC, Seidel KM, Goyal SM, Metcalf TG, Melnick JL (1984). Isolation of enteroviruses from water, suspended solids, and sediments from Galveston Bay: survival of poliovirus and rotavirus adsorbed to sediments (PDF). Applied and Environmental Microbiology. 48 (2): 404–9. Bibcode:1984ApEnM..48..404R. doi:10.1128/AEM.48.2.404-409.1984. PMC 241526. PMID 6091548. Архивировано 27 сентября 2011. Дата обращения: 4 августа 2022.
- ↑ Stanley B. Prusiner — Autobiography. NobelPrize.org. Дата обращения: 18 июня 2013. Архивировано 14 июня 2013 года.
- ↑ Prion Diseases. US Centers for Disease Control (26 января 2006). Дата обращения: 28 февраля 2010. Архивировано из оригинала 4 марта 2010 года.
- ↑ Hudler, George W. Magical Mushrooms, Mischievous Molds: The Remarkable Story of the Fungus Kingdom and Its Impact on Human Affairs (англ.). — Princeton University Press, 1998. — ISBN 978-0-691-07016-2.
- ↑ Грачева И.М. Теоретические основы биотехнологии. Биохимические основы синтеза биологически активных веществ. — М.: Элевар, 2003. — С. 379. — 554 с.
- ↑ Geiser D. M., Dorner J. W., Horn B. W., Taylor J. W. The phylogenetics of mycotoxin and sclerotium production in Aspergillus flavus and Aspergillus oryzae (англ.) // Fungal Genetics and Biology : journal. — 2000. — December (vol. 31, no. 3). — P. 169—179. — doi:10.1006/fgbi.2000.1215. — PMID 11273679. Архивировано 26 января 2021 года.
- ↑ Neal, G.E.; Eaton, D.L.; Judah, D.J.; Verma, A. Metabolism and Toxicity of Aflatoxins M1and B1in Human-Derivedin VitroSystems (англ.) // Toxicology and Applied Pharmacology : journal. — 1998. — July (vol. 151, no. 1). — P. 152—158. — doi:10.1006/taap.1998.8440.
- ↑ Martins ML, Martins HM, Bernardo F (2001). Aflatoxins in spices marketed in Portugal. Food Addit. Contam. 18 (4): 315–19. doi:10.1080/02652030120041. PMID 11339266. S2CID 30636872.
- ↑ Galvano F., Ritieni A., Piva G., Pietri A. Mycotoxins in the human food chain. In: Diaz D.E., editor. The Mycotoxin Blue Book. Nottingham University Press; Nottingham, UK: 2005. pp. 187—224.
- ↑ Wogan GN, Hecht SS, Felton JS, Conney AH, Loeb LA. Environmental and chemical carcinogenesis. Seminars in Cancer Biology (2004). 14: 473—486.
- ↑ Ricordy R, Gensabella G, Cacci E, Augusti-Tocco G. Impairment of cell cycle progression of aflatoxin B1 in human cell lines. Mutagenesis (2002). 17: 241—249.
- ↑ Cole R.J., Cox R.H. The trichothecenes.// In: Cole R.J., Cox R.H. Handbook of Toxic Fungal Metabolites. New York, NY Academic Press, 1981. —P. 152—263.
- ↑ American Phytopathological Society. American Phytopathological Society. Дата обращения: 7 мая 2018. Архивировано 7 мая 2018 года.
- ↑ Wannemacher R.W. Jr. Bunner D.L., Neufeld H.A. Toxicity of trichothecenes and other related mycotoxins in laboratory animals. // In: Smith J.E., Henderson R.S., eds. Mycotoxins and Aimal Foods. Boca Raton, Fla: CRC Press, 1991. —Р. 499—552.
- ↑ Aspects of the ecology of fusarium toxins in cereals. // Mycotoxins and Food Safety.. — New York : Kluwer Academic/Plenum Publishers, 2003. — P. 19–27.
- ↑ Ueno Y, Ishii K, Sakai K, Kanaeda S, Tsunoda H (1972). Toxicological approaches to the metabolites of Fusaria. IV. Microbial survey on "bean-hulls poisoning of horses" with the isolation of toxic trichothecenes, neosolaniol and T-2 toxin of Fusarium solani M-1-1. Japanese J. Exp. Med. 42 (3): 187–203. PMID 4538152.
- ↑ Ueno Y, Matsumoto H (October 1975). Inactivation of some thiol-enzymes by trichothecene mycotoxins from Fusarium species. Chemical & Pharmaceutical Bulletin. 23 (10): 2439–42. doi:10.1248/cpb.23.2439. PMID 1212759.
- ↑ Кононенко Г. П., Буркин А. А., Зотова Е. В. и др. Охратоксин А: исследование контаминации зерна // Прикладная биохимия и микробиология. 2000. Т. 36. № 2. С. 209—213.
- ↑ Елинов Н.П. Химическая микробиология. — М.: Высшая школа, 1989. — С. 360—361. — 448 с. — 19 000 экз. — ISBN 5-06-000089-3.
- ↑ Fumonisin B1 Архивировано 11 февраля 2009 года. product specification by Fermentek
- ↑ MeSH Fumonisins
- ↑ Gelderblom, Wentzel C. A.; Marasas, Walter F. O.; Vleggaar, R.; Thiel, Pieter G.; Cawood, M. E. (February 1992). Fumonisins: Isolation, chemical characterization and biological effects. Mycopathologia. 117 (1–2): 11–16. doi:10.1007/BF00497273. PMID 1513367. S2CID 12066786.
- ↑ P Noonim; W Mahakarnchanakul; K F Nielsen; Jens C Frisvad; Robert A Samson; Ulf Thrane (2009). Fumonisin B2 production by Aspergillus niger in Thai coffee beans (PDF). Food Addit Contam Part a Chem Anal Control Expo Risk Assess. 26 (1): 94–100. doi:10.1080/02652030802366090. PMID 19680876. S2CID 21427787. Архивировано (PDF) 9 августа 2022. Дата обращения: 9 августа 2022.
- ↑ H Stockmann-Juvalla; K Savolainen (2008). A review of the toxic effects and mechanisms of action of fumonisin B1. Human & Experimental Toxicology. 27 (11): 799–809. doi:10.1177/0960327108099525. PMID 19244287. S2CID 8722428.
- ↑ Moss MO (2008). Fungi, quality and safety issues in fresh fruits and vegetables. J. Appl. Microbiol. 104 (5): 1239–43. doi:10.1111/j.1365-2672.2007.03705.x. PMID 18217939.
- ↑ Merck Index, 11th Edition, 7002
- 1 2 Лакиза Н.В., Неудачница Л.К. Анализ пищевых продуктов. — 2015. — С. 170. — ISBN 978-5-7996-1568-0. Архивировано 21 мая 2022 года.
- ↑ Keblys M., Bernhoft A., Höfer C.C., Morrison E., Jørgen H., Larsen S., Flåøyen A. (2004). The effects of the Penicillium mycotoxins citrinin, cyclopiazonic acid, ochratoxin A, patulin, penicillic acid, and roquefortine C on in vitro proliferation of porcine lymphocytes. Mycopathologia (158) 317—324.
- ↑ Бартон Д., Оллис У. Д. Общая органическая химия. — М.: Химия, 1986. — С. 317. — 704 с.
- ↑ K. Baumann K. Muenter H. Faulstich. Identification of structural features involved in binding of α-amanitin to a monoclonal antibody (англ.) // Biochemistry : journal. — 1993. — Vol. 32, no. 15. — P. 4043—4050. — doi:10.1021/bi00066a027. — PMID 8471612. Архивировано 24 июля 2020 года.
- ↑ Rajarathnam, S.; Shashirekha, M.N. (2003), MUSHROOMS AND TRUFFLES | Use of Wild Mushrooms, Encyclopedia of Food Sciences and Nutrition (англ.), Elsevier, pp. 4048–4054, doi:10.1016/b0-12-227055-x/00813-0, ISBN 978-0-12-227055-0, Архивировано 10 июля 2024, Дата обращения: 3 июня 2024
- ↑ Wiegand, Timothy J. (2024), Mushrooms, cyclopeptide, Encyclopedia of Toxicology, Elsevier, pp. 549–553, doi:10.1016/b978-0-12-824315-2.01020-4, ISBN 978-0-323-85434-4, Дата обращения: 3 июня 2024
- ↑ Madore, François; Bouchard, Josée (2019), Plasmapheresis in Acute Intoxication and Poisoning, Critical Care Nephrology, Elsevier, pp. 595—600.e3, doi:10.1016/b978-0-323-44942-7.00100-x, ISBN 978-0-323-44942-7, Дата обращения: 3 июня 2024
- ↑ Hall IR. Edible and Poisonous Mushrooms of the World. — Portland, Oregon : Timber Press, 2003. — P. 107. — ISBN 0-88192-586-1.
- ↑ Бартон Д., Оллис У.Д. Общая органическая химия. — М.: Химия, 1986. — С. 317. — 704 с.
- ↑ М. В. Вишневский //Ядовитые грибы России. «Проспект», 2016 // УДК 630.283 // ББК 28.591я2
- ↑ Kretz O., Creppy E.E., Dirheimer G. Characterization of bolesatine, a toxic protein from the mushroom Boletus satanas Lenz and its effects on kidney cells (англ.) // Toxicology : journal. — 1991. — Vol. 66, no. 2. — P. 213—224. — doi:10.1016/0300-483X(91)90220-U. — PMID 1707561.
- ↑ Ennamany R., Bingen A., Creppy E.E., Kretz O., Gut J.P., Dubuisson L., Balabaud C., Sage P.B., Kirn A. Aspirin (R) and heparin prevent hepatic blood stasis and thrombosis induced by the toxic glycoprotein Bolesatine in mice (англ.) // Human & Experimental Toxicology : journal. — 1998. — Vol. 17, no. 11. — P. 620—624. — doi:10.1191/096032798678908017.
- ↑ North, Pamela. Poisonous Plants and Fungi in colour. — Blandford Press & Pharmacological Society of Great Britain, 1967.
- ↑ Brensinsky A, Besl H. (1990). A colour atlas of poisonous fungi. Wolfe Publishing Ltd, London. 295 p.
- ↑ Spoerke DG, Rumack BH (eds). (1994). Handbook of mushroom poisoning: diagnosis and treatment. CRC Press, Boca Raton.
- ↑ Berger KJ, Guss DA. (2005). Mycotoxins revisited: Part I. J Emerg Med 28:53.
- ↑ Описание строчка обыкновенного в интернет-журнале «Декоративный сад». Дата обращения: 22 декабря 2015. Архивировано 23 декабря 2015 года.
- ↑ М.В.Вишневский. Строчки съедобные и ядовитые. Дата обращения: 22 декабря 2015. Архивировано 22 декабря 2015 года.
- 1 2 Andary C., Privat G. Variations of monomethylhydrazine content in Gyromitra esculenta (англ.) // Mycologia : journal. — Taylor & Francis, 1985. — Vol. 77, no. 2. — P. 259—264. — doi:10.2307/3793077. — .
- ↑ Trim Geoffrey M.; et al. (September 1999). Poisoning by Amanita phalloides ("deathcap") mushrooms in the Australian Capital Territory. Medical Journal of Australia. 171 (5): 247–249. doi:10.5694/j.1326-5377.1999.tb123631.x. PMID 10495756. S2CID 39222950. Архивировано 18 февраля 2012. Дата обращения: 22 мая 2007.
- ↑ Атлас лекарственных растений СССР / Гл. ред. Н. В. Цицин. — М.: Медгиз, 1962. — С. 80—82. — 702 с.
- ↑ Алтухов Н.М., Афанасьев В.И., Башкиров Б.А. Краткий справочник ветеринарного врача. — М.: Агропромиздат, 1990. — 574 с. — 200 000 экз. — ISBN 5-10-001366-4.
- ↑ Manfred Hesse. Alkaloids. Nature’s Curse or Blessing. — Wiley-VCH, 2002. — p. 4.
- ↑ Sharma, R. K., Consice textbook of forensic medicine & toxicology, Elsevier, 2008
- ↑ Ambrosy AP, Butler J, Ahmed A, Vaduganathan M, van Veldhuisen DJ, Colucci WS, Gheorghiade M (May 2014). The use of digoxin in patients with worsening chronic heart failure: reconsidering an old drug to reduce hospital admissions. Journal of the American College of Cardiology. 63 (18): 1823–1832. doi:10.1016/j.jacc.2014.01.051. PMID 24613328.
- ↑ http://toxnet.nlm.nih.gov/cgi-bin/sis/search/a?dbs+hsdb:@term+@DOCNO+3559 Архивная копия от 14 июля 2019 на Wayback Machine «For 100 grams of moistened seed; the peach pit contains approximately 88 mg of hydrocyanic acid, cultivated apricot pit 8.9 mg, wild apricot pit 217 mg. The ingestion of 500 mg of amygdalin may release as much as 30 mg of cyanide.»
- ↑ Chan, Charles KF; Ransom, Ryan C; Longaker, Michael T. Lectins bring benefits to bones (англ.) // eLife : journal. — 2016. — 13 December (vol. 5). — doi:10.7554/eLife.22926. — PMID 27960074. — PMC 5154756.
- ↑ Dasuri K., Ebenezer P. J., Uranga R. M., Gavilán E., Zhang L., Fernandez-Kim S. O. K., Bruce-Keller A. J., Keller J. N. Amino acid analog toxicity in primary rat neuronal and astrocyte cultures: implications for protein misfolding and TDP-43 regulation // Journal of Neuroscience Research. — 2011. — Vol. 89, № 9. — P. 1471—1477. — doi:10.1002/jnr.22677. — PMID 21608013. — PMC 3175609.
- ↑ Rubenstein E.; H. Zhou; K.M. Krasinska; A. Chien; C.H. Becker. (2006). Azetidine-2-carboxylic Acid in Garden Beets. Phytochemistry. 67 (9): 898–903. doi:10.1016/j.phytochem.2006.01.028. PMID 16516254.
- ↑ Seigler, David S. Plant secondary metabolism. — Kluwer Academic, 1998. — P. 222. — ISBN 0-412-01981-7.
- ↑ Association of acute toxic encephalopathy with litchi consumption in an outbreak in Muzaffarpur, India, 2014: a case-control study
- ↑ Нельсон Д., Кокс М. Основы биохимии Ленинджера. — М.: БИНОМ, 2011. — Т. II.
- ↑ Montanaro, A; Bardana Jr, E. J. (1991). Dietary amino acid-induced systemic lupus erythematosus. Rheumatic Diseases Clinics of North America. 17 (2): 323–32. doi:10.1016/S0889-857X(21)00573-1. PMID 1862241.
- ↑ Bygbjerg, I.C.; Johansen, H.K. (1991). Manchineel poisoning complicated by streptococcal pharyngitis and impetigo. Ugeskr. Laeger. 154 (1): 27–28. PMID 1781062.
- ↑ Lewis R. J. Sax's Dangerous Properties of Industrial Materials. — 12 ed. — Wiley, 2012. — Vol. 1—5. — P. 2861.
- ↑ Oxford, 2014, p. 214.
- ↑ Suehiro, M (1994). [Historical review on chemical and medical studies of globefish toxin before World War II]. Yakushigaku Zasshi. 29 (3): 428–34. PMID 11613509.
- ↑ Леонид Завальский. Нейротоксины: яды или противоядия? ОАО «Известия». Дата обращения: 27 января 2009. Архивировано 3 февраля 2009 года.
- 1 2 3 4 5 6 Холстед Брюс. Опасные морские животные. — Ленинград: Гидрометеоиздат, 1970. — 160 с. — 93 000 экз.
- ↑ Fusetani, Nobuhiro. Marine Toxins as Research Tools : [англ.] / Nobuhiro Fusetani, William Kem. — Springer Science & Business Media, 2009-01-31. — ISBN 978-3-540-87895-7.
- ↑ Swift AE, Swift TR (2008). Ciguatera. Journal of Toxicology. Clinical Toxicology. 31 (1): 1–29. doi:10.3109/15563659309000371. PMID 8433404.
- ↑ Clark RF, Williams SR, Nordt SP, Manoguerra AS (1999). A review of selected seafood poisonings. Undersea Hyperb Med. 26 (3): 175–84. PMID 10485519. Архивировано из оригинала 11 августа 2011. Дата обращения: 12 августа 2008.
- ↑ Rigoulet J., Hennache A., Lagourette P., George C., Longeart L., Le Net J. L., Dubey J. P. Toxoplasmosis in a bar-shouldered dove (Geopelia humeralis) from the Zoo of Clères, France (англ.) // Parasite : journal. — 2014. — Vol. 21. — P. 62. — doi:10.1051/parasite/2014062. — PMID 25407506. — PMC 4236686.

- ↑ Fayer, R., and J.P. Dubey. 1985. Methods for controlling transmission of protozoan parasites from meat to man. Food Technol. 39(3):57-60.
- 1 2 Rawat, Aadish; Singh, Parikshit; Jyoti, Anupam; Kaushik, Sanket; Srivastava, Vijay Kumar (30 апреля 2020). Averting transmission: A pivotal target to manage amoebiasis. Chemical Biology & Drug Design. 96 (2): 731–744. doi:10.1111/cbdd.13699. ISSN 1747-0285. PMID 32356312. S2CID 218475533.
- ↑ Marquardt, W.C., and R.S. Demaree. 1985. Parasitology. New York: Macmillan.
- ↑ Barnard, R.J., and G.J. Jackson. 1984. Giardia lamblia: The transfer of human infections by foods. In Giardia and Giardiasis: Biology, Pathogenesis, and Epidemiology, ed. S.L. Erlandsen and E.A. Meyer, 365—378. New York: Plenum.
- 1 2 Farrar, Jeremy. Manson's Tropical Diseases / Jeremy Farrar, Peter Hotez, Thomas Junghanss … [и др.]. — Elsevier Health Sciences, 2013-10-26. — P. 664–671. — ISBN 9780702053061. Архивная копия от 27 августа 2021 на Wayback Machine
- ↑ Polynuclear Aromatic Hydrocarbons. In: Guidelines for Drinking-water Quality, 2nd ed. Vol. 2. Health Criteria and other Supporting Information Архивная копия от 27 января 2017 на Wayback Machine. Geneva, World Health Organization, pp. 123—152.: (page 11) «For ambient air, residential heating and vehicle traffic appear to be the main sources of exposure. In the direct vicinity of an emission source, a maximum intake of 1 µg of BaP per day may be reached (WHO, 1987; LAI, 1992).»
- ↑ Polynuclear Aromatic Hydrocarbons. In: Guidelines for Drinking-water Quality, 2nd ed. Vol. 2. Health Criteria and other Supporting Information Архивная копия от 27 января 2017 на Wayback Machine: «The main contributors of PAHs to the total dietary intake appear to be cereals, oils, and fats. The oil and fat group has high individual PAH levels, whereas the cereal group, although never containing high individual PAH concentrations, is a main contributor by weight to total intake in the diet. Smoked meat and fish products, although containing the highest PAH levels, appear to be low to modest contributors, as they are minor components of the usual diet»
- ↑ Hazard Information Bulletin — Dimethylmercury Архивная копия от 8 апреля 2005 на Wayback Machine. OSHA Safety and Health Information Bulletins (SHIBs), 1997—1998
- 1 2 Вредные вещества в промышленности. Справочник для химиков, инженеров и врачей. Изд. 7-е, пер. и доп. В трех томах. Том I. Органические вещества. Под ред. засл. деят. науки проф. Н. В. Лазарева и докт. мед. наук Э. Н. Левиной. Л., «Химия», 1976. 592 стр., 27 табл., библиография —1850 названий.
- 1 2 Kasper, Dennis L.et al. (2004) Harrison’s Principles of Internal Medicine, 16th ed., McGraw-Hill Professional, p. 618, ISBN 0071402357.
- ↑ Smith, Martyn T. Advances in understanding benzene health effects and susceptibility (англ.) // Ann Rev Pub Health : journal. — 2010. — Vol. 31. — P. 133–48. — doi:10.1146/annurev.publhealth.012809.103646.
- ↑ Vale A. Methanol (неопр.) // Medicine. — 2007. — Т. 35, № 12. — С. 633–4. — doi:10.1016/j.mpmed.2007.09.014.
- ↑ http://www.epa.gov/chemfact/s_methan.txt Архивная копия от 13 апреля 2015 на Wayback Machine «Humans — Ingestion of 80 to 150 mL of methanol is usually fatal to humans (HSDB 1994).»
- ↑ Светлана Евгеньевна Траубенберг, А.А. Кочеткова; Нечаев, Алексей Петрович. Пищевая химия. — Санкт-Петербург: ГИОРД, 2003. — С. 516. — 630 с. — 3000 экз. — ISBN 5-901065-38-0.
- ↑ Polychlorinated dibenzo-para-dioxins and polychlorinated dibenzofurans (англ.). — Lyon: IARC, 1997. — (IARC Monographs on the Evaluation of Carcinogenic Risks to Humans. Volume 69). — ISBN 92-832-1269-X. Архивировано 21 июня 2018 года.
- ↑ Duffus, 2002, pp. 794–795; 800.
- ↑ Duffus, 2002, p. 798.
- ↑ Beryllium and Beryllium Compounds // IARC Monograph. — International Agency for Research on Cancer, 1993. — Vol. 58.
- ↑ Книжников B. А.; Бережной Р. В., Рубцов А. Ф. (суд.), Григорян Э. А. (рент.), Марченко Е. Н. (отравления органическими соединениями свинца), Самойлов Д. Н. (фарм.), Соркина Н. С. (отравления неорганическими соединениями свинца), Цивильно М. А. (психиат.). Свинец // Большая медицинская энциклопедия : в 30 т. / гл. ред. Б. В. Петровский. — 3-е изд. — М. : Советская энциклопедия, 1984. — Т. 23 : Сахароза — Сосудистый тонус. — С. 21—25. — 544 с. : ил.
- ↑ TETRAETHYL LEAD - National Library of Medicine HSDB Database. Дата обращения: 13 августа 2022. Архивировано 28 апреля 2019 года.
- ↑ Светлана Евгеньевна Траубенберг, А.А. Кочеткова; Нечаев, Алексей Петрович. Пищевая химия. — 6-е. — Санкт-Петербург: ГИОРД, 2015. — С. 537. — 640 с. — 3000 экз. — ISBN 5-901065-38-0.
- ↑ The mercury levels in the table, unless otherwise indicated, are taken from: Mercury Levels in Commercial Fish and Shellfish (1990—2010) Архивировано 3 мая 2015 года. U.S. Food and Drug Administration. Accessed 8 January 2012.
- ↑ Первый искусственный подсластитель был на основе свинца и убивал древних римлян. Фактрум. Дата обращения: 31 октября 2015. Архивировано 3 декабря 2015 года.
- ↑ Cecil, KM; Brubaker, CJ; Adler, CM; Dietrich, KN; Altaye, M; Egelhoff, JC; Wessel, S; Elangovan, I; Hornung, R. Decreased Brain Volume in Adults with Childhood Lead Exposure (англ.) // PLOS Medicine : journal / Balmes, John. — 2008. — Vol. 5, no. 5. — P. e112. — doi:10.1371/journal.pmed.0050112. — PMID 18507499. — PMC 2689675.
- ↑ University, Stanford (24 сентября 2019). Lead found in turmeric. Stanford News (англ.). Архивировано 25 сентября 2019. Дата обращения: 25 сентября 2019.
- ↑ Xu, Liang, Zhang, Fei, Tang, Mingjia, et al. Melatonin confers cadmium tolerance by modulating critical heavy metal chelators and transporters in radish plants. Journal of Pineal Research: Molecular, Biological, Physiological and Clinical Aspects of Melatonin. 2020;69(1): doi:10.1111/jpi.12659.
- ↑ Luevano, J; Damodaran, C (2014). A Review of Molecular Events of Cadmium-Induced Carcinogenesis. Journal of Environmental Pathology, Toxicology and Oncology. 33 (3): 183–194. doi:10.1615/jenvironpatholtoxicoloncol.2014011075. PMC 4183964. PMID 25272057.
- ↑ Rahim, F; Jalali, A; Tangestani, R (2013). Breast cancer frequency and exposure to cadmium: A meta-analysis and systematic review (PDF). Asian Pacific Journal of Cancer Prevention. 14 (7): 4283–7. doi:10.7314/apjcp.2013.14.7.4283. PMID 23991990. Архивировано (PDF) 12 февраля 2018. Дата обращения: 30 июля 2022.
- ↑ Tellez-Plaza, M; Jones, M. R.; Dominguez-Lucas, A; Guallar, E; Navas-Acien, A (2013). Cadmium Exposure and Clinical Cardiovascular Disease: A Systematic Review. Current Atherosclerosis Reports. 15 (10): 10.1007/s11883–013–0356–2. doi:10.1007/s11883-013-0356-2. PMC 3858820. PMID 23955722.
- ↑ James, K. A.; Meliker, J. R. (2013). Environmental cadmium exposure and osteoporosis: A review. International Journal of Public Health. 58 (5): 737–45. doi:10.1007/s00038-013-0488-8. PMID 23877535. S2CID 11265947.
- ↑ Скальный А.В., Рудаков И.А. Биоэлементы в медицине. — Москва: Издательский дом «ОНИКС 21 век», «Мир», 2004. — С. 184—185. — 272 с. — 7000 экз. — ISBN 5-03-003645-8.
- ↑ Anke M. Arsenic. In: Mertz W. ed., Trace elements in human and Animal Nutrition, 5th ed. Orlando, FL: Academic Press, 1986, 347—372
- ↑ Uthus, Eric O. (1992). Evidence for arsenic essentiality. Environmental Geochemistry and Health. 14 (2): 55–58. doi:10.1007/BF01783629. PMID 24197927. S2CID 22882255.
- ↑ Uthus E.O., Arsenic essentiality and factors affecting its importance. In: Chappell W.R, Abernathy C.O, Cothern C.R. eds., Arsenic Exposure and Health. Northwood, UK: Science and Technology Letters, 1994, 199—208.
- ↑ Datta, Rupali; Dibyendu, Sarkar. Biogeochemistry of Arsenic in Contaminated Soils of Superfund Sites. EPA. United States Environmental Protection Agency (2007). Дата обращения: 25 февраля 2018. Архивировано 26 февраля 2018 года.
- 1 2 3 4 Позин М.Е. Технология минеральных солей. — 3. — Ленинград: Химия, 1970. — С. 420. — 792 с.
- ↑ The Merck Index, 7th edition, Merck & Co., Rahway, New Jersey, 1960.
- ↑ Patnaik, Pradyot. Handbook of inorganic chemicals. — McGraw-Hill, 2003. — P. 77–78. — ISBN 978-0-07-049439-8.
- ↑ Скальный А.В., Рудаков И.А. Биоэлементы в медицине. — Москва: Издательский дом «ОНИКС 21 век», «Мир», 2004. — С. 190. — 272. с.
- ↑ Epley, R. J., Addis, P. B., & Warthesen, J. J., Nitrite in Meat Архивная копия от 17 августа 2017 на Wayback Machine // conservancy.umn.edu, 1992 «The fatal dose of sodium nitrite is in the range of 22 to 23 milligrams per kilogram of body weight»
- ↑ Ogbede, J.U., Giaever, G. & Nislow, C. A genome-wide portrait of pervasive drug contaminants. Sci Rep 11, 12487 (2021). https://doi.org/10.1038/s41598-021-91792-1 Архивная копия от 4 декабря 2021 на Wayback Machine
- ↑ Dela Cruz, Maricel; Glick, Joshua; Merker, Seth H.; Vearrier, David (11 мая 2018). Survival after severe methemoglobinemia secondary to sodium nitrate ingestion. Toxicology Communications. 2: 21–23. doi:10.1080/24734306.2018.1467532.
- ↑ Список 12 изначальных соединений. Дата обращения: 7 февраля 2021. Архивировано 24 октября 2016 года.
- ↑ International Notes Acute Convulsions Associated with Endrin Poisoning -- Pakistan. Morbidity and Mortality Weekly Report (MMWR). Center for Disease Control (14 декабря 1984). Дата обращения: март 2015. Архивировано 4 марта 2016 года.
- ↑ 1990 год — загрязнение питьевой воды г. Уфы фенолом Архивировано 15 января 2005 года.
- ↑ Светлана Евгеньевна Траубенберг, А.А. Кочеткова; Нечаев, Алексей Петрович. Пищевая химия. — 6-е. — Санкт-Петербург: ГИОРД, 2015. — С. 546. — 640 с. — 3000 экз. — ISBN 5-901065-38-0.
- ↑ Aygün SF, Kabadayi F. Determination of benzo[a]pyrene in charcoal grilled meat samples by HPLC with fluorescence detection. International Journal of Food Sciences and Nutrition. 2005 Dec;56(8):581-5. PMID 16638662
- ↑ Polynuclear Aromatic Hydrocarbons. In: Guidelines for Drinking-water Quality, 2nd ed. Vol. 2. Health Criteria and other Supporting Information Архивная копия от 27 января 2017 на Wayback Machine: There are a few studies on daily intake of individual PAHs from food from western Europe… The maximum/median intake levels for the PAHs selected in this guideline, in µg/day per person, have been estimated to be as follows: … BaP (0.36/0.05);. (Pfannhauser, 1991).
- ↑ Кудряшов Ю.Б. Радиационная биофизика. — Москва: Физматлит, 2004. — С. 136.
- ↑ Роева Н.Н. Безопасность продовольственных продуктов. — М.: МГУТУ, 2009.
- ↑ Bernstein, JA; Cremonesi, P; Hoffmann, TK; Hollingsworth, J. Angioedema in the emergency department: a practical guide to differential diagnosis and management (англ.) // International Journal of Emergency Medicine : journal. — 2017. — December (vol. 10, no. 1). — P. 15. — doi:10.1186/s12245-017-0141-z. — PMID 28405953. — PMC 5389952.
- ↑ Agrios, George N. Plant Pathology: Fifth Edition. — Elsevier Academic Press, 2005. — P. 922. — ISBN 0-12-044565-4.
- ↑ Светлана Евгеньевна Траубенберг, А.А. Кочеткова; Нечаев, Алексей Петрович. Пищевая химия. — 2. — Санкт-Петербург: ГИОРД, 2003. — С. 526. — 640 с. — 3000 экз. — ISBN 5-901065-38-0.
- ↑ Paul M Dewick. Medicinal Natural Products. A Biosynthetic Approach. Second Edition. — Wiley, 2002. — С. 370—372. — 515 с. — ISBN 0471496405.
- ↑ Орехов А. П. Химия алкалоидов. — Изд.2. — М.: АН СССР, 1955. — С. 627. — 859 с.
- ↑ Cristina J., Costa-Mattioli M. Genetic variability and molecular evolution of hepatitis A virus (англ.) // Virus Res. : journal. — 2007. — August (vol. 127, no. 2). — P. 151—157. — doi:10.1016/j.virusres.2007.01.005. — PMID 17328982.
- ↑ Коротяев А. И., Бабичев С. А. Медицинская микробиология, иммунология и вирусология. — СПб.: СпецЛит, 2010. — С. 1062—1064. — 1992 с. — ISBN 978-5-299-00425-0.
- ↑ Минздрав Канады (Health Canada). Справочник по употреблению в пищу рыбы для женщин, детей и семей. Архивировано из оригинала 30 января 2016 года.
- ↑ Advances in Agronomy. — Academic Press, 2013. — С. 159—. — ISBN 978-0-12-407798-0.
- ↑ Immunodeficiency disorders: MedlinePlus Medical Encyclopedia (англ.). medlineplus.gov. Дата обращения: 6 мая 2017. Архивировано 1 мая 2017 года.
- ↑ NCI Dictionary of Cancer Terms (англ.). National Cancer Institute. Дата обращения: 6 мая 2017. Архивировано 5 мая 2017 года.
- ↑ Cunha-Oliveira T., Rego A. C., Oliveira C. R. Cellular and molecular mechanisms involved in the neurotoxicity of opioid and psychostimulant drugs (англ.) // Brain Research Reviews : journal. — 2008. — June (vol. 58, no. 1). — P. 192—208. — doi:10.1016/j.brainresrev.2008.03.002. — PMID 18440072. Архивировано 28 августа 2021 года.. — «The Interagency Committee on Neurotoxicology defined neurotoxicity as a broad concept, including any adverse effect on the structure or function of the central and/or peripheral nervous system by a biological, chemical or physical agent. In this definition, neurotoxic effects may be permanent or reversible and result from direct or indirect actions on the nervous system (Erinoff, 1995).».
- ↑ География раковых заболеваний — Популярные статьи — Онкология — Энциклопедия — MedPortal.ru. Дата обращения: 22 апреля 2020. Архивировано 18 июня 2020 года.
- ↑ Goldblith, S. A. 1963. Radiation preservation of foods — Two decades of research and development. In Ra-diationResearch,155-167.Washington,DC:U.S.DepartmentofCommerce,OfficeofTechnicalServices.
- ↑ A D Warth. Mechanism of action of benzoic acid on Zygosaccharomyces bailii: effects on glycolytic metabolite levels, energy production, and intracellular pH (англ.) // Appl Environ Microbiol : journal. — 1991. — 1 December (vol. 57, no. 12). — P. 3410—3414. — PMID 1785916. — PMC 183988. Архивировано 22 декабря 2007 года.
- ↑ Nordic Food Additive Database Архивная копия от 2 мая 2008 на Wayback Machine Nordic Working Group on Food Toxicology and Risk Assessment.
- ↑ Светлана Евгеньевна Траубенберг, А.А. Кочеткова; Нечаев, Алексей Петрович. Пищевая химия. — 2-е. — Санкт-Петербург: ГИОРД, 2003. — С. 440—441. — 640 с. — 3000 экз. — ISBN 5-901065-38-0.
- ↑ Светлана Евгеньевна Траубенберг, А.А. Кочеткова; Нечаев, Алексей Петрович. Пищевая химия. — 2-е. — Санкт-Петербург: ГИОРД, 2003. — С. 442. — 640 с. — 3000 экз. — ISBN 5-901065-38-0.
- ↑ Швецов А. Б., Козырева А. В., Седунов С. Г., Тараскин К. А. Хлорные дезинфектанты и их применение в современной водоподготовке // Молекулярные технологии. — 2009. — № 3. — С. 98—121.
- ↑ Biological Safety: Principles and Practices / Edited by Fleming D. O., Hunt D. L.. — Third edition. — Washington: ASM Press, 200o. — P. 269. — ISBN 1-55581-180-9.
- ↑ Система управления безопасностью пищевых продуктов — In.Business World. Дата обращения: 6 октября 2017. Архивировано 27 марта 2017 года.
- ↑ ТР ТС 021/2011, глава 3
- ↑ Штрафы за отсутствие ХАССП. Дата обращения: 29 января 2019. Архивировано 29 января 2019 года.
Литература
- The Oxford Companion to Food / Alan Davidson, Tom Jaine. — Oxford University Press, 2014. — ISBN 978-0-19-104072-6.
- Duffus J. H. " 'Heavy metals'—A meaningless term?" (англ.) // Pure and Applied Chemistry. — 2002. — Vol. 74, no. 5. — P. 793—807. — doi:10.1351/pac200274050793.